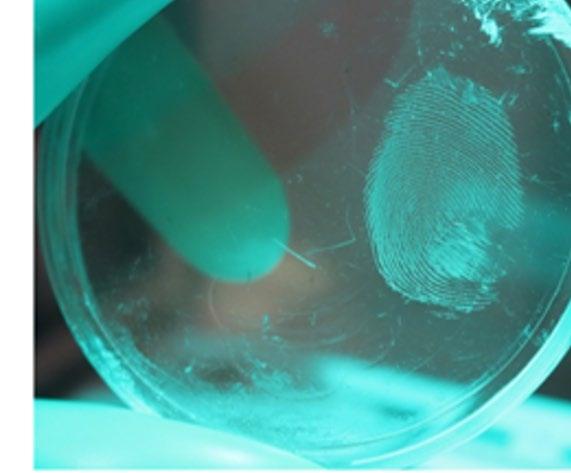

Funded by the European Union



Funded by the European Union



© May 2024, United Nations Interregional Crime and Justice Research Institute (UNICRI)
Tel: + 39 011-6537 111 / Fax: + 39 011-6313 368
Website: www.unicri.org
E-mail: unicri.publicinfo@un.org
The opinions, findings, conclusions and recommendations expressed herein are those of the authors and do not necessarily reflect the views and positions of the United Nations (UN) Secretariat and the UN Interregional Crime and Justice Research Institute (UNICRI), or any other national, regional or international entity involved.
The contents of this document are strictly confidential and must not be reproduced without the express permission of UNICRI.
The designations employed and the presentation of the materials in this publication, including their respective citations, maps and bibliography, do not imply the expression of any opinion whatsoever on the part of the Secretariat of the United Nations and UNICRI concerning the legal status of any country, territory, city or area or of its authority or concerning the delimitation of its frontiers or boundaries.
Also, the boundaries and names shown and the designations used in this publication do not imply official endorsement or acceptance by the United Nations Secretariat or UNICRI. Specific references to Member States do not imply any kind of endorsement on the part of UNICRI or of the UN Secretariat. Any information that may be contained in this publication emanating from actions and decisions taken by States does not imply recognition by UNICRI or the UN Secretariat of the validity of the actions and decisions in question and is included without prejudice to the position of any Member State of the United Nations. Similarly, the mention of specific institutions or companies or of certain manufacturers’ products does not imply that they are endorsed or recommended by the Secretariat of the UN or UNICRI in preference to others of a similar nature that are not mentioned.
UNICRI does not accept any liability, including claims, demands, suits, judgments, damages or losses, including any costs, expenses or legal fees that may occur against UNICRI or related partners resulting from the use of this document by any party.
This publication was funded by the European Union. Its contents are the sole responsibility of UNICRI and do not necessarily reflect the views of the European Union.
UNICRI would like to acknowledge the individuals and organisations that have contributed to the development, design, and delivery of this Guide.
The development expert team included:
• Mr. Talgat Toleubayev, Regional Coordinator, UNICRI
• Mr. Mitchell Stern, Consultant, UNICRI
• Mr. Simon Minks, Consultant, UNICRI
• Mr. Guy Collyer, Consultant, UNICRI
• Mr. Klaus Mayer, Head of Unit, Joint Research Centre, European Commission
• Ms. Maria Wallenius, Scientific Project Officer, Joint Research Centre, European Commission
• Ms. Eva Szeles, Unit Head, Crime Scene Management and Nuclear Forensic Science, IAEA
• Mr. Gary Eppich, Nuclear Security Officer, IAEA
• Mr. Frank Wong, Senior Scientist, IAEA
• Ms. Maria Lorenzo Sobrado, Head of CBRN Terrorism Prevention Programme, UNODC
• Ms. Shenaz Muzaffer, General Counsel, International Association of Prosecutors
• Mr. Benjamin Garrett, Expert, On-Site Technical Assistance to the EU CBRN Centres of Excellence - P94, AESA
• Ms. Jovana Nikolov, Expert, On-Site Technical Assistance to the EU CBRN Centres of Excellence - P94, AESA
• Ms. Elena Dinu, Expert, On-Site Technical Assistance to the EU CBRN Centres of Excellence - P94, AESA
• Mr. Marian Kolencik, Expert, On-Site Technical Assistance to the EU CBRN Centres of Excellence - P94, AESA
• Mr. Günter Povoden, Expert, On-Site Technical Assistance to the EU CBRN Centres of Excellence - P94, AESA
• Mr. Andrei Apostol, Expert, On-Site Technical Assistance to the EU CBRN Centres of Excellence - P94, AESA
• Ms. Elena Paladi, Team Leader, EU CBRN Centres of Excellence
• Ms. Maia Silagadze, Expert, On-Site Technical Assistance to the EU CBRN Centres of Excellence - P94, AESA
• Mr. Dumitru Obada, Expert, On-Site Technical Assistance to the EU CBRN Centres of Excellence - P94, AESA
• Mr. David Cora, Trial Attorney, U.S. Department of Justice
• Mr. Joseph Kaster, Trial Attorney, U.S. Department of Justice
• Ms. Linda Tashbook, Adjunct Professor of Law, University of Pittsburgh School of Law
• Mr. William J. Petoskey, Senior Instructor, Northfield Global
Under the overall guidance of:
• Mr. Francesco Marelli, Head of Unit, CBRN Risk Mitigation and Security Governance, UNICRI
• Ms. Marian De Bruijn, Programme Management Officer, UNICRI
• Mr. Sorin Popa, Programme Manager, Foreign Policy Instruments Service, European Commission
• Ms. Silvia Bottone, Programme Manager, Foreign Policy Instruments Service, European Commission
With the regional support of:
• Ms. Mari Lursmanashvili, Head of Regional Secretariat, South East and Eastern Europe (SEEE) region, EU CBRN Centres of Excellence Initiative
• Mr. Jumber Mamasakhlisi, Expert, On-Site Technical Assistance to the EU CBRN Centres of Excellence - P94, AESA
With the support in the editing and graphic design:
• UNICRI’s Public Information Unit
9.1
European Union Agency for Law Enforcement
(ITWG)
Nations Office on Drugs and Crime (UNODC), Terrorism Prevention Branch (TPB), Chemical, Biological, Radiological and Nuclear (CBRN) Terrorism Prevention Programme
A Prosecutor’s Guide to Radiological and Nuclear Crimes is the second manual issued by the United Nations Interregional Crime and Justice Research Institute (UNICRI) with funding received from the European Commission within the framework of the European Union’s (EU) Chemical, Biological, Radiological and Nuclear (CBRN) Risk Mitigation Centres of Excellence (CoE) Initiative.
This publication continues UNICRI’s series entitled 'From Crime Scene to Courtroom', which commenced with the preliminary publication of A Prosecutor’s Guide to Chemical and Biological Crimes in 2022, available in 6 different languages.
A Prosecutor’s Guide to Radiological and Nuclear Crimes was developed by the UNICRI in close coordination with the International Atomic Energy Agency (IAEA), the Nuclear Forensic Laboratory of the Joint Research Centre (JRC - European Commission), the United Nations Office on Drugs and Crime (UNODC), the International Association of Prosecutors (IAP), and other international partners and relevant subject matter experts from the EU CBRN CoE Initiative. Introduction
The guide aims to assist prosecutors, investigators and relevant law enforcement and judicial authorities in the successful investigation, prosecution and adjudication of incidents involving the deliberate acquisition, stockpiling, production, transfer, use or misuse of radiological and nuclear (RN) materials. While government authorities can intervene at any moment, this guide is intended to help them preserve their prosecutive options. It also highlights the importance of proper handling, transportation, storage, and disposal – especially challenging when nuclear and other radioactive (RN) materials are involved – to ensure evidence admissibility at trial.
This Guide places special emphasis on human rights considerations, underscoring that prosecution authorities must uphold the rule of law even during high-pressure investigations and prosecutions. Prosecutors bear a significant responsibility to citizens, involving the enforcement of laws and the prosecution of offences. They are duty-bound by the rule of law to respect and protect human rights at every stage. These obligations are enshrined and proclaimed in the Universal Declaration of Human Rights. International organisations have promulgated recognised standards for prosecutors. This Guide extensively covers these standards to further assist prosecutors in protecting and upholding human rights.
Many words and terms included here will be new to readers just entering the world of nuclear and other radioactive materials. Contributors have endeavoured to define them as they appear, but readers interested in learning more are directed to consult The 2022 (Interim) Edition of the IAEA Nuclear Safety and Security Glossary (IAEA 2022); and Goulart De Medeiros, M., Lequarre, A., Geypens, B., Santopolo, D., Daoust-Maleval, I., Brzozowski, K. and Iatan, A., EU CBRN Glossary, Publications Office of the European Union, Luxembourg, 2022, JRC128863.
Organised crime groups, terrorists and non-state actors seek maximum visibility for their raison d'être and intend to cause extreme levels of panic among the population. They are known to be attracted to RN materials to achieve these goals. Radioactive and nuclear materials can facilitate many schemes, ranging from targeted exposure operations causing radiation sickness in one or more victims to the creation of devices designed to kill or cause serious injury. Ultimately, these activities can induce fear, panic and mass disruption.
Despite the multitude of stringent regulatory control regimes enforced by States, the access to RN materials for malicious purposes remains a significant risk. This persistent threat is due to the widespread presence of RN materials in society and is exacerbated by negative factors such as the growing nexus between crime and terrorism, regional instabilities, uncontrolled territories, and the abundance of materials rooted in some States’ historical heritage. Ongoing regional conflicts and wars have revived old terminologies such as 'nuclear blackmail’, which had faded from public awareness for a period.
Once RN material is illegally taken from regulatory control and transported to its final destination to be used for malicious purposes, it becomes subject to interdiction. Nowadays, countries invest millions of dollars to enhance their national security capabilities by purchasing costly chemical, biological, radiological and nuclear (CBRN) detection and forensics equipment. States spend huge amounts of their taxpayers’ money on building and maintaining robust national security
architectures with the goal of frustrating any such illegal scheme. That said, traffickers may still be successful in illegally crossing national frontiers undetected.
This Guide exists to support state authorities in prevention-oriented investigations and lawful prosecutions of those who would attempt such schemes. As these crimes have a low probability of occurring (while presenting a potentially high impact), an individual prosecutor’s next RN case may be their first. This Guide is specifically designed to support every step of the investigation and prosecution process. Prosecutors need to build a very strong case in court to convince judicial authorities of the deliberate nature of such a crime, and this requires impeccable evidence. These cases are complex and rare, and therefore the Guide is designed to support a prosecutor facing relevant challenges, even as it may take many years to progress from the crime scene to adjudication in court.
Ultimately, criminals and terrorists will be defended by competent counsel. State authorities can expect to be questioned about each step. Forensics experts, investigators, field technicians and scientists can anticipate scrutiny of every action and every conclusion. Any perceived or actual gap could jeopardise the case, leading to the acquittal of otherwise guilty perpetrators. This Guide is designed to be a comprehensive resource for prosecutors to achieve predictable and successful outcomes in cases involving radiological and nuclear crimes.
A Prosecutor’s Guide to Radiological and Nuclear Crimes includes practical tips, lessons learned, and best practices derived from real criminal case examples, serving as useful precedents. Step-by-step recommendations for the successful investigation and prosecution of RN crimes are integral parts of the Guide.
A comprehensive capacity-building and training package was developed by UNICRI to integrate the provisions of the Guide into the available training catalogue. Components of the training package include tabletop exercises, modules such as 'Building a Case for the Prosecution of CBRN crimes', CBRN Criminalisation workshop, Mock Trials and Train-The-Trainer evolutions.
The training package enables participants to learn about the entire process of investigating a case, starting from the crime scene contaminated with CBRN materials to the eventual prosecution and adjudication of the crime in the courtroom. While the training is primarily intended for prosecutors, it is also available to judicial and investigative professionals due to the crosscutting nature of prosecutorial work. This includes relevant law enforcement authorities, who often lead the investigation from the crime scene to the courtroom.
The long-term goal of this initiative is to integrate both this Guide and the relevant training package into the curricula of national training institutions and academies for prosecutors and law enforcement agencies. Training institutions will be solicited for their involvement in this initiative from the outset. Courses have been designed to be easily conducted at the regional or national level to meet the requirements of the involved entities and promote the exchange of good practices and expertise. Ultimately, this initiative aims to stimulate dialogue and cooperation, significantly enhancing the safety and security of the global family of nations.

CHAPTER ONE

Characteristics of Nuclear and Other Radioactive Materials
References 1.1 1.2 1.3 1.4 1.5 1.6 1.7
Health and Safety
Dual-Use Items, Industries and Emerging Technologies
Methods of Offending
Lifecycle of Crimes Involving Nuclear and Other Radioactive Materials
Categories of Crimes Involving Nuclear and Other Radioactive Materials
Case Examples

This chapter aims to provide a basic overview of the unique characteristics and behaviours associated with nuclear and other radioactive materials and the factors that may influence the investigation and prosecution of crimes involving such materials.
Radioactive materials may be of natural origin or may result from technical processes, such as fission or the capturing of neutrons. A chemical element may exist in the form of different isotopes. These isotopes have the same number of protons, which means that the chemical element is the same with the same chemical characteristics, but the mass of the atoms is different as the number of neutrons varies. Natural, abundant, non-radioactive caesium (133Cs), for example, has the same chemical characteristics as its radioactive form (137Cs). For example, as the salt caesium chloride, both forms can easily dissolve in water or acid and will react identically in chemical reactions.
Some of the natural isotopes of chemical elements are radioactive, such as potassium-40 (40K). Radioactive elements are not stable and disintegrate over time while emitting radiation, producing different chemical elements; this is called radioactive decay. Decay means that the nucleus (with the number of protons) is changing; therefore, the chemical elements are changing, accompanied by different types of radiation. For instance, cobalt with an atomic mass of 59 (59Co) is a natural, stable element, whereas 60Co is radioactive and artificially produced. 60Co is a beta and gamma emitter and decomposes to nickel-60 with a half-life of 5.26 years. Plutonium-239 (239Pu) is a typical alpha emitter with a half-life of 24,200 years. The half-life is defined as the period it takes for a certain amount of a radioactive element undergoing disintegration to decrease by half. This half-life varies depending on the isotope, ranging from fractions of seconds to millions of years.
This is a typical characteristic of radioactive materials: due to decomposition over time, the chemical composition changes. Consequently, if a sample taken some years ago is analysed again, both the chemical composition and the activity will differ. This decay process is accompanied by the release of energy. In nature, there are different so-called decay chains for different natural isotopes linked with the type of radiation produced. At the end of each natural decay chain, after passing through various intermediate chemical elements, there is a stable isotope, such as lead. The decay of uranium-235 (235U) will yield, after several intermediate steps, where other (also partly radioactive) elements are produced, the final stable element will be lead-207 (207Pb) at the end of this alpha decay chain. Therefore, by analysing a sample of uranium, you may find traces of different chemical compounds due to the products of the decay chain.
Radionuclides that accumulate in the body pose a significant threat to human health. Strontium-90 is a typical beta-emitter and due to its chemical similarity to calcium, it can be deposited in bones and bone marrow, leading to its accumulation in the body. Another example of how radioactive material may accumulate in the human body is iodine-131 (131I), which collects in the thyroid gland. Normally, non-radioactive 127I would be deposited there, but as it has the same chemical characteristics, radioactive iodine will also accumulate in the thyroid. This is the reason why, after accidents in nuclear power plants where 131I might be released, iodine tablets are given to the population before exposure to radioactive iodine. The tablets prevent its absorption because, once the more stable iodine is absorbed post-digestion, it blocks the absorption of radioactive iodine in the thyroid.
Radiation is generally defined as energy in the form of waves, photons or particles propagating through space. There are five forms of ionising radiation:
1. Alpha radiation is particulate radiation with relatively large mass and energy. It only has a short range in air (1–2 cm) and can be completely blocked by paper or skin. Outside the body, alpha radiation is not hazardous; however, it poses a risk if the emitting material is ingested within the body because internal tissue has no protection against the particulate radiation.
2. Beta radiation involves an electron emitted by an atom’s nucleus. The particle has very low mass and a greater range than alpha radiation. A sheet of plastic, glass or metal can effectively shield beta radiation. It can penetrate the skin and be absorbed into living tissue, causing ionisation, which can be harmful. High exposure to highenergy beta particles can cause skin ‘burns’. Beta emitters are particularly hazardous if taken into the body.
3. Gamma radiation is a high-energy photon emitted from an atom’s nucleus. The photon has negligible mass and a significant range. It interacts with the electrons of the material into which it is absorbed. It can be highly penetrating and only a substantial thickness of dense material, such as concrete, steel or lead, can provide effective shielding. Gamma radiation can therefore deliver significant doses to internal organs without the emitting material being taken into the body.
4. Neutron radiation occurs when a neutron is emitted from
an atom’s nucleus. Neutrons lack a net electric charge, are relatively small and light in atomic terms and cannot directly cause ionisation. Neutrons easily travel through the air for hundreds of metres without interacting, making them highly penetrating. When they collide with the nuclei of atoms in an absorbing material, they can damage the material and make it unstable, which means that they can be very damaging to living tissue. Neutrons can only be shielded by hydrogenous materials, such as water or paraffin. For example, it typically takes several metres of concrete or metal to stop neutrons. Free neutrons outside a nucleus are unstable and decay quickly. In the context of nuclear security, there is no relevant neutron background, therefore neutron detection with portal or hand-held detectors never results in an ‘innocent alarm’. An innocent alarm is a valid alarm, but the subsequent assessment reveals the radioactive material in question is under regulatory control. Neutron sources are commonly used in fundamental research like scattering and diffraction experiments, but they are also utilised in various fields such as bulk media analysis, biomedical, borehole, neutron radiography, radiation damage investigation, engineering, biology, chemistry, medicine, petroleum exploration, nuclear power and weapons and more.
5. X-rays are also ionising radiation, similar to gamma rays, as they are high-energy photons but lower in energy than gamma rays. There is no radioactive source material in an X-ray machine. Only the X-ray tube in the machine produces X-rays, and this occurs only while the machine is powered. Once the X-ray machine is switched off, no more X-rays are produced.
In summation:
• Small particles
• Easy to transport
• No need for heavy shielding (it can be shielded by a plastic box or thin piece of paper)
• Does not penetrate skin
• Short distance of ionising radiation in the air – a few centimetres
• Symptoms appear later
• Can lead to serious health hazards when ingested or inhaled due to limit treatment options
• Licensed and restricted
• Available in some industrial facilities, laboratories or old industrial equipment
• Greater ability to penetrate materials than alpha
• Easy to transport
• No need for heavy shielding (it can be shielded by a tiny plastic box of less than 2.5 cm)
• Can travel through many centimetres or even metres in the air
• Symptoms appear later
• Can penetrate skin but is less ionising than alpha radiation
• Can also lead to serious health hazards when ingested or inhaled due to limited treatment options
• Licensed and restricted
• Available in some industrial or medical facilities, laboratories or old industrial equipment
• Strong ability to penetrate tissue
• Difficult to transport if perpetrators want to be protected from irradiation; steel, concrete or water are required for protection
• Need for heavy shielding
• Considered an external hazard
• Limited treatment options if ingested or inhaled or when exposed from outside the body
• Licensed and restricted
• Available in some industrial or medical facilities, laboratories, industrial equipment and nuclear facilities
Non-ionising radiation is radiation on the lower end (read: less energy) of the electromagnetic spectrum, such as electric fields, magnetic fields, microwaves and the like. It is often referred to as Radiofrequency Energy (RF Energy). RF Energy is not linked to a material source, but to an energy source. An incident involving RF Energy becomes a concern in the context of this book when the conduct of the offender has the potential to cause intentional acute injury in one or more victims, often manifested through burn injuries. An RF Energy incident requires an RF Energy-producing source, be it modified or constructed, that can direct energy at a target. The maximum effective range of an RF Energy device is highly dependent on its design and the available power source. It is generally thought to be consistent with the maximum effective ranges of combat handguns. There will be no nuclear or other radioactive material to detect or collect in these cases; evidence will be quite traditional in nature. In United States v. Crawford, 714 Fed. Appx. 27 (2nd Cir. 2017), offenders accused of attempting to maliciously use X-rays were successfully prosecuted in the
absence of evidence related to nuclear or other radioactive materials evidence. A summary of Crawford appears at the end of Chapter 9.
When radiation passes through matter, it deposits some of its energy into the absorbing material by ionisation or excitation of the atoms. It is the ionisation of atoms in tissue, accompanied by chemical changes, that causes the harmful biological effects of radiation. We still do not fully understand all the ways in which radiation damages cells, but many involve changes to deoxyribonucleic acid (DNA). This damage can lead to biological effects, including cell death and abnormal cell development.
When handling radioactive material or dealing with radiation, the ‘As Low as Reasonably Achievable’ (ALARA) principle should be always applied. The level of human exposure to ionising radiation may be controlled and limited in three ways: distance, time and shielding. Distance and time are the best methods for controlling and limiting exposure to radiation. For civil authority experts, shielding is an additional method for reducing exposure.
If an uncontrolled source or device is identified, the public can be protected from radiation by a combination of distance and time. As a general rule, the intensity of the radiation field from a source is reduced in proportion to the square of the distance. When sources or devices are identified, it is important to leave the area immediately to minimise time and thus radiation exposure. The shielding of sources or devices should be implemented based on evaluations by civil authority experts.
In general, nuclear and other radioactive materials are used in the following areas: the nuclear fuel cycle, medical applications,
non-medical irradiation of products, gauging systems, imaging systems (radiography), materials analysis and other miscellaneous uses. Additional details about legitimate uses are described below.
There are two key areas of potential danger associated with the use of radioactive sources:
1. Death or injury resulting from accidents involving radioactive sources.
2. Death or injury resulting from the malicious use of radioactive sources.
A radioactive source that is not under regulatory control, either because it has never been under regulatory control or because it has been abandoned, lost, misplaced, stolen or otherwise transferred without proper authorisation, is known as an ‘orphan source’. Such sources represent the greatest risk in the case of either an accident or malicious use.
The commercial use of radioactive materials is mostly in the form of sealed sources, which means that they are encapsulated in such a way that, under normal conditions, the radioactive materials are not released. This means that no contamination is occurring, contamination being defined as the unwanted or unintended presence of radioactive substances (for further information, please see The 2022 (Interim) Edition of the IAEA Nuclear Safety and Security Glossary (IAEA 2022).
Nuclear material is defined by the IAEA as uranium, including 233U, 235U and 238U, thorium and plutonium, including 239Pu, 240Pu and 241Pu. Nuclear fission is the splitting of an atomic nucleus,
which releases a large amount of energy and requires nuclear material. Some nuclear material is fissionable, and some is both fissionable and fissile. The difference lies in the energy required for the nuclear material in question to undergo fission. Nuclear material is used in applications requiring a fission reaction, such as in nuclear power plants. A subset of nuclear material is weapons usable nuclear material, and the category is self-explanatory. Prosecutors should note radioactive material that is not nuclear material is not usable to fuel a nuclear weapon.
Nuclear fusion is the combining of certain nuclei, forming heavier nuclei and releasing a large amount of energy. Fusion is the process that powers stars and has not yet been captured by humankind for wide-scale constructive purposes. Nuclear fusion is commonly fuelled with deuterium and tritium, elements that are not nuclear material. Many nuclear weapons use a combination of fission and fusion reactions.
We cannot ‘register’ ionising radiation with our senses, so the only way to become aware of the presence of ionising radiation is to use equipment to detect it. Various detectors for nuclear and other radioactive materials exist. Depending on the type of radiation, different types of detectors are needed. In most cases, a gamma detector is used to detect radioactive materials. However, in some cases, neutron detectors are also required. Neutrons can be generated, for example, when an alpha-emitter hits beryllium apart from the fission processes, where neutrons are produced to sustain the fission process.
Diverse situations, ranging from the illicit possession of small quantities of radioactive material to the possession of and trafficking of weapons-grade nuclear material, pose a serious health and security threat. In the event of a chemical, biological, radiological or nuclear crime, the investigation and prosecution process will require interaction and coordination between the investigative bodies and public health agencies. In the case of nuclear and other radioactive materials, collaboration with radiation protection and regulatory agencies is crucial. Law enforcement operations, radiation protection procedures and emergency response activities should be coordinated and applied simultaneously at a radiological crime scene (RCS). The presence of nuclear and/or other radioactive material at the crime scene will significantly affect traditional crime scene investigation procedures, since a set of special safety rules needs to be applied, for example, the use of personal protective equipment (PPE) and the involvement of radiation protection experts. Grading radiation exposure according to the ALARA principle, three main measures of radiation protection are time, distance and shielding. Consequently, operations at an RCS differ from those at most other crime scenes. This distinction involves the need to control those elements, such as the time spent in hazard control areas, the distance between the evidence contaminated with radionuclides and the individual collecting the evidence, the radiation shielding between the evidence and the individual, as well as considerations for radionuclide contamination and individual radiation exposure.
According to the World Health Organization, radiation damage to tissue and/or organs depends on the dose of radiation received, or the absorbed dose, which is expressed in gray (Gy) units. The potential damage from absorbed doses depends on the type of radiation and the sensitivity of different tissues and organs. Therefore, in addition to the absorbed dose, it is essential to define the effective dose. The effective dose is used to measure ionising radiation in terms of its potential for causing harm. The unit for the effective dose is a sievert (Sv). This dose takes into account both the type of radiation and the sensitivity of the tissues and organs.
Therefore, the best way to estimate the potential harm to individuals is by calculating and/or measuring the effective dose. The Sv is a very large unit; what we expect to measure in reality are millisieverts (mSv) or microsieverts (μSv). What we usually measure in the field is actually the rate at which the amount of radiation (dose) is delivered. That is a dose rate, so we are measuring microsieverts per hour (μSv/hour) or millisieverts per year (mSv/year). According to Council Directive 2013/59/ EURATOM, (European Atomic Energy Community, hereinafter EURATOM), the limit on the effective dose for occupational exposure shall be 20 mSv in any single year. However, in special circumstances or for certain exposure situations specified in national legislation, a higher effective dose of up to 50 mSv may be authorised by the competent authority in a single year, provided that the average annual dose over any five consecutive years, including the years for which the limit has been exceeded, does not exceed 20 mSv. The limit on the effective dose for public exposure is 1 mSv in a year.
Although it is vital to identify the type of radioactive material that may be involved in an incident, it is also important to know the quantity of the material. The quantity is generally given in grams, while the activity of radioactive material is given in becquerels (Bq) or curies (Ci). A nuclear explosion can occur only when the quantity of weapons usable nuclear material exceeds a certain threshold. However, exposure to radiation from radioactive material, including nuclear material, and weapons usable nuclear material, is assumed to pose a risk to health at any level, with the actual risk of health effects dependent on the magnitude of the dose of radiation received.
Thus, incidents involving nuclear material that is not of a sufficient quantity to produce an improvised nuclear device (IND) — that is, a nuclear weapon not manufactured within the parameters of a recognised state programme —may nevertheless pose health or safety risks. On the other hand, radioactive sources in the hands of unauthorised persons or groups could be used for malevolent purposes, such as the fabrication of radiological dispersal devices (RDD) — devices designed to spread radioactive material and are also known as ‘dirty bombs’ — or handled in ways that jeopardise public health, safety and security.
High-activity sources, if not managed safely and securely, can cause severe health effects to individuals in a short period of time, whereas low-activity sources are unlikely to cause exposure with harmful consequences. This is an important point that should be taken into account when considering the management of any unauthorised radioactive material that has been discovered. It calls for an approach that is graded according to the harm that might be caused. An International Atomic Energy
Agency (IAEA) safety standard titled ‘Categorization of Radioactive Sources’ (IAEA, RS-G-1.9) provides a risk-based ranking of radioactive source, allowing for risk-informed decisions to be made in a graded approach to the control of radioactive sources for safety and security purposes. The categorisation is based on the potential of radioactive sources to cause harm to human health and is intended to assist in ensuring an appropriate level of control for each source.
The categorisation is based on the concept of ‘dangerous sources’, which are quantified in terms of ‘D values’. The D value represents the activity of a specified radionuclide that, if not under control, could cause severe health effects in the short term, including death. This assessment considers a range of scenarios, encompassing both external exposure from an unshielded source and internal exposure following the dispersal of the source material. The categorisation system has five levels, with sources in Category 1 being the most ‘dangerous’ because they can pose a very high risk to human health if not managed safely and securely. The activity of a Category 1 source exceeds 1000 times the D value. At the lower end, the sources in Category 5 are the least dangerous. The activity of a Category 5 source is less than 1/100 of the D value. This categorisation should guide risk-informed decisions to ensure that the response to any incident can be appropriately graded. Only those items containing radioactive material in the higher categories, in particular, Categories 1 and 2, are of primary concern from the perspective of nuclear security. Examples include irradiators, teletherapy devices, industrial radiography sources, brachytherapy sources with high or medium dose rates and large calibration sources.
The radiation dose depends on the duration of exposure, the amount of radiation generated from the radiation source (including the activity of the radiation source, the chemical and physical composition, etc.), the distance from the radiation source and the amount and type of shielding used. In general, radiation doses may be received when a person is 1) in close proximity to an unshielded or partially shielded source, 2) unprotected when handling radioactive materials, 3) in close proximity to surfaces or areas contaminated with radioactive materials, or 4) contaminated with radioactive materials.
The dose delivered to tissue from ionising radiation can be either acute, where the energy is absorbed over a few hours or days, or chronic, where the energy is absorbed over a longer period of months or years or even a lifetime. The dose becomes particularly important when an individual is exposed to radioactive materials inside the body. In distinguishing between acute and chronic exposure, both the intake rate and the physical, chemical and biological aspects of radionuclide kinetics must be considered. For radioactive materials with effective half-lives longer than a day, even if the intake is brief (minutes to a few days), the energy is deposited in tissue, where it remains over a period longer than a few days. In this case, the exposure to the surrounding tissue is of a chronic duration. Depending on the size of the dose and the dose rate, the effects of ionising radiation can either be acute (occurring within several hours to several months after exposure) or delayed (occurring several years after exposure). Radiation material has been used in several cases to commit crimes such as poisoning or radiation exposure to potential target persons. One notable criminal case of radiation poisoning is the Litvinenko case, in which a former Russian intelligence officer was poisoned by polonium-210
( 210Po) in 2006. 210Po is a pure alpha emitter with a short halflife and is therefore very hazardous if swallowed, as occurred in Litvinenko’s case. He received an acute internal dose.
Health effects from radiation doses can be grouped into two categories: deterministic and stochastic. Deterministic effects occur after a threshold dose is reached. The effects manifest early, with severity increasing at higher doses and dose rates. Examples of deterministic effects include acute radiation syndrome (a syndrome that represents the collection of bodily effects resulting from exposure to large amounts of radiation), skin burns and sterility. Below the threshold, specific effects are not expected.
If the dose is low or delivered over a longer period of time, there is a greater opportunity for the body’s damaged cells to repair themselves, but harmful effects may still occur. The effects of this type of health effect, called stochastic, are not certain to occur, but their likelihood increases with higher doses; the timing and severity of an effect do not necessarily depend on the dose. Stochastic effects occur by statistical chance. Cancer is the main stochastic effect that can result from radiation doses, often many years following exposure. Stochastic health effects are assumed not to have a threshold dose below which they do not occur. This is the reason that no level of radiation dose is considered to be completely ‘safe’ and why doses should always be kept As Low as Reasonably Achievable (ALARA).
If the radiation is higher than a certain threshold, it can impair the functioning of tissues and/or organs and produce different effects. Exposure to above-normal levels of radiation can lead to fatigue, nausea, vomiting and changes in the blood.
Exposure to very large doses of radiation can lead to radiation sickness, with symptoms such as loss of appetite, hair loss, diarrhoea or even death within a few days or months. This is called acute radiation syndrome. The dose threshold for acute radiation syndrome is about 1 Sv (1000 mSv). All mentioned effects are more severe at higher doses and higher dose rates. A very high dose to the whole body of a person can cause death within days or weeks. For example, a dose of 5 Gy or more received instantaneously would likely be lethal, at least without treatment. Such a dose to a limited area of the body might not prove fatal, but other early effects could occur. For example, an instantaneous absorbed dose of 5 Gy to the skin would probably cause erythema (skin burns), although the damage may well be more severe than that caused by a conventional burn, due to the deeper penetration of the radiation). The mutation of a cell is assumed to be possible at any level of exposure, although the risk (probability) of the mutation eventually leading to health consequences will depend on the magnitude of the dose received, because there is a greater likelihood of repairing the radiation damage inside the body, when the dose is low. Thus, if the dose is lower than that which will lead to early health effects or is delivered over a longer period of time, there is the possibility of cancer induction later in life. Additionally, there is the possibility of health consequences for the descendants of the irradiated person, although such health consequences have never been observed in human populations. The risk is higher for children and adolescents, as they are significantly more sensitive to radiation exposure than adults. Information on the effects of exposure to ionising radiation is collected and assessed periodically by the United Nations Scientific Committee on the Effects of Atomic Radiation.
When the presence of radioactive material is suspected to be present at a crime scene, radiological mapping is one of the first steps to be taken. Radiological mapping is the measuring and recording of radiation present at predetermined locations in a given area. If the dose rate at the crime scene is deemed high, it is obligatory to protect crime scene personnel and everyone who enters the area according to the ALARA principle. This can be achieved by controlling the time spent at the scene or by using protective equipment or shielding, such as lead vests. In general, the following principle applies: any work in the radiation field and areas contaminated with ionising radiation requires the use of special PPE to avoid incorporation of radionuclides and direct contact with skin. Chemical-resistant, closed coveralls, double- or triple-layer gloves, or a respirator may be used in addition to electronic personal dosimeter, depending on the severity of the dose rate at the RCS. The main problem is that moving and manipulation in PPE is very uncomfortable because it affects vision, hearing and communication. According to the IAEA Nuclear Security Series (NSS) No. 22-G, hazard control areas must be established and marked out, considering the doses and weather conditions. For example, wind direction may greatly affect the spread of radiocontamination.
It is advisable to minimise the number of people entering the RCS. The most important thing is to identify and mark radiological ‘hotspots’ during the initial radiation survey and to remove the radioactive objects from the site as soon as possible to reduce the risk. However, before that, all the data need to be recorded from the original scene. The values of dose rates and the presence of contamination with alpha or beta-emitting radionuclides, gamma and possible neutron irradiation at the crime scene help determine the protective measures for the
crime scene personnel (what type of protective equipment is needed, how long they can stay at the crime scene, how close to the source they can approach, etc.). The type of PPE used by law enforcement officers during their investigation depends on the expected hazards and is guided by advice from scientific/ radiation protection experts. These experts also advise local law enforcement on evidence recovery plans and provide radiation detection information from the scene. Establishing channels of communication and relationships is key to ensuring that any RCS is managed effectively and efficiently.
Regardless of the severity of the incident, the overriding considerations should be to: (a) minimise any potential health hazards; (b) bring the nuclear and other radioactive material under appropriate control; (c) investigate, gather evidence and prosecute offenders; (d) address public concerns. The scale of the response should be consistent with the severity of the situation.
The ‘dual’ in dual-use refers to both civilian society and the military. Dual-use items are goods, computer programs and other software, and technology that can be used in both civilian and military applications. The term was derived from the world of export controls. Regarding RN materials and equipment, items
intended for a peaceful purpose, may be intentionally diverted and used for an illegal and non-peaceful purpose. There are threat actors, both state sponsored and non-state sponsored, who have publicly voiced their desire to develop such RN military and criminal programs.
Radioactive sources have many legitimate uses in a range of medical, research and commercial areas, including industrial applications. In medicine, for example, radioactive materials are used for blood irradiation to prevent graft-versus-host diseases that may occur after transfusions. A widely used field is cancer therapy. Technologies outside the body use, for example, beam therapy or stereotactic radiosurgery. Cancer therapy inside the body may be treated with brachytherapy using radioactive materials at a high dose rate, specifically targeting cancer cells. Recently, ultraportable X-ray generators have also been produced.
Nuclear and other radioactive materials are used for fundamental research, education and training and specialised research, e.g., for cell or tissue treatment. Industrial and commercial applications include industrial radiography to visualise structures and detect defects in structures, such as cracks in pipework or reactor vessels. In addition, radioactive sources are used in industrial gauges measuring levels, flow or the thickness of materials. Other applications include radioisotope thermoelectric generators (RTGs) for remote regions with low accessibility and no energy infrastructure. This is, by no means, an exhaustive list. The commercially used sources are mostly encapsulated and, for instance, in the case of industrial radiography, mounted at the end of chain or cables so they can be extracted safely from a distance out of their shielding container when in use.
The following list shows the most relevant isotopes used in medicine, research and industry, offering a non-exhaustive description:
• Cobalt-60 ( 60Co) is used mainly in medical device sterilisation, research, cancer therapy and industrial radiography. Sources with very low activity are also used for education and training.
• Form: solid metal or metal alloy.
• Half-life: 5.27 years.
• Production: by-product in nuclear reactors by neutron activation of cobalt-59.
• Cesium-137 (137Cs) is mainly used for blood irradiation, brachytherapy, sterilisation of medical devices, food irradiation for sterilisation, research including calibration devices and well logging. Sources with very low activity are also used for education and training.
• Form: depending on the application, it comes in the form of a compressed caesium chloride powder or a ceramic or a glass. In irradiators and calibration devices, it is in the form of a compressed caesium.
• Half-life: 30.1 years.
• Production: by-product of the nuclear fission of uranium.
• Iridium-192 (192Ir) is mainly used for industrial radiography, e.g., non-destructive testing (NDT) of the welding in pipework and other reactor components. It is also used for cancer therapy to treat localised tumours.
• Form: discs, capsules or needles.
• Half-life: 74 days.
• Production: in a nuclear reactor by neutron irradiation of stable 191Ir.
• Selenium-75 ( 75Se), like 192Ir, is used for industrial radiography, e.g., non-destructive testing (NDT) of the welding in pipework and other reactor components.
• Form: cylindrical or spherical-like pellets.
• Half-life: 120 days.
• Production: in a nuclear reactor, by neutron irradiation of stable isotopically enriched 74Se.
• Americium-241 (241Am) is used in certain types of smoke detectors or, when mixed with beryllium to create a neutron source for examining boreholes and wells.
• Form: depending on the application, e.g., highly compressed pellets of a blend of americium oxide and beryllium metal powder.
• Half-life: 432.2 years
• Production: in a nuclear reactor by successive neutron capture from 238U leading to the formation of 241Pu, which decays by beta emission with a half-life of 14.35 years to 241Am.
Depleted uranium (DU) may be used as shielding, for example, for 192Ir sources. Another shielding material that is more expensive but that meets the requirements of high density and good shielding capacity is tungsten. DU and tungsten are also used in penetrators in anti-tank ammunition, which makes them dual-use goods as well.
Dual-use items related to nuclear and other radioactive materials are subject to specific regulations and compacts. National legislation and regulation in this field are mainly based on lists and recommendations from international arrangements, groups and committees. These are primarily:
• Wassenaar Arrangement
• Zangger Committee
• Nuclear Suppliers Group
These compacts are discussed further in Chapter 7.
The dual-use regulation of the European Union (EU) is considered an important reference document for many countries. This regulation pertains to the control of exports, brokering, technical assistance, transit and transfer of dual-use items. The dual-use list not only includes radioactive isotopes, but also other materials and equipment related to nuclear technologies. These may encompass special alloys and specific equipment, such as centrifuges. Here are some examples from the EU’s dual-use list:
• Boron, enriched in the boron-10 (10B) isotope to greater than its natural isotopic abundance, as follows: elemental boron, compounds, mixtures containing boron, manufactures thereof, waste or scrap of any of the foregoing.
• Tungsten, tungsten carbide and alloys containing more than 90% tungsten by weight, e.g., with one of the following characteristics:
• In forms with hollow cylindrical symmetry (including cylinder segments) with an inside diameter between 100 mm and 300 mm and a mass greater than 20 kg.
• Calcium, magnesium, bismuth, beryllium, hafnium, lithium, zirconium, tritium, helium-3 and radium-226 with certain characteristics, subject to control depending on purity, concentration and other aspects, such as ratio to other substances in a mixture.
• Radionuclides appropriate for making neutron sources.
• Specifically listed ‘radionuclides’ appropriate for making neutron sources depending on whether they are in their elemental form or in compounds, mixtures or products exceeding a total activity of 37 GBq/kg. The list of these radionuclides is as follows:
• Actinium-225
• Actinium-227
• Californium-253
• Curium-240
• Curium-241
• Curium-242
• Curium-243
• Curium-244
• Einsteinium-253
• Einsteinium-254
• Gadolinium-148
• Plutonium-236
• Plutonium-238
• Polonium-208
• Polonium-209
• Polonium-210
• Radium-223
• Thorium-227
• Thorium-228
• Uranium-230
• Uranium-232
Other materials and equipment are mentioned in the dual-use regulation, covering a broad range of applications. This includes the reprocessing of irradiated fuel elements from nuclear reactors and the specific materials necessary for manufacturing nuclear weapons. New and upcoming nuclear technologies involve additional materials. For example, molten salt reactors may involve uranium tetrafluoride (UF4) or thorium tetrafluoride (ThF4) dissolved in molten fluoride salt. Other examples are sodium- or lead-cooled reactors. However, the number of compounds employed even in new technologies is limited. Additionally, there is a growing trend to gradually replace technologies using radioactive materials with alternative technologies. Considering the wide spectrum of technologies in the nuclear field, it is highly recommended to engage a forensic consultant to advise prosecutors, when necessary. Moreover, some materials and equipment are not evidently connected to these technologies, requiring specific expertise in this field.
Nuclear and other radioactive materials may be recycled or reused. Recycling involves disassembling the source and recovering the radioactive material as a single element, whereas reuse means
redeploying a source in the same or different applications without a physical change. This is feasible if the new application does not require the dose rate and activity of the freshly produced radioactive material, as was necessary for the former application.
Radioactive materials may harm the public through negligent behaviour. In September 1987, trespassers entered an abandoned hospital in Goiânia, Brazil with the goal of locating salvageable materials to sell. They eventually removed a caesium-137 (137Cs) source from an unguarded therapy unit, ultimately accessing the 137Cs itself. The 137Cs was spread to six locations, resulting in four deaths, several amputations and various degrees of illness effecting those exposed.
There are numerous ways for perpetrators to use nuclear and other radioactive materials maliciously, leading to criminal liability. Cases around the world have involved fraudulent radioactive material mitigation in environmental protection scenarios, where the perpetrators have dumped radioactive material wrongfully after contracting to dispose of it in an authorised, and more expensive manner, keeping the economic difference as illegal gain. Instances of trafficking are well documented. Radioactive sources have been used to target individual victims with the intent to assault and/or murder them. Additionally, these materials can potentially be used as area deniability devices, through the unlawful spread of a contaminating material. Then, of course, there is the threat of terrorism.
Radiological–nuclear terrorist incidents are usually categorised as serious, if not the most serious, acts against the state system. If a nuclear scenario were to occur, it could lead to a complete breakdown of the entire state system. However, stringent security measures make nuclear weapons attacks unlikely, given the difficulty in accessing weapons-grade nuclear material. Radiological attacks, on the other hand, are considered reasonably realistic. A key issue related to radiological terrorist plots is the difficulty of identifying the presence of radioactive sources prior to the detection of radiation sickness or other related injury. This difficulty arises in the absence of specific gathered intelligence on the possibility that radioactivity has been released and that detection devices have not been deployed.
The challenge with a radiological terrorist attack is that radiation is odourless and invisible. However, simple measurement equipment can easily detect most types of radioactivity. The risk can be acute, but in general, less so than for a chemical attack. Even though several types of radioactive materials exist, only around a dozen represent a serious RDD security threat due to their high radioactivity, portability, dispersibility and availability.
Terrorist groups can select different attack sites in their planning based on their targets, capacity to perform the terrorist act, the perceived vulnerability of the target location and pertinent infrastructure and the basis of opportunity. This opportunity might present itself in the form of a mass sporting, cultural, political or religious event. Both indoor and outdoor spaces can be targeted. The use of nuclear or other radioactive materials can produce different effects depending on several factors, but primarily on the type of radionuclides and their categorisation according to the Code of Conduct on the Safety and Security of Radioactive
Sources (see reference three below). Other influencing factors include their energy, the form in which they are found, the method of weaponisation and the modus operandi.
Terrorist attacks involving nuclear and other radioactive sources can be divided into three categories: radiological attacks with a variety of possible harmful activities; attacks with a nuclear explosive device; and an attack on or sabotage of a nuclear power plant or the transport of a nuclear device or components of a device.
Radiological attacks with a variety of possible harmful activities can be further identified as follows:
1. A Radiation Exposure Device (RED), according to the IAEA, is a device containing radioactive material designed for the intentional exposure of members of the public to radiation. The RED could be fabricated, modified, or improvised, ranging from a very simple mechanism to a quantum of radiological material itself. The deployment of a RED can be simple as well. It can be placed in various locations such as public transportation, public spaces or public buildings.
2. A Radiological Dispersal Device (RDD) is a device designed to spread radioactive material using conventional explosives or other means. The concept may also be referred to as a ‘dirty bomb’. An RDD attack may omit the use of conventional explosives in favour of spreading gaseous, liquid or aerosol contaminants using aircraft, drones or other remote-control vehicles properly equipped. RDDs are often characterised as area deniability weapons. Even if radiation levels following the incident are not
particularly acute, significant reassurance may be required for the public to enter affected areas in the future.
3. Contamination attacks occur when malicious actors intentionally contaminate common items, such as banknotes and mailed items, using radioactive substances, and then reintroduce those items into circulation. Water and/or food contamination occurs when malicious actors intentionally contaminate consumable resources with radioactive materials intending to introduce those resources into a victim’s body through inhalation, ingestion or injection, mainly causing an internal radiation dose.
4. A sabotage attack on a nuclear facility or transport with the intention of causing a release of radioactive material. Nuclear material in storage, use or during transport is subject to stringent physical protection measures as regulated by the Convention on the Physical Protection of Nuclear Material (CPPNM) and its Amendment.
Radiological attacks do not pose the same level of significant destructive power as nuclear explosion scenarios; however, they are much more likely to occur. Consequently, considering the psychological and financial impacts, they are probably the greatest threats posed by such attacks, primarily due to direct costs (decontamination, reconstruction) and indirect costs (economic damage).
A non-state actor perpetrating an attack with a nuclear weapon, defined as an explosive device fuelled by weapons-usable nuclear material, can be considered the most dangerous form of malicious conduct. If such an incident were to succeed, catastrophic con-
sequences for the population, infrastructure, health, environment, economy and the state system would be expected. The extent of these consequences depends on the scale and location of the attack. Given the harmful, cruel nature and the significant impact, States should prepare for such an event. While preventive measures may be costly, it is presumable that investing in such efforts is much more cost-effective than waiting for the opportunity to implement response protocols.
Malicious actors may acquire a nuclear weapon via theft from a nation-state storage arsenal or through the production of a homemade nuclear weapon using highly enriched uranium or plutonium. Once a nuclear weapon has been removed from ownership custody, it is referred to as an IND in the same way as one constructed by non-state actors outside of nation-state control. Fortunately, the perpetrator production of a nuclear weapon is very difficult to carry out due to the complexity of manufacturing such devices and the challenge of obtaining the necessary nuclear materials. However, it is important to note that a zero probability of this situation does not exist.
Criminal activity of a serious nature, such as terrorism, always produces harmful consequences. However, its scope, impact on society and loss of human life depend on several factors. Above all, it concerns the capabilities of the perpetrators, their materials and equipment, modus operandi, the correct selection of targets based on surveillance and detection of vulnerabilities, and their proficiency in training. This is particularly crucial in criminal activities involving the use of nuclear and other radioactive materials. Nevertheless, at each stage of preparing for such an offence, there are certain warning signs that can be detected by law enforcement agencies.
Therefore, building the investigation file and initiating a successful prosecution process rely on early identification and notification by responding investigation agencies. Appropriate training and available guidebooks about warning signs or risk indicators may lead to the preservation and collection of evidence, supporting the successful and timely activation of the prosecutorial process.
Understanding the lifecycle of such crimes and the potential categories, along with the possibility of early recognition, notification and involvement of prosecutors, is crucial for fighting crimes related to nuclear and other radioactive materials. The types of evidence can be linked to each process of the lifecycle, requiring special awareness.
Like chemical and biological crimes, in this type of criminal conduct, the motivations, motives and intent of the perpetrators are varied and can be linked to individuals, groups or sophisticated networks. They can be driven by political, religious, ideological, social and financial motivations, targeting individuals, groups, geographic areas or countries.
Yet, the lifecycle of that crime passes through four key phases: planning, acquisition and production, storage and transport, and dissemination. The primary responsibility of any law enforcement, security or intelligence agency is to disrupt activities within the cycle as early as possible. Being able to understand the information or intelligence being supplied creates the opportunity to recognise a possible future crime, identify the elements of an offence, and prosecute before, not after, the event. Understanding the lifecycle and the related activities will enable investigative bodies and prosecutors to identify triggers and react with efficiency, with the aim of protecting people, property and assets.
Planning
Acquisition and Weaponisation
Storage, Shielding and Transport Dissemination or External Exposure
The planning phase is the first phase. One of the fundamental challenges for law enforcement, environmental agencies and prosecutors investigating potential crimes involving nuclear or other radioactive materials is determining whether there is an intent to cause harm. The identification of criminal intent may
commence in the early planning stages; however, the necessary operational tools must be put in place, including risk indicators with detection capabilities. The planning stage may provide evidence of an underlying ideology, political motivation, personal vendetta or social cause. There may be evidence of an identified target and an expressed will to acquire and utilise a particular radioactive material for no other reason than criminal activity. The identification of such evidence may be categorised as described below.
Target identification and surveillance are important aspects of RN criminal prevention. Surveillance of societal vulnerabilities is one of the primary activities of perpetrators as they select their targets. Prosecutors should routinely meet with the appropriate protective services in their jurisdictions to become familiar with targets attractive to the RN offender.
Surveillance of a target may be undertaken over the long term, depending on the type of attack and relevant needs for preparation. Evidence of surveillance may take the form of photographs, video footage from hidden or overt cameras or drones, physical or digital documents, mobile phone records, witness testimony and records from measurement devices.
The second category is the selection of the nuclear and other radioactive sources used by the perpetrator. This is dependent on numerous factors, some of which include:
• Purpose of the attack (motive, targeted/mass dissemination, overt/covert).
• Ease of acquisition.
• Characteristics of the material, including type of radiation, timeline to symptoms, source activity and energy radiation, half-life, form (powder, liquid, solid or aerosol), whether it is sealed or unsealed, toxicity, resulting symptoms and likely casualties.
• Storage and shielding capabilities.
• Dissemination capabilities.
• Treatment options.
• Transport requirements – shielded.
The following provides a brief comparison of radioactivity characteristics by type, which may influence selection and planning options.
The third category can be labelled communication among offenders. The deliberate use of nuclear or other radioactive material requires a series of actions that involve communication among terrorist members if the act of terrorism is not conducted by a lone wolf. It can provide valuable evidence of the nature, target, timing and complexity of the crime.
Potential sources of communication evidence may include:
• Face-to-face communication (captured through witnesses, undercover operations and police/agency interviews).
• Paper documents (obtained under lawful warrants, searches and physical evidence. Electronic and digital
evidence (including emails, mobile phone calls, social media and online undercover operations, with a special focus on the dark web).
• Delivery of messages by remote-controlled vehicles.
Attack preparation and plan development represent significant adversary vulnerabilities. Logical investigation using potential planning activities as a starting point may yield successful results for the intelligence-driven, prevention-orientated investigation. Existing national legislation may be applied to activate the investigative and prosecutorial processes, facilitating the prevention of an attack and protection of people, animals and the environment.
The second phase is acquisition and/ or weaponisation. The acquisition comprises illegally obtaining nuclear or other radioactive material from different places where they are legally handled or stored. The level of expertise required for this type of act should be high and theoretical knowledge may not be sufficient; a terrorist group will need to contact scientists who can provide mentoring to members of a terrorist cell involved in the preparation of the crime. Prosecutors should not rest until an individual capable of providing that expertise has been identified. The selection of radionuclides will depend on adversary surveillance results and planned objectives.
The activities involved in acquiring materials include the following:
• Illegal purchase of materials indirectly via the internet (surface, deep or dark web) or directly from a seller.
• Theft or illegal purchase from a legitimate facility, whether
it be in research or industry (industries, universities, public health sector or laboratories) and military facilities.
• Theft of radioactive material from transportation vehicles.
• Acquisition of materials from illegal waste landfills or abandoned facilities – often referred to as orphan sources.
Committing crimes with nuclear or other radiological materials mandates certain infrastructure requirements and requires a certain level of professional knowledge if the modus operandi comprises the use of small particles (for ease of dispersion) of radioactive material. Typical improvised facilities used by criminals require reliable infrastructure, including power, water, appropriate ventilation and mechanisms for climate control. Suitable locations may include:
• Rented apartments, old buildings or hotel rooms.
• Abandoned industrial or healthcare facilities and old laboratories.
• Legitimate facilities where oversight of access may not be appropriately monitored.
Locations may be equipped with:
• Telescopic handling tools for nuclear or other radioactive material.
• Specialised heavy containers for shielded transport and storage of nuclear or other radioactive sources material.
Storage and transportation of nuclear or other radioactive material require specific conditions in which terrorist group members will limit their exposure. The selected approach will depend on the type of radionuclide, its activity and shielding capabilities. Storage of such materials will likely be planned in advance to avoid potential contamination, exposure to ionising radiation and disclosure. This may include the need for special containers and abandoned places where the presence of people is sporadic. The process of adequately securing, storing and transporting nuclear or other radioactive material requires an understanding of their physical properties and effects on human health.
Transportation of the weaponised device with radioactive sources can pose additional challenges to terrorist groups, especially with regard to camouflage, as the shielding container will be heavy. Another option with a high level of risk for a person handling an unshielded source is to carry it without a container; however, this option can have fatal consequences. The selected means of transportation will also be dependent on the risk factors associated with the weaponised delivery device, the type of radionuclide and its activity and the availability of transportation options near the target.
Indicators related to this element of the lifecycle may include storage facility leases, the purchase or rental of specific shielding containers, renting a car adapted with a shielding barrier between the driver’s compartment and the back side of the car, closed-circuit television (CCTV) linked to storage locations or on-route transportation.
The dispersion of radioactive material (in the form of a powder, liquid or aerosol) or the use of radioactive sealed sources for
the external irradiation of targeted individuals may occur under different conditions. They may also be assembled with conventional explosive devices, forming an RDD or ‘dirty bomb’, as outlined above.
The categories of radiological and nuclear crimes can be best described by linking such activities with the three types of nuclear security events, based on IAEA NSS No. 37-G, apart from the general descriptions mentioned in this chapter.
A Type 1 nuclear security event is an unauthorised criminal or intentional act in which there is a dispersal of radioactive material, harmful energy release from a nuclear reaction, or harmful radiation exposure of people. A Type 1 nuclear security event will always be a nuclear or radiological emergency. For all but the most minor releases, such an emergency is likely to have severe consequences for persons, property, society and the environment, and may call for the deployment of all available resources (local, national and international resources, depending on the State’s capabilities). If such an emergency is detected or results from the escalation of a lower type of event, the State should take all reasonable measures to minimise its consequences.
Examples of scenarios representative of this type of nuclear security event include, but are not limited to, the following:
• Sabotage of a nuclear facility or nuclear material, resulting in the release of energy and/or dispersal of radioactive material.
• Sabotage of an associated facility using or storing radioactive material or an associated activity (e.g., transport of radioactive material) resulting in the dispersal of radioactive material.
• Operation of a RED or series of REDs, such as a highactivity radioactive source, exposing people in its vicinity to radiation.
• Operation of an RDD or series of RDDs resulting in the dispersal of radioactive material by means of explosives or other means of dispersal (e.g., an aerosol generator, via a building ventilation system, or manually).
• Detonation of an IND, resulting in energy release and dispersal of nuclear material and fission products (i.e. radioactive material).
• Introduction of radioactive contamination at or into one of the following:
• A strategic location, such as the venue of a major public event.
• The food chain.
• The water supply network.
• Cosmetic, pharmaceutical or other products used by the public.
A Type 2 nuclear security event is an unauthorised criminal or intentional act in which there is the confirmed unauthorised presence of radioactive material at a known location, but without dispersal of the material, uncontrolled energy release from a nuclear reaction or uncontrolled radiation exposure. A Type 2 nuclear security event is also likely to be a nuclear or radiological emergency. Such scenarios could arise because an adversary has attempted a criminal or intentional unauthorised act that has been unsuccessful or because an attempt to commit such an act is in progress.
In the latter situation, the State’s focus should be on preventing the successful completion of the act, thereby preventing escalation. Such an event may call for the deployment of substantial resources (local and national resources and, in some cases, international resources, depending on the State’s capabilities) to prevent escalation (e.g., to render an RDD safe to prevent the release of radioactive material or to safely recover radioactive material from an RED before it is used to expose people). Where such an event is detected or results from the escalation of a lower type of event, the State should seek to minimise its consequences and take all reasonable measures to prevent it from escalating to a Type 1 event.
Examples of scenarios representative of this type of nuclear security event include, but are not limited to, the following:
• Attempted sabotage of a nuclear facility or nuclear material without uncontrolled energy release from a nuclear reaction or dispersal of radioactive material.
• Attempted sabotage of an associated facility or associated activity (e.g., transport of radioactive material) without dispersal of radionuclides.
• Attempted operation of an RED without uncontrolled radiation exposure of people to radioactive material.
• Attempted operation of an RDD without dispersal of radioactive material.
• Detection of nuclear material with the potential for an intentional or unintentional assembly that could create a detonation caused by a fission chain reaction. Detection of radioactive material is assessed to be intended for any of the following uses via an RED or an RDD:
• To cause radioactive contamination of a food chain, a water supply network, cosmetic or pharmaceutical products or other products used by the public.
• To cause radioactive contamination or irradiation of a targeted individual in such a way that the impact may be more widespread.
• Detection of radioactive material out of regulatory control.
• At designated and undesignated points of entry and exit.
• Within a State’s interior.
A Type 3 nuclear security event is an unauthorised criminal or intentional act where information alerts alone indicate a credible possibility of criminal or intentional unauthorised use of nuclear or other radioactive material or sabotage, but the location of the nuclear or other radioactive material, or any planned target, may
not be known. A Type 3 nuclear security event may also qualify as a nuclear or radiological emergency. In all cases, establishing the credibility of the information alert should be a priority for the State. A Type 3 nuclear security event may, in general, have moderate to significant consequences for persons, property, society and the environment. However, if an information alert concerns, for example, the theft of highly enriched uranium or a Category 1 source, or the attempted or successful intrusion into a nuclear facility, the Type 3 event could escalate to a higher category event with potentially much more severe consequences.
A Type 3 event will therefore call for the deployment of at least local resources to prevent escalation (e.g., to investigate reports of illicit trafficking, to provide a visible security presence to deter potential adversaries) but may also need the deployment of national and international resources, depending on the nature of the information and the State’s capabilities. Where such an event is detected, the State should always seek to prevent it from escalating to a Type 2 or Type 1 event. Examples of scenarios representative of this group of nuclear security events include, but are not limited to, the following:
1. Information indicating planned or attempted unauthorised removal of nuclear or other radioactive material.
2. The report of the theft or loss of or missing radioactive material, where the whereabouts of that material have not been established.
3. Information indicating planned or attempted sabotage of nuclear or other radioactive material or associated facilities and activities (e.g., transport of radioactive material).
4. Information that there is a RED, an RDD or fission detonation device in a place where it could cause harm to persons, property, society or the environment and/or disruption.
5. Operational information from intelligence services, such as an illicit trafficking warning or information about a known adversary.
6. Information on regulatory non-compliance, such as missing material, discrepancies in accounting for nuclear material or in a register of radioactive material, or other unauthorised acts.
When it comes to the prosecution of nuclear and other radioactive crimes, it is important to bear in mind two essential elements underlying every criminal offence under the International Convention for the Suppression of Acts of Nuclear Terrorism:
1. The general intent to carry out the activity described in the Convention as an offence; and
2. The special intent to cause harm with such activity.
The following criminal offences are defined in Article 2 of the Convention:
1. Any person commits an offence within the meaning of this Convention if that person unlawfully and intentionally:
a. Possesses radioactive material or makes or possesses a device:
i. With the intent to cause death or serious bodily injury; or
ii. With the intent to cause substantial damage to property or to the environment.
b. Uses in any way radioactive material or a device, or uses or damages a nuclear facility in a manner which releases or risks the release of radioactive material:
i. With the intent to cause death or serious bodily injury; or
ii. With the intent to cause substantial damage to property or to the environment; or
iii. With the intent to compel a natural or legal person, an international organisation or a State to do or refrain from doing an act.
2. Any person also commits an offence if that person:
a. Threatens, under circumstances indicating the credibility of the threat, to commit an offence as set forth in paragraph 1 (b) of the present Article; or
b. Demands unlawfully and intentionally radioactive material, a device or a nuclear facility through threat, under circumstances which indicate the credibility of the threat, or by using force.
3. Any person also commits an offence if that person attempts to commit an offence as set forth in paragraph 1 of the present Article.
4. Any person also commits an offence if that person:
a. Participates as an accomplice in an offence as set forth in paragraph 1, 2 or 3 of the present Article; or
b. Organises or directs others to commit an offence as
set forth in paragraph 1, 2 or 3 of the present Article; or
c. In any other way contributes to the commission of one or more offences as set forth in paragraphs 1, 2 or 3 of the present Article by a group of persons acting with a common purpose; such contribution shall be intentional and either be made with the aim of furthering the general criminal activity or purpose of the group or be made in the knowledge of the intention of the group to commit the offence or offences concerned.
National authorities often incorporate all or some of this Convention language into their respective criminal codes. Additionally, it is an international best practice to ensure seamless alignment between regulatory codes governing nuclear and other radioactive materials and criminal codes concerning the trafficking of these materials, both internally to a nation-state and across frontiers, so that criminal legislation, with a meaningful penalty scheme, is available to prosecutors, should such incidents occur.
Case Title:
Date of Investigation:
Nov 2016 - Jan 2018
Level: National Country of Origin: Slovakia
Region/State: North-Eastern
Case Category: RADIOLOGICAL
Incident Summary:
• The perpetrator, S.K., had a history of criminal convictions for extortion, injury, and restriction of personal liberty.
• S.K. sent five threatening letters to various public administration institutions, claiming to have stored americium-24 (241Am), a radioactive material, in plastic bags or envelopes and sent them to court and police offices.
• On November 7, 2016, the first threatening letter containing 241Am arrived at the Regional Court in North-Eastern Slovakia, initiating an investigation that lasted until the end of 2017. On January 15, 2018, the Office of the Special Prosecutor officially filed an indictment against the accused person.
• The letters aimed to intimidate police and judicial staff and disrupt the legal system by causing harm or death to the recipients. A forensics laboratory confirmed the presence of 241Am in the three letters.
• The radioactive material had been intentionally removed from smoke detectors and adapted for use. The detectors originated from the workplace where S.K. was employed. Although dozens of people were potentially endangered, no one was actually contaminated with the hazardous material.
• During a search of S.K.’s home, pieces of evidence, such as gloves and electronic device contents, linked him to the crime. S.K. was initially convicted of terrorism and the illicit production of radioactive devices and possession of radioactive material.
• However, upon appeal, the Supreme Court reclassified the crime to a lesser offence and ultimately convicted S.K. of the continuation of a particularly serious crime of general danger. The decision was based on evidence showing that he intentionally put people at risk of death or serious injury through harmful effects of radioactive exposure and assaulted a public authority by disseminating a false alarm.
• Expert psychiatrists and psychologists diagnosed S.K. with a mental disorder (dissociative amnesia and motor disorder) known as ‘prison psychosis’. However, at the time of the crime, he did not have any mental disorder significantly affecting his control and cognitive abilities. Possible motivating factors included revenge against public authorities and abnormal personality structure.
Investigative Focus:
• The investigation focus centred on discovering the identification of the suspect, and then proving the case by collecting the evidence from the workplace and permanent residence of the suspect.
• Development of the perpetrator profile was based on the content of the threatening letters.
• Geographical location analysis was conducted on targeted places and post offices where the letters were sent.
• Forensic evidence collected from the letters included dactyloscopy, DNA analysis, and forensic handwriting analysis).
Key Points of Evidence:
• Direct and indirect evidence submitted to the court:
. Confirmed presence of americium-241 in three letters (expert testimonies).
. Americium-241 from the working place of the perpetrator (physical evidence).
. DNA collected from stamps (forensic report).
. Envelopes and their graphical aspects (physical evidence).
. Gloves to work with the radioactive source (physical evidence).
. Grammar and the content of the written text (forensic report).
. Scan of the letter found in the personal computer of the defendant (digital evidence – forensic report).
. The defendant’s previous conviction, in particular for extortion, exhibited very similar features both in terms of modus operandi and in terms of the way he defended himself.
. Other experts´ testimonies.
Prosecutorial Priorities:
• The first priority was to collect enough evidence to convict the defendant of the crime of terrorism and the illicit production and possession of radioactive substances due to the potential effects and consequences on the health of people and the state structure.
• The decision of the first-instance court was overturned by the Supreme Court, and the originally achieved priority was thus reversed.
Detection Methods:
• Handheld relevant Alpha, Beta and Gamma detectors/surface contamination measurement instruments.
• Laboratory detection equipment for confirmatory analysis.
Challenges:
• The initial rapid detection of the presence of radioactive material produced results confirming the presence of thorium. Therefore, this element was mentioned in the official record of the entities responsible for the initial detection in a time of emergency. It is important to note that some radionuclides share spectra with others, and when there is not enough measurement time, it can happen that a wrong computer evaluation occurs, determining a nuclide that is not present.
• The next day, a second measurement was taken, and it was found that thorium was not there. The presence of only 241Am was proven. The results of the measurements were presented to the police, both the first and the second in a logical sequence. This fact was used by the defence, arguing that there were differences in the findings of the presence of thorium in the forensic reports. It was necessary to convincingly argue the contrary during expert witness statements based on subsequent forensic analyses.
• A second challenge was to prove that the act could be qualified as a crime of terrorism according to section 419 clause 1 a), 3 b) of the criminal law.
. The first-instance court accepted the arguments of the Special Prosecutor’s Office, while the Supreme Court of the Slovak Republic had a different opinion on the case, especially because in 2016 the court ruled on a similar case, the outcome of which influenced the decision of the Supreme Court.
. The prosecutor’s arguments about the possible serious consequences of the use of 241Am for the health of the affected persons, as well as the content of the threats in the letters sent to public administration institutions, were not enough to convince the justices of the Supreme Court.
Outcomes:
• The decision of the first-instance court sentencing the perpetrator to life imprisonment was changed by the Supreme Court into a 13-year prison sentence for a continuing particularly serious crime of general endangerment and the criminal offence of illicit production and possession of radioactive substances under the Criminal Code of the Slovak Republic.
• At the same time, the convicted person must serve a separate sentence of 11 years imprisonment for a previous criminal proceeding in another criminal matter, totalling 24 years of imprisonment.
1. International Atomic Energy Agency. Identification of Radioactive Sources and Devices, IAEA Nuclear Security Series No. 5, IAEA, Vienna (2007).
2. International Atomic Energy Agency. Combating Illicit Trafficking in Nuclear and Other Radioactive Material, IAEA Nuclear Security Series No. 6, IAEA, Vienna (2007).
3. International Atomic Energy Agency. Code of Conduct on the Safety and Security of Radioactive Sources, IAEA, Vienna (2004).
4. World Health Organization. Radiation Fact Sheet, Non-ionizing Radiation, WHO (2023). Available at: https://www.who.int/health-topics/ radiation#tab=tab_3
5. Moore, G.M. and Pomper, M.A. Permanent Risk Reduction: A Roadmap for Replacing High-Risk Radioactive Sources and Materials. CNS Occasional Paper No. 23, James Martin Center for Nonproliferation Studies (2015).
6. United States Nuclear Regulatory Commission. The 2010 Radiation Source Protection and Security Task Force Report, USNRC (2010). Available at: https://www.nrc.gov/security/byproduct/2010-task-force-report.pdf
7. Hautecouverture, B. (N.D.) A Possible International Regime to Cover Radiological Materials. Fundation pour la recherche stratégique, Centre d’Études de Sécurité Internationale et de Maîtrise des armements. Available at: http://www.iaea.org/inis/collection/NCLCollectionStore/_Public/48/018/48018671.pdf
8. International Atomic Energy Agency. Developing a National Framework for Managing the Response to Nuclear Security Events. Implementing Guide. Nuclear Security Series No. 37-G. IAEA, Vienna (2019).
9. National Academies of Sciences, Engineering, and Medicine. Radioactive Sources: Applications and Alternative Technologies. The National Academies Press, Washington (2021). Available at: https://doi. org/10.17226/26121
10. Regulation (EU) 2021/821 of the European Parliament and of the Council of 20 May 2021.
11. International Atomic Energy Agency. Combating Illicit Trafficking in Nuclear and Other Radioactive Material. Technical Guidance. Nuclear Security Series No. 6. IAEA, Vienna (2007).
12. International Atomic Energy Agency. Radiological Crime Scene Management. Implementing Guide. Nuclear Security Series No. 22G. IAEA, Vienna (2014).
13. US Environmental Protection Agency. Radiation Basics, Washington (2023). Available at: https://www.epa.gov/radiation/radiation-basics
14. International Atomic Energy Agency. IAEA Safety Standards for Protecting People and the Environment, Categorization of Radioactive Sources. Safety Guide. No. RS-G-1.9. IAEA, Vienna (2005).
15. International Atomic Energy Agency. Code of Conduct on the Safety and Security of Radioactive Sources, IAEA, Vienna (2012).
16. Council Directive 2013/59/Euratom. Laying Down Basic Safety Standards for Protection Against the Dangers Arising from Exposure to Ionising Radiation.
17. Owen, R. The Litvinenko Inquiry, The Williams Lea Group on behalf of the Controller of Her Majesty’s Stationary Office. London (2016). Available at: www.litvinenkoinquiry.org
18. United Nations Scientific Committee on the Effects of Atomic Radiation. Sources and Effects of Ionizing Radiation: Report to the General Assembly with Scientific Annexes. Volume 2: Effects, Annex G: Biological Effects at Low Radiation Doses. UN (2000).
19. US Environmental Protection Agency. Exposure Factors Handbook: 2011 Edition. National Center for Environmental Assessment EPA/600/R09/052F, Washington (2011). Available from the National Technical Information Service, Springfield, VA, and online at: http://www.epa.gov/ ncea/efh
20. United Nations Office on Drugs And Crime, Fictional Cases Related to Offences Under the International Convention for the Suppression of Acts of Nuclear Terrorism (ICSANT): A Manual, UNODC (2022).


CHAPTER TWO

Monitoring Current Threats
Personal Data 2.1 2.2 2.3 2.4 2.5 2.6
Types of Intelligence
The Intelligence Cycle Data Sharing Agreements
Intelligence Sharing
The collection and processing of forensic evidence plays an essential role in the criminal justice system by allowing for the examining of physical and trace evidence in support of investigations and subsequent prosecution. Equally crucial is the use of intelligence and information during investigations. To enable prosecutors to access investigative intelligence, it is important for pre-planning to start at the earliest opportunity.
Critical to this are the following:
• Understanding what intelligence is and how it can be used.
• National legislation that determines the means by which intelligence and information are collected and shared.
• Who owns the intelligence, and how is it controlled?
• The need to build trusted networks and agree on intelligence-sharing protocols.
• Role of intelligence during prosecution.
• Determination of investigative priorities and the balance between collecting intelligence and actual evidence.
The threat landscape changes on a regular basis. The visibility of threat groups may increase or diminish over time, but reduced public visibility does not mean zero threat. Accordingly, it is important for law enforcement agencies to monitor current threats and consider how such threats can be eliminated, mitigated or responded to.
The amount of information posted electronically is dramatically increasing and can assist in monitoring threats and criminal behaviour. Monitoring social media can help in tracking online behaviour and social commentary, providing potential indicators for the prevention of or response to a potential crime involving nuclear and other radiological (RN) materials. However, it is essential to recognise that social media is only one source of information, and the data collected must be appropriately weighted.
There are many sources within the global community that can provide reliable information regarding RN materials. These organisations and institutions can also provide a good overview of recent incident reports and possible future trends in the nefarious use of such materials by individuals, groups or State Parties. The following websites are useful resources:
• www.nti.org: The Nuclear Threat Initiative has expanded its area of interest to include biological and radiological materials as well as cyber threats. A closer examination of their home page also discloses information on chemical threats.
• www.chathamhouse.org: Chatham House is the home of the international think tank, the Royal Institute of International Affairs. They cover many complex policy issues, including global threats. Searches can be made by region as well as by subject of interest.
• www.un.org/en/sc/1540/: UN Resolution 1540 of 2005 obliges States, inter alia, to refrain from supporting by any means non-State actors from developing, acquiring, manufacturing, possessing, transporting, transferring or using nuclear, chemical or biological weapons and their means of delivery.
Chapter 10 includes additional international organisations of interest.
International news sources can also provide a good overview of what is currently occurring around the world. Incidents where RN materials have been involved are often reported quickly and widely. Consideration should be given to the fact that news outlets are not subject to the rules of the police, military and others. There can be a tendency to exaggerate or overreact. Information from news sources should always be verified through reliable sources before being acted upon.
Threats can also come from many different sources. The three main sources are as follows:
State Actor
Considered the most serious threat because certain countries have significant resources and expertise to create devices with RN materials. Significant diplomacy has occurred to dramatically reduce this threat, but there are still some concerns.
Terrorists/Organised Crime
Lone Actor
Previous investigations have uncovered the intentions of some terrorist or organised crime groups to use RN materials in their activities. Such groups may lack access to funding or expertise but could aspire to achieve this.
Persistent individuals have used RN materials in their criminal activities. Detecting this type of offender is challenging due to the covert nature of their operations; therefore, this threat vector should not be dismissed.
Two common over-utilised and sometimes misused terms regarding this form of evidence are ‘information’ and ‘intelligence’.
Information is the raw data obtained by an individual, law enforcement agency or intelligence organisation. It can be a simple open-source newspaper article, observations made during a site visit or the spoken word of a human source. This material is raw, unverified and unevaluated, and it would be rare that action based solely on this material would occur. The context of collected in-
formation must undergo validation and verification for it to add value to the investigation. The observations or comments must be corroborated or supported by additional information. The analysis of raw information results in the creation of a product called ‘intelligence’.
In some circumstances, the collection of a large amount of information can generate data that must be protectively marked. This is usually due to the resultant data revealing an overarching conclusion that should not be publicly accessible. This type of information must be protectively marked for protection and managed accordingly.
Intelligence is frequently produced by law enforcement and other government agencies, including the military and national security agencies. Intelligence is evaluated data that has been processed through an intelligence cycle to produce refined data. This intelligence cycle includes planning to obtain supporting information, its evaluation, organisation of information, analysis, dissemination and feedback. The intelligence product produced allows for informed decision-making and action. Intelligence sources are collected through many methods, with the most common being intelligence from humans (HUMINT), open sources such as news media (OSINT) and technical sources (TECHINT). OSINT is available daily from many different sources. However, these sources must be examined for reliability and the information corroborated before being used, preferably through verification from other trusted sources. The protective marking of all intelligence is essential. This topic will be outlined later in this chapter.
The following provides some examples of OSINT and the challenges you may face when assessing it:
Internet Search Engines
Online Maps
Online Communities
Perform the same search across various search engines like Safari, MS Edge, Google, Firefox etc. Usually, different search engines present distinct results. Verify the authenticity of web addresses and compare them with other official sites, such as government ministries, to ensure accuracy and reliability.
This can be a useful source to find information about individuals, but any data found should be treated with caution. Information such as a LinkedIn profile is usually self-generated by individuals and is frequently discovered to be inaccurate.
Check markings to see if maps are to scale. Maps and aerial images can be useful verification tools.
Chat rooms, etc., can be useful sources of intelligence, but again, users have the freedom to fabricate what they say without consequences.
Online Documents, Images and Videos
Personal Data Searches
Government Records
The source of this type of intelligence needs verification with the originator/author. Some sites, such as Wikipedia, are known to be easily hacked, leading to inaccuracies in stated facts. Academic research can provide valuable data but should be verified with the originating source and the academic community, where possible.
Consider the legal requirements for accessing personal identifiable information. If the personal data is publicly available, it is likely not subject to legislation, as the individual may have given permission. However, this should be verified.
This is a more reliable source of open-source intelligence, as you can verify the information with the source through alternative means, such as phone or email, to confirm the data.
Different news media outlets adhere to distinct reporting standards, ranging from practical and factual to sensational and fantastical. Prosecutors should be aware of reliable sources in their country/region and consider any political bias.
It is important to understand that by consolidating several pieces of open-source material, you may end up producing analysis that requires protective marking. In such cases, any information should be marked in accordance with your national guidelines.
Covert or clandestine intelligence is a form of data that requires careful evaluation. Its levels of secrecy vary based on how the intelligence has been gathered. Various sources contribute to this type of intelligence:
HUMINT
Persons providing HUMINT are commonly referred to as ‘informants’. It is paramount to protect both the person who provides the intelligence and the methods used to obtain it.
Obtained During Covert* Operations Through Technical Surveillance Measures
Obtained During Offender Interviews
It is important that the methods employed to gain such intelligence, including police surveillance, listening devices or other technical measures, are not disclosed to others. In certain jurisdictions, full disclosure may be required unless the information pertains to a state secret.
This is similar to HUMINT, in that a suspect may disclose intelligence about other persons involved during an interview. In some circumstances, there will be a need to protect that person as a witness rather than a suspect.
*Covert intelligence is normally gathered by intelligence agencies, law enforcement or the military.
Source Considerations
Cyber or Digital Network Intelligence (CYBINT or DNINT)
Financial Intelligence (FININT)
Technical intelligence (TECHINT)
Monitoring of communications and identification of key words which may be linked to RN-based crime.
Monitoring of financial transactions that can support the investigation of crime planning or commission.
Technical intelligence, or TECHINT, pertains to the technical capabilities of an adversary. It does not fall under a single major branch of intelligence; instead, TECHINT includes elements of measurement and signal intelligence (MASINT).
Measurement and Signature Intelligence (MASINT)
Signals Intelligence (SIGINT)
MASINT is a technical branch of intelligence gathering, which serves to detect, track, identify or describe the distinctive characteristics (signatures) of fixed or dynamic target sources. This often includes radar intelligence, acoustic intelligence, radiological and nuclear intelligence, and chemical and biological intelligence. MASINT is defined as the scientific and technical intelligence derived from analysing data obtained from sensing instruments for the purpose of identifying any distinctive features associated with the source, emitter or sender to facilitate the latter’s measurement and identification.
SIGINT, Signals intelligence, involves intelligence-gathering through the interception of signals. This includes communications between people (Communications Intelligence — COMINT) or from electronic signals not directly used in communication (Electronic Intelligence — ELINT)
The intelligence cycle, also called the intelligence process, is the fundamental method of processing information in an intelligence agency or law enforcement agencies. The stages of the intelligence cycle include the issuance of requirements by decision-makers, collection, processing, analysis and publication of intelligence. The circuit is completed when decision-makers provide feedback and revised requirements.
Planning and direction: The figure below shows how the intelligence cycle works. The starting point is planning and direction. The direction of the investigation should be clearly stated by the most senior decision-maker in the process. In criminal investigations, this is usually the senior investigating officer.
u ation
and Production Dissemination and Integration
Planning and Direction
and Exploitation
Figure 2-1. The intelligence process basic lifecycle of crimes involving nuclear and other radioactive sources
Source: Joint Intelligence / Joint Publication 2-0 (Joint Chiefs of Staff)
Collection: A clear plan for the collection of all available intelligence should be communicated. Consideration should be given to all forms of intelligence, as previously listed. The collection and recording of intelligence are critical so that intelligence can be clearly communicated during the investigation and any subsequent prosecution.
Processing: Once the collection plan is executed and information is received, it is processed for exploitation. This involves the translation of raw intelligence materials, evaluation of relevance and reliability, and collation of raw intelligence in preparation for exploitation.
Analysis: Analysis establishes the significance and implications of processed intelligence and integrates it by combining disparate pieces of information to identify collateral information and patterns. It then interprets the significance of any newly developed knowledge.
Dissemination: Finished intelligence products take many forms, depending on the needs of the decision-maker and reporting requirements. The level of urgency assigned to various types of intelligence is typically established by an intelligence organisation or community. For example, an indications and warning (I&W) bulletin would require higher precedence over an annual report.
Feedback: The intelligence cycle is a loop; feedback is received from the decision-maker and revised requirements are issued.
For each phase of the cycle, there will be certain triggers for prosecutors that indicate intent to cause harm and/or destruction.
This aids in the early identification of offences committed by perpetrators. Prosecutors and the investigating agencies need to establish a close relationship, enabling the sharing of potentially critical evidence and intelligence early in the investigative process.
Prosecutors must establish a good rapport with law enforcement agencies and develop a solid understanding of the nefarious use of RN materials. This will encourage law enforcement and intelligence agencies to notify prosecutors at the earliest opportunity, allowing prosecutors to make judgements and provide guidance on the following:
• When to intervene.
• Offences deemed most appropriate for consideration in the case.
• Points to prove for each offence.
• Key evidence identification.
• Uniformity of evidence collection, recording and handling.
• Differences between what is normally found in the environment and what is unusual.
For effective prosecution to take place, all agencies that could potentially be involved in an investigation and/or prosecution should work together so that they can fully understand each other’s abilities and restrictions. A crime involving RN materials will require a joint investigation, usually including the following agencies:
Law Enforcement
State Security Agencies
Customs/Border Force
Law enforcement may be the first to identify trigger points of such crimes and in many cases, they are the first to notify prosecutors. Prosecutors should strive to build a relationship with senior investigating officers so that both parties have clear expectations about their roles.
In some countries, state security agencies have the authority to investigate high-profile cases. This may result in coordination between them and prosecutors’ teams.
Prosecutors need to gain knowledge of the working practices of Customs/Border staff and their capabilities in detecting and seizing RN materials. This typically includes both fixed and mobile monitoring.
Forensic Institutes
Radiation Protection Agency/Nuclear Regulatory Body
Judiciary
Health
Water
Where can traditional evidence (physical and trace) be analysed? Does the case require specialised analytical services?
Prosecutors need to obtain the advice from relevant experts working in the field of radiation protection and nuclear activities regulations.
What procedures does the judiciary follow concerning the presentation of sensitive intelligence that should not be disclosed in open court?
There can be many challenges relating to data sharing. Patient identity and disclosure of medical history must be agreed upon.
If water sources have been contaminated, how can this be evidenced? What are the implications for the wider community? How can relevant agencies contribute to evidence gathering?
Environment
If RN material has been released into the environment, what are the implications for energy suppliers? Should contingency plans be in place? This is also often a concern for the RN regulatory entity.
Where can prosecutors find subject matter experts who can advise on the implications of a planned or occurring incident? Are the identified scientists suitably qualified to provide evidence as subject matter experts?
What impacts might the RN threat have on animals or livestock? What kinds of mitigating actions need to be considered to prevent damage to the food supply chain?
How badly can the environment be affected by a planned or deliberate release of RN material? How does this impact the wider community, agriculture and primary industries?
Usually, the local authority will be the primary communicator between law enforcement and the general public. How much detail can be shared in these communications? What impact will such communications have on the general public?
Senior policy makers and politicians will need to make decisions on keys elements that may impact the public. The information provided to them must be carefully considered to ensure public safety without compromising key evidence and the integrity of the entire investigation.
The fire and ambulance services will almost always be required to respond to incidents of this nature or be on standby to be able to assist. The statements they supply can be crucial evidence.
If one does not already exist, a joint committee of leaders from the above agencies should be formed as an intelligence working group. This committee should convene at least twice a year to map each agency’s roles and ensure that there is a clear understanding of their respective authorities, responsibilities and restrictions in the event of a joint investigation. The following challenges should be discussed and resolved:
• Which agency should be the lead agency at the start of an incident/investigation?
• At what point should a different agency take the lead, depending on changing circumstances?
• Law enforcement should assume the lead if a criminal offence is suspected.
• Which agencies should form the strategic command group? (This group will analyse daily developments and implications throughout the investigation, making decisions based on a collaborative agreement.)
• How will intelligence be shared?
• How will intelligence be controlled?
All agencies must work together in an effective manner. The most efficient way to achieve this is to meet regularly and practise in joint exercises, whether in real-time scenarios or conducted as a tabletop exercise (TTX). It’s crucial to remember, intelligence must only be shared with those who need to know about it and have the required security clearances. Any breach of such controls should be considered an offence.
As part of the preparation before an incident involving RN materials, prosecutors should establish explicit agreements with those agencies with whom they may need to exchange information or intelligence. These agreements must take into account international legislation, such as the European General Data Protection Regulations of 2016. One effective approach is to develop of a memorandum of understanding (MoU) between agencies and prosecutors.
The development of an MoU as part of the preplanning phase will allow all parties involved to have a clear understanding of the legal framework governing data sharing and how each agency intends to conduct data sharing with other agencies. This can also be a useful method for sharing information or intelligence with other countries. Quite often, these types of crimes are cross-border crimes and may include several countries, each with different standards of data sharing. The standard with the most vigorous measures is the one that should be utilised.
An MoU can be a straightforward agreement between agencies and countries. It must include a clear definition of each other’s roles and responsibilities, along with a list of expectations outlining what each agency expects from the other. The MoU should have a title and be reviewed annually.
In addition, mutual legal assistance (MLA) treaties and conventions often contain provisions for the spontaneous exchange of information which can be relied upon by parties that are signatories.
For example, see Article 18 of the United Nations Convention against Transnational Organized Crime (UNTOC).
The sharing of information can also be facilitated through joint investigative teams (JIT). JITs involve a legal agreement between competent authorities of two or more States for the purpose of carrying out criminal investigations. They are made up of prosecutors, law enforcement authorities and judges.
Two examples of steady-state information sharing focusing on RN materials are the International Criminal Police Organisation’s (INTERPOL) Project Geiger analytical database, published in INTERPOL’s Chemical, Biological, Radiological, Nuclear, Explosive (CBRNE) Bi-monthly Digest. The database contains information about over 4,200 incidents involving RN materials. Information concerning the Geiger Analytical Database can be found at www. interpol.int. The second example is the IAEA’s Incident and Trafficking Database (ITDB). Initiated in 1995, the ITDB is a repository of Member States reporting about RN materials incidents and discovered trafficking. The ITDB catalogues a broad array of information in this area. Information concerning the ITDB can be found at www.iaea.org.
There are likely to be strict rules that apply to the sharing of covert and human intelligence sources. Further consideration must be given as to how that intelligence can be used without disclosing how the intelligence was obtained or who provided it.
Several steps must be taken into account when considering the use of intelligence:
• How sensitive is the intelligence?
• Who can be authorised to access the intelligence?
• With whom and which agencies can the intelligence be shared?
• Are there legal regulations governing the disclosure of intelligence?
To assist you in making these decisions, you will need to implement a system to protectively mark such intelligence and set the vetting requirements of persons who may have access to the different classes of protective marking.
All sensitive information should be protectively marked, while all forms of intelligence must be protectively marked. This will provide a clear indication of who may have access to it. One important aspect to address is whether there are rules governing the protective marking of intelligence in your country or region. Access is usually granted depending on the vetting level of an individual.
The following is a suggested standard, and it is recommended that prosecutors seek to establish a table of equivalence across the countries with which they are working and the agencies involved.
The table below provides a summary of commonly used classifications.
This marking on a document makes it clear that there are no restrictions on who may see it. However, in some instances, a collection of ‘Not Protectively Marked’ information can become sensitive. In such cases, a higher classification should be considered.
This marking is used to avoid the disclosure of information or intelligence beyond a restricted group. This group might encompass all company employees, or it could extend to trusted persons outside an organisation. The information or intelligence is classified as ‘Restricted’ because there is a need to have some form of control over it. This may be to keep the information or intelligence away from competitors or the media.
This is a higher level of control. Persons given access need to undergo some form of basic vetting. Information or intelligence with this marking may be restricted to a specific department or other small group of people. Disclosure of this type of information or intelligence could cause reputational harm, embarrassment or disclose details you do not want others to know.
This marking is used for very sensitive information or intelligence that justifies heightened protective measures to defend against determined and highly capable threat actors. For example, it could be used where compromise could seriously damage military capabilities, international relations or the investigation of serious organised crime. Access to this type of information or intelligence should be restricted to a select few individuals with enhanced vetting.
This is used for the most sensitive information, requiring the highest levels of protection from the most serious threats. For example, it is used where compromise could cause widespread loss of life or threaten the security or economic well-being of the country or other nations. HUMINT is often marked as ‘Top Secret’ to protect the sources who provided it. Only those people who have an advanced level of vetting should have access to this information or intelligence. Those people should be recorded as having access and held to account if the information or intelligence is compromised in any way.
Vetting is a formal process, where the background of individuals, agencies or organisations is investigated to ensure that any joint activity will not compromise the credibility of the original individual, agency, investigation or prosecution. Government prosecutors, identified as suitably skilled to prosecute RN crimes, should undergo the highest level of vetting approval. This ensures that they can effectively communicate with investigators and intelligence agencies. It is up to individual countries to establish what that level
of vetting should be and how it can be achieved.
The following provides a general guide:
Level
None
Although there are no specific vetting requirements, those having access to restricted information or intelligence should be known to the issuing source. They could be staff or established, well-known contacts. Basic
Basic verifications should take the form of a police record check and for the individuals to provide evidence of who they are through the submission of essential identification documents, such as photo identification, proof of address, proof of earnings and other basic measures. This information should be verified against public records.
Enhanced
Advanced
An enhanced check requires more information to supplement the basic vetting. This could involve an interview, scrutiny of financial records, and other measures. The aim is to ensure that the person is psychologically stable, maintains a reliable lifestyle and is not susceptible to bribery or blackmail. These checks should be conducted at least every five years.
This is the top level of vetting and should involve a comprehensive and regular process. All the above measures should be taken, as well as a comprehensive questionnaire and interview to assess all aspects of the subject undergoing vetting. Ideally, this should be an ongoing process to continually update information about the individual’s welfare and personal circumstances.
The following table summarises security considerations related to protective marking and the required level of vetting.
Protective
Not Protectively Marked None No
Hardcopy and electronic documents should be held under basic security conditions, such as in a locked office or on a computer with an appropriate firewall.
As above but kept in a locked cupboard in a locked office with encryption on computers and only held on restricted-use computers that are password protected.
Must be retained under strict security conditions. Hard copy documents should be held in a file with a list of those who have accessed the data. Computers should have enhanced security measures and should not be accessible from outside the organisation with ownership.
Top Secret Advanced If held on a computer, it should be a standalone computer without access to the Internet, Wi-Fi, etc. Documents should be encrypted and password-protected, allowing for an audit trail of who has had access. Hard copies are not ideal and need to be managed carefully to ensure that only those with authorisation have access.
Most countries have rules governing the disclosure of evidence to the accused and their legal defence team. When the evidence includes sensitive intelligence, consideration must be given as to what benefits will result from disclosing such intelligence as opposed to the possible harm that could occur given how the intelligence was obtained, who obtained it and national security issues deriving from the disclosure.
Prosecutors often cite national security as the reason for an exemption from disclosure laws, but this is usually tested by the defence. Prosecutors need to be aware of and briefed on the specifics of disclosure laws and the tests that are made in relation to exemptions in the interest of public safety.
For example, in September 2015, the Court of Justice of the EU ruled that information about the volume of hazardous chemical substances being manufactured or imported posed a security and environmental risk. The Court ruled against the disclosure of such information.
Disclosure extends beyond evidence to any material generated during an investigation that may have some bearing on any offence under investigation, any person being investigated or the surrounding circumstances.
Disclosure regimes will vary from one jurisdiction to another but ordinarily require the prosecution to provide the defence with copies of, or access to, any material that might reasonably be considered capable of undermining the prosecution of the accused or of assisting the case for the accused, and which has not previously been disclosed. Generally, prosecutors must disclose relevant prejudicial and beneficial information to the accused as soon as reasonably possible in accordance with the law or the requirements of a fair trial.
Disclosure issues are usually resolved by the trial court, either through preliminary applications or during the course of the trial. Disclosure issues are often critical in cases involving highly sensitive information and intelligence. If a fair trial cannot take place without disclosure of such material or cannot be remedied by either formal admissions, amending the charges or presenting the case in a different way to ensure fairness, the prosecutor cannot continue with the case.
In some jurisdictions (e.g., the UK), the consequences of non-disclosure are severe and may result in a stay of proceedings as an abuse of process, the exclusion of material evidence, a successful appeal or a costs order against the prosecution.
Some systems permit an application to the trial judge (with or without the defence present) to withhold material from the defence because there is a real risk of serious prejudice to an important
public interest. Generally, if the court decides or, without an application, the prosecutor is satisfied that a fair trial cannot take place without disclosure, the case cannot continue.
Freedom of information laws allow access by the general public to data held by national governments and other public bodies, such as state and local governments. The emergence of freedom of information legislation is usually associated with the need for authorities to be open and transparent. In some countries, this is referred to as an access to information act or similar. Freedom of information and data protection legislation ordinarily include exemptions for data relating to the commission, or alleged commission, of an offence and the investigation and prosecution of such offences.
This type of legislation establishes a ‘right-to-know’ process by which requests are made for government-held information to be received freely or at minimal cost, barring standard exceptions such as national security and sub judice (or under trial), whereby the information is relevant to an ongoing investigation or legal action such as a prosecution. Governments are typically bound by a duty to publish and promote openness. In many countries, there are constitutional guarantees for the right of access to information; however, these are usually unused if specific support legislation does not exist. Additionally, the United Nations has a target to ensure public access to information and the protection of fundamental freedoms to ensure accountability.
For example, Georgia has a Law of Freedom of Information regarding information that a member of the public has a right to know. Standard exemptions apply, including cases related to national security or ongoing legal proceedings.
In Europe, the General Data Protection Regulation, (EU) 2016/679, (GDPR) sets a standard for the use and security of personal data. This pertains to any data that can identify an individual, including email address, images and other contact details. Protecting personal data involves four key objectives:
• Accountability: the individual holding another’s personal data is accountable for all compliance issues and must be able to demonstrate this.
• Lawfulness: if the personal data of another person is to be shared, it must be conducted on a lawful basis and often with the person’s permission (there are exceptions to this).
• Fairness: this means that the data holder should only share the data of other persons in ways they would reasonably expect. For example, if you have acquired their data through means that are misleading, subsequent action (whether you think it is lawful or not) is unlikely to be considered ‘fair’.
• Security: the data holder is responsible for ensuring that personal data is held securely and that it is not lost, stolen or compromised.
The requirements for data protection vary among countries. All intelligence must be protected, but this is of paramount importance when handling evidence and intelligence during the prosecution of an incident. Security measures will depend on the nature of the data.
In the case of electronic data, advice from a cyber security expert should be sought. As a basic requirement, data should be encrypted and maintained with a level of protection commensurate with the sensitivity of the data. The most sensitive data should not be retained on any computers that can be accessed via the internet. Backup copies should be maintained on a secured hard drive that is kept in a good-quality safe.
If less sensitive data is stored on a computer that is connected to the internet, an appropriate firewall is essential. This will need to be updated regularly, as will antivirus software and the computer operating system.
Hard copy data is often more vulnerable than electronic data. All documents should be protectively marked and staff who have access should be provided with document handling instructions so that they are fully aware of their obligations to protect such data. Where sensitive hard copy data is in frequent use, it is normal to have a requirement to lock documents away in a designated secure location with controlled and logged access. This is often supported by a ‘clear desk’ policy whereby employees are required to keep their desk clear of documents when they are not present.

CHAPTER THREE

Before the Investigation: Preparing for Crime Utilising Nuclear and Other RN Materials
Investigative Operations Involving RN Materials References 3.1 3.2 3.3 3.4
Investigative Use of the RN Expert
Preventing Crimes Utilising RN Materials
The risk of non-military chemical weapons attacks on a civil population thrust itself on the world on March 20, 1995, when Japanese domestic terrorists connected to the Aum Shinrikyo cult released sarin in the Tokyo, Japan subway system. It is lore in the US Federal Bureau of Investigation (FBI) that the FBI’s hazardous materials investigation capability began that day. The then-director, Judge Louis Freeh, while watching news coverage of the Tokyo incident, asked his senior staff, ‘We can handle something like this, right?’, a question perhaps asked at the same moment at police and security services headquarters around the world. In the US, the immediate answers are thought to have been less than confidence-inspiring, and the FBI Laboratory Division’s Hazardous Materials Response Unit was up and running by 1996.
Before the 1995 attack, national security and law enforcement agencies faced challenges in allocating resources to this crime area. This difficulty stemmed from the common assumption of the low probability of a chemical attack. After all, the thinking went, yesterday we had murders, counterfeiting, fraud, car theft, etc., but no chemical attack. Therefore, there will be no chemical attack tomorrow. This reasoning worked very well as policy until it did not. The modern challenge is that the offender community has learned that the use of chemical, biological, radiological and nuclear (CBRN) materials in their schemes increases attention, inflicts more extensive damage and results in higher casualties
than more conventional incidents. The use of sarin in Tokyo, and the resulting deaths, illnesses and lawsuits exceeding three billion yen, assessed as an economic measure, has led to the modern consensus that CBRN crimes, while having a low probability of occurrence, have a high impact, making them worthy of heightened attention.
In 1995, military professionals worldwide had significant institutional knowledge and capabilities concerning the offensive use of CBRN materials. Police services routinely handled unintended chemical spills on roadways. Fire brigades typically had and have the responsibility for CBRN emergencies throughout civil districts. Governmental involvement in environmental care had decades to develop by 1995, and environmental protection ministries, departments and agencies were available in many States as a resource. Many police and security services worldwide used these partners to grow and/or develop programmes to fulfil their traditional mandates in light of the added challenge of CBRN materials. Integrating these new capabilities with existing explosive programmes was an obvious step generally taken.
No State today has a single ministry, department or agency that is solely responsible for all facets of non-warfare, civil CBRN criminal use. In fact, it is an international best practice to recognise that no one ministry, department or agency has such a mandate. A successful government in this area is successful through inter-ministerial partnership and teamwork, the ‘whole of government’ approach. Therefore, the prepared prosecutor and investigator must bring a team mentality to the challenge. Prior to an interrupted or executed attack, prosecutors and investigators may find themselves in the position of sharing information and threat assessments. When CBRN materials are in play, either
through being discovered prior to malicious disbursement or in the unfortunate event of a successful attack, prosecutors and investigators are merely one facet of a competent governmental response.
That response must accomplish many objectives. Fire brigades, public health entities and environmental protection ministries must mitigate the danger and return public life to normal as rapidly as possible. Military and intelligence services must concentrate on international threats. Prosecutors and investigators must address the likelihood of a follow-on attack and demands for justice. While doing so, prosecutors and investigators must remember that they are part of the emergency management response run by emergency managers. Of course, at the time of a judicial prosecution, the prosecutor is representing the government, and it is the prosecutor’s turn to expect wide inter-ministerial support, but this often comes months or even years after an incident.
The goals of law enforcement agencies in RN investigations are typically as follows: the first goal is the protection of public safety. This objective includes the prevention of the use of RN material in a terrorist or other type of attack that causes harm to the public.
The second goal is the protection of law enforcement and other government personnel. Law enforcement personnel are likely to encounter radioactive material and contamination during their operations. They must take precautions and wear appropriate PPE to avoid contamination. Law enforcement personnel may not have thorough knowledge of all radiation hazards and will rely on trusted scientific expertise while conducting operations.
The third goal is the prevention of criminal acts. Through assertive investigation, law enforcement personnel seek to identify and neutralise criminals involved with misusing RN materials, thereby frustrating primary and potential follow-on attacks.
The fourth goal is for law enforcement organisations to support the attribution process. Law enforcement personnel play a key role in supporting the search for the point of origin of the RN material sought or obtained by the suspects.
Lastly and traditionally, law enforcement professionals seek to identify, apprehend and prosecute the perpetrators. A criminal investigation into a crime or terrorist attack using RN materials is not complete without a successful prosecution. Often, this facilitates the national goal of the victim state.
Setting up a ‘whole of government’ CBRN capability is outside the scope of this guide, as is the inter-governmental role of the prosecutor, nor is this a manual on counter-terrorism. That said, there are three important general points to highlight before we delve into a discussion of the specifics of a countering CBRN attack investigation:
• Prevention is key. In 2001, in the US, a single suspect introduced Bacillus anthracis into the national mail system, murdering seven victims and assaulting fifteen more, leaving many with chronic health problems and causing USD 4 billion in economic damages. He did this with five known mailings of spores, which he grew from a personal research supply. Clearly, the lesson is to prevent the malicious disbursal of CBRN materials rather than respond such incidents.
• History has shown that when a CBRN plot is connected to terrorism, there is a planned follow-on attack, with CBRN material outside of regulatory control present to support it. Therefore, upon receiving news of an active CBRN threat vector or attack, the professional prosecutor and investigator immediately focus on all extant CBRN material, ensuring its return to regulatory control and preventing that follow-on attack.
• Investigative tasks must not interfere with life-saving operations, even to the extent of loss of evidence and/or corruption of the crime scene.
As the 1995 Tokyo incident taught the world, preparation is essential for an effective governmental response, and this is true regarding incidents in which nuclear and other RN materials have been exploited for nefarious purposes. Prosecutive services should prepare ahead of the emergency by always assigning the CBRN prosecutive mission to an active prosecutor. Ideally, this can be full-time. Often, resource allocation and active prosecutorial demands prevent a full-time assignment. At a minimum, an active prosecutor should have the countering CBRN materials mission and have the time to conduct non-prosecutive related activities, mostly in policy, liaison and exercise lines.
It is in the best interests of the CBRN prosecutor to ensure access to CBRN-trained investigative resources prior to the onset of a CBRN threat. Ideally, investigators with CBRN responsibilities have previously been assigned to more active crime areas before transitioning to CBRN, given its low offence rate, to acquire investigative skills.
How are investigators trained? Some hold that investigation can be taught, while others believe that only investigative techniques can be taught, and at their core, successful investigators have two traits in common: curiosity and common sense, neither of which can be taught. Either a person has them or not. Regardless, it is hoped that the CBRN designated prosecutor will be supported by experienced and trained investigators.
It is common knowledge that police and investigative services routinely assign investigators to crime areas: car theft, burglary, homicide, organised crime, terrorism, etc. A good rule of self-evaluation for the responsible CBRN investigator and prosecutor is this: when CBRN materials are in motion, or an expert in CBRN material(s) is on the move, the CBRN investigator and prosecutor should be as well.
CBRN investigative staff should work hard to cultivate competence in three important areas of CBRN investigations:
• Access to pertinent experts to deliver threat assessments based on what the investigation has revealed to date. This may concern RN material that criminals are safeguarding but have not released into the public, or it could be postincident.
• RN material search and detection capabilities, both overt and covert.
• The handling of RN material as evidence, that is, its collection, transport and storage, consistent with evidentiary requirements in your jurisdiction.
These three capabilities are the bare minimum required for a credible CBRN material investigative programme.
Additional capabilities, while equally critical, may be the responsibility of the investigating agency or the responsibility of the prosecution service. Some States have independent forensic services. Regardless, it is an international best practice to organise these capabilities prior to a breaking investigation. They are:
• Forensic services
• Collecting RN material at a crime scene for identification and origin determination purposes.
• Collecting contaminated traditional evidence; traditional evidence being defined as usual evidence collected, e.g., fingerprint, document, DNA, blood, tool & die marks, ballistic, hair, fibre, etc., and hereinafter referred to as ‘traditional evidence’.
• Transportation and safe, legal storage of both.
• Forensic analysis of traditional evidence that has become contaminated, including proper lawful storage.
• Reporting: a forensic report on RN material that is prosecutively usable.
• RN material forensic expert testimony in support of the aforementioned forensic report.
The ability to conduct forensic analysis of traditional evidence that has become contaminated is a complex and costly area of expertise to develop. While a state is considering that course of action, developing international relationships that will allow
assistance in this area from an international organisation or a close State that maintains such a capability may provide an interim solution to the challenge. If pursuing this course, do not overlook the challenge of transporting contaminated items over state frontiers.
A note regarding RN material evidence and trial practice: prosecutors will not be able to bring most RN material into court. Due to the extant threat to human health presented by many RN materials, prosecutors will not have the opportunity to show a jury or judicial panel the material the same way they might a firearm, seized cash or narcotics, for instance. The evidentiary aspects of the case rest solely on the report and the expert witness acting as the foundation and presenter for it. Additionally, a comprehensive photo and video documentation portfolio will be very supportive.
The prosecutive community’s representatives should regularly review RN forensic capabilities, RN expert witness arrangements and training and evidence collection, transport and storage practices on an annual basis. Prosecutive input is extremely important and avoids the challenge of programme development on the eve of trial. Investigators should stand shoulder-to-shoulder with prosecutors in these initiatives so that investigators know prosecutors’ expectations and demonstrate a unified voice between prosecutors and investigators on the subject.
An expert is a person with special knowledge, skills and experience beyond that of an ordinary person in a particular discipline. An expert witness is an expert called to court to testify concerning matters at bench in the discipline in question. The presence of RN materials in given criminal activity make RN crimes specific crimes unto themselves, different from ‘ordinary’ crimes in many respects. As very few prosecutors and investigators qualify as RN experts, prosecutors should prepare ahead of time to call on the skills of known RN experts, who, in addition to testifying, may also be invited to carry out RN expert examinations of crime scenes, evidence and prepare conclusions, when necessary, in criminal cases.
Prosecutors may categorise RN experts into one of two broad categories: professionals specialising in field activities, such as RN search, the rendering safe of RN connected explosive devices and evidence collection, transport and storage; and professionals specialising in RN forensics, often working in the laboratory environment. Professionals working in both areas may be qualified as experts in both areas, and may be called to eventually testify as such. Prosecutors can expect their first communications regarding RN materials in their case may come from CBRN first responders. Overall, expert witnesses and their conclusions are the keys to a successful investigation and prosecution. While experts may be invited by the investigator or prosecutor to conduct an examination, the defence may have its own experts, too.
Pre-incident, investigation and prosecution communication with identified experts who would then be contacted to support investigations and prosecution is an international best practice. It is highly recommended to establish agreements on policy, operational methods and testimony methods before there is an operational need for such determinations. Investigators and prosecutors are generally not scientists, and of course, they do not have special knowledge and experience about RN materials, so they should be open to communication from scientists regarding clarifying the details of, and support to, the investigation to facilitate further effective steps and activities that may not be readily apparent to non-scientists.
Prosecutors should contribute to policies regarding the collection, packaging, transport and storage of evidence displaying a higher than background level of radioactivity. This proactive involvement ensures the admissibility of such evidence to support investigations and prosecutions. As the physical evidence – RN materials – cannot be physically displayed in court, expert testimony is very important for a successful prosecution. This is why experts (both field and laboratory staff) should be very well prepared for hearings and trials. Successful testimony is not only about providing correct answers, it requires confidence in those answers. Given the infrequent occurrence of RN crimes, scientists may not be accustomed to attending court, making them less experienced as witnesses compared to experts in traditional forensic fields like ballistics. Witness preparation is key.
The initial step involves familiarising scientists with court practice. After explaining the routine court processes, it is crucial to outline the types of questions that RN experts will be asked. These inquiries include education, speciality, length of service in the given
speciality, academic degrees and titles, place of employment and position, as well as their knowledge, skills and experience — all of which are essential to prove their qualifications. There will also be general questions about their concrete expertise, such as the methods and laboratory equipment used, how material is delivered to the laboratory and unpacked, and final conclusions. It is imperative to articulate, in front of the judge and jury, the potential harm RN materials can cause to both people and the environment.
Moreover, a significant challenge in RN crimes is that scientific language is not easily understood by investigators, prosecutors, judges and potentially, juries. When prosecutors bring cases to court, they must understand the circumstances and specifics of the RN case to the level of being able to effectively explain them to others. It is essential to convey to the experts the importance of using simple language in the courtroom, avoiding scientific jargon. If scientific terms are used, their meanings must be explained. Practicing testimony beforehand is an effective technique to both ensure the expert will be understood by the intended audience, and to verify the prosecutor is ready, as well.
Lastly, RN expert witnesses should be informed that they may face challenges from the defence during cross-examination in several ways. Opposing counsel can be expected to challenge the veracity, qualifications and capabilities of government experts, attempt to confuse them, get them to contradict themselves and get them to admit flaws in the prosecution’s case. All these eventualities and supporting defence techniques must be explained thoroughly, even those that seem very simple for prosecutors. This is particularly crucial because most prosecutors are accustomed to working with ‘traditional’ experts who have not only survived this process in the past, but for whom it may be quite routine.
There is also a legislative challenge. In some countries, legislation does not allow prosecutors to communicate with their ‘called’ witnesses, referring to those identified for participation in the trial, before going to court. In this situation, prosecutors and investigators are unable to receive support from these experts during the investigation, and experts cannot seek support from the prosecutors prior to hearings. As RN crimes are highly technical and require collaboration among prosecutors, investigators and experts, one solution to this problem is to conduct training, workshops, moot courts, etc., for all participating professionals regularly, ensuring an identified pool of RN experts available to the prosecution.
Preventing the dispersal of CBRN materials is infinitely more efficient, from a public safety perspective, than responding to such an event. A professional CBRN investigative programme embraces the concept and acts accordingly. Since the prevalence of RN material in criminal justice mission streams is not as common as, say, illegal narcotics, and the primary goal is prevention, operations laying the foundation for effective prevention are worth the resources needed to achieve that goal. Because CBRN crime does not occur that often (the ‘low probability’ observation), a CBRN investigator should prioritise prevention programmes. The CBRN prosecutor should be knowledgeable about these programmes and be in a position to both review and assist in them.
The primary liaison for investigators supporting prosecutions is with public safety and security colleagues. Regular interactions with fire brigades, environmental protection responders, public health professionals, emergency managers and others are essential. At the same time, this liaison objective will greatly facilitate response operations to incidents including the active dissemination of RN material. While investigators must train with the first responder community, investigators and prosecutors must also make time to participate in the drafting of policy as well to ensure that investigation and prosecution needs are met. This, too, is a form of liaison.
To facilitate both the prevention mission and the prosecutive support mission, regular liaison with the RN community, that is, industry, academia and scientific professionals, is essential. For crime involving RN materials to occur, criminals must have access to such materials. They may bring RN materials into a State from outside or may convert RN material within a country for improvised nefarious use. As an international best practice, the biggest return on investigative resource investment is professional liaison with colleagues who hold RN materials.
The primary goal here is not to collect information about colleagues but to establish a familiar presence among professionals within the investigating entity and the practical contact information for reporting issues of concern as they occur. Through professional conduct, investigators must motivate their liaison contacts to develop a high level of trust and confidence in the investigative agency and the investigators themselves, leading the liaison contacts to trust that any information provided will be dealt with at the appropriate level of confidentiality, tact, diplomacy and concern. Professional investigators know the importance
of ensuring that information sources have confidence that any information about missing RN material or colleague conduct will be handled with the highest level of privacy and discretion. Liaison contacts should be cultivated across various industries, including those where radiological sources are present. This includes the nuclear power sector and the medical community, due to the plethora of RN materials present and academia, where RN material may be present, for scientific expertise and for potential early warning of sector activity of concern.
Joint training and exercises are a type of prevention programme. Investigators holding primary authority in CBRN crime investigations should participate in exercises and joint training. Prosecutors should encourage this investigative involvement. Failure in this regard leads decision-makers, prosecutors and investigators to invest in whatever agency investigators show up for the training or exercise, as opposed to the agency with the proper authority. This creates confusion during the onset of an emergency resulting in precious time being wasted to resolve the situation.
Active liaison, coupled with training, leads to creativity in the creation of further prevention programmes. A significant area ripe for prevention programmes is precursor materials. Where choke points occur in the creation of certain CBRN materials, voluntary guidelines as to when suppliers might consider calling known CBRN investigators with information, such as in the event of irregular orders, might be an effective prevention strategy. Specifically regarding RN materials, establishing liaison with the regulatory agency and industry will lay the groundwork for effective prevention programmes.
Any threat to public safety involving CBRN materials understandably causes considerable stress at political and authority levels, often efficiently transmitted down the hierarchy. Field investigators and first-level leadership may choose to remember this philosophical guidance: evaluate all CBRN threat information through three key measures:
• Suspect resolve
• Technical feasibility
• Operational practicality
Suspect resolve may be plainly defined as the effort that known suspects bring to their criminal scheme. Investigators should continually evaluate the criminal group, considering factors such as the effort expended, the displayed sense of urgency, criminal ‘professionalism’, and other relevant criteria. When law enforcement behavioural specialists are available, this is the time to consult them – a valuable investigative step. The FBI’s Behavioural Science assessment of the unknown subject in the 2001 anthrax investigation, which was internally published days after the case opened, turned out to be remarkably accurate when the subject was identified years later.
The ‘whole of government’ approach was discussed earlier. When assessing the technical feasibility of a suspected or known criminal scheme regarding RN materials, proper scientific and technical specialists must be consulted. This cannot be done in the absence of proper liaison and pre-event planning. Technical feasibility is simply the question: will it work? Experts use available information to assess the effectiveness of the apparent criminal plan. As new information is developed, the analysis is updated and may also be shared as necessary. It would be prudent for emergency managers to initiate mitigation procedures or, at the very least, plan for them.
Operational practicality assesses whether the known conspiracy, attempt or scheme is more or less likely to be successful overall. Experienced investigators and other experts should assess their body of knowledge and develop an opinion based on known information, to include conclusions regarding suspect resolve and technical feasibility, and then act accordingly. For those with real-world tactical experience, be it in military or law enforcement circles, the golden rule of ‘Keep It Simple, Stupid’ (KISS) is well respected. Overly complex plans fail at the same rate for terrorists as they do for soldiers and police officers. Law enforcement officers need to be in a position to exploit adversarial failures as they are detected to prevent the illicit use of RN material.
This guidance can be kept in mind and deployed informally, but many States have formal binding procedures to implement this or similar methodologies when necessary. Prosecutors should endeavour to be a part of the process.
How does the prevention-orientated RN investigation initiate? It may start with intelligence collected by those services with domes-
tic and/or foreign responsibilities or through police intelligence services. It may commence with a liaison contact confidentially reporting a situation that does not ‘feel right’. It could originate from the RN regulatory agency, formally or informally. Regular radiation monitoring could detect an anomaly. And lastly, of course, it may come from a ‘tip’. The goal of law enforcement personnel with RN crime responsibilities is to detect and interdict RN materials as early as possible. When the information identifies suspects, experienced investigators know what to do. When it does not, perhaps the first step is the RN materials search.
The first and often the most common investigative technique is the interview. For example, investigators will conduct logical interviews with individuals such as witnesses, tipsters and those associated with allegations of missing RN material. Interviews and the resulting reports are frequently the foundational elements of the investigative case file. This process will formalise the information provided and define the known threat at that moment. These initial interviews define the investigative landscape and trigger other investigative steps, which may include information gathering. The most important variable in this phase is the location of the RN material intended for use in the criminal scheme.
In this initial stage, when there is no evidence of RN material outside of regulatory control, investigators should conduct an expedited review of information that has a high likelihood of leading to the discovery of RN material outside of regulatory control. At this stage, this may involve reviewing recent fixed portal monitoring data, examining RN material inventory, and conducting interviews with regulators and industry custodians. A thorough examination of open-source information should be considered a required step.
These initial investigative steps often reveal a population of suspects, and even if not, there may be a pool of persons of interest to the investigation. More on that in a moment. If suspected persons are not identified, authorities may wish to conduct RN material searches. It is important for investigators and prosecutors to note that RN search capabilities are consumable and require rest and restoration after use. Ordering large-scale discretionary RN material searches will exhaust a State’s search capability and necessitate a rest and maintenance period before subsequent availability. This may not be a common-sense course of action when credible threat information has been received, but neither proven nor disproven. A possible and even recommended solution may be a smaller-scale, focused search.
Again, to emphasise the point, investigators should not concur regarding search operations that exhaust the search capability at this stage of an investigation and instead make the argument that some search capability needs to remain in reserve should the continuing investigation provide actionable information in the near term.
Another key point regarding the RN search is that it is usually left to the prosecutor to secure legal justification for searches under appropriate conditions. For instance, in some jurisdictions, a search warrant or other judicial review is required when a law enforcement agency intends to take kerbside RN readings from a specific, identified and known location. Prosecutors should be familiar with the processes used to obtain search authority under these conditions.
However, the operational landscape changes when the initial stages of an investigation yield identified suspects, and the full
suite of investigative techniques become available. At this juncture, no lawful stone should be left unturned in the quest to prevent the release, disbursal or detonation of RN material that pose a threat to public safety.
Techniques may include some or all of the following:
• Tasking human sources/agents.
• Additional interviews with witnesses or other relevant persons.
• Physical and technical surveillance of suspects.
• Undercover/low-visibility RN material search and detection operations.
• Undercover operations where lawful and appropriate.
As a credible threat of an attack using RN material draws considerable political attention, swiftly communicated to police command authorities, ample resources are likely to become available for concurrent deployment of these sophisticated investigative operations. This includes the surging law enforcement personnel, other government personnel and the required equipment. A brief discussion of these techniques follows.
Persons who regularly assist sworn law enforcement personnel in investigations are commonly referred to as confidential human sources (CHS), a term used throughout this Guide. They are confidential because the police agency may seek to protect their identity for a variety of lawful and practical reasons. The
term ‘human’ indicates that the person is providing investigative human intelligence, or HUMINT, as discussed in the previous chapter, and is an intelligence ‘source’. ‘Tasking’ involves initially inquiring of the existing CHS base if they are aware of anything related to RN material, no matter how vague such awareness may be. Following this initial query, investigators will determine whether an existing CHS can be directed to the threat stream. In certain situations, the recruitment of a specific CHS may be deemed necessary.
Interviewing is a constant investigative activity that continues until all logical investigative steps have been taken, resulting either in the capture of the RN material outside of regulatory control, the arrest of suspects and the resolution of the threat; or, conversely, the negative investigative results allow for the matter to be declared closed.
Once suspects have been identified, a full suite of surveillance capabilities will be employed. This may include physical surveillance in all its forms, electronic surveillance concentrating on digital communication such as email and direct messages, and RN material search surveillance at the appropriate level. An increasingly important area in surveillance is social media monitoring. If the threat can be resolved merely by observing the boasting of a suspect on a social media platform, then so be it.
Undercover/low-visibility RN material search and detection operations refer to the capability of scientifically searching for RN material outside of regulatory control without alerting suspects to the search operation or that a search has occurred. Searching in this manner allows for a full investigation without triggering a sudden attack before the perpetrators are ready. It can be argued
that the hasty execution of this type of attack can pose an even greater threat to public safety than a planned attack. For example, terrorists may be targeting a military base in a rural location with an RDD but constructing the RDD in a metropolitan commercial district. A hasty detonation in the metropolitan commercial district may expose more victims and property to unsafe levels of radiation. The undercover/low-visibility RN material search capability is an important part of a national programme, and if it does not already exist, prosecutors should advocate for its establishment.
Undercover investigative operations should be considered where lawful and appropriate. The undercover investigative operation consists of introducing a sworn police officer into a criminal or terrorist scheme using a false identity and false bona fides. As such officers are introduced under the cover of these fictions, they are referred to as ‘UC’ personnel, thus the acronym. The effective operational use requires the UC to be provided with clear goals and objectives, rules of engagement and contingency plans. The UC should frequently meet with a supervisory point of contact for information exchange and an operational review. Frequent operational evaluations are an undercover investigative operation best practice. Properly executed, the undercover investigative operation is the most efficient investigative modality available, with the tasking of a CHS coming second.
Undercover investigative operations are not to be taken lightly. The UC should be evaluated and thoroughly trained prior to deployment. The creation of usable ironclad bona fides, often referred to as ‘backstopping’, are essential. The UC must be operationally supported with an active safety and security plan, and in the case of CBRN materials, a hasty hazardous materials mitigation plan. Final goals and objectives must always be kept in mind and
supervisors should be thinking of the resolution, takedown and resulting prosecution from the very beginning of the operation.
Normal, sophisticated investigations are large, complex endeavours. When one considers the addition of CBRN material and the ‘whole of government’ approach, effective leadership and organisation become critical. From the beginning of the RN materials investigation, it is recommended that investigators conduct joint investigations with other experts, such as scientists, by applying a risk-based approach (RBA). The RBA is a systematic process used to identify and mitigate threats encountered during the investigation. The RBA process is used to reduce risk and generally includes four phases: analysis, planning, implementation and evaluation.
The first phase of the RBA process entails analysis, during which competent authorities receive intelligence and investigative information for analysis when RN material is outside of regulatory control. The source of this information could be a confidential human source, technical coverage, mechanical detection or the execution of a legal search. Information must be analysed continuously and investigative goals and objectives adjusted accordingly.
The team may choose to document the planning phase with an investigative plan (IP). The IP should include goals and objectives along with a selected course of action to detect and interdict suspected RN material in a safe and legal manner. Investigative objectives may be achieved through investigative techniques that are authorised with approval from the prosecutor, where necessary. Techniques approved by the prosecutor will carry a degree of risk, encompassing the safety of personnel or the potential compromise of the investigative technique. Prosecutors should
work with experienced RN-trained investigators and forensic scientists, who understand the nature of the investigative process.
During the implementation phase, the IP is put into operation. The investigative team must be briefed on their roles, responsibilities and safety in and around RN material. The chosen course of action may be adjusted as the investigation reveals more information, subjects, locations and potential crime scenes. The implementation phase includes the interdiction of RN material, the arrest or disruption of criminal activity and the execution of search warrants to obtain additional evidence. Depending on the legal system, the implementation phase will conclude with the judicial process for the criminals and the disposition of evidence, including the mitigation of the RN material seized.
Because of its importance, the evaluation phase affects all phases. It is a continuous process that may necessitate altering the IP and chosen courses of action as new facts emerge. In jurisdictions where prosecutors are not responsible for investigative oversight, it is not unreasonable for them to receive regular briefings, including regarding standard procedures, especially if a modification is required.
Termination is the final phase, during which arrests may occur, crime scenes may be transferred to qualified contractors to clean up any remaining hazards and information may be disseminated to interested parties and even the public. Prosecutorial concurrence with these resolution activities should be a requirement in the IP. The case file should be complete and all evidence must be safely and securely stored, adhering to necessary handling protocols.
A radiation exposure device attack presents a unique challenge, in that it will present in form as a biological organism attack. The first sign of mass exposure will be individuals with radiation sickness seeking treatment within the healthcare system. The benefits of adopting and putting in place a joint criminal–epidemiological (Crim-Epi) investigative method cannot be overstated. The Crim-Epi model enables seamless collaboration between the public health establishment and criminal investigators, allowing them to efficiently pursue joint goals while respecting their distinct needs. Through effective pre-planning, investigators and prosecutors have access to public health experts, formalised information-sharing protocols, joint threat assessment expertise and joint investigative processes. This includes joint interviews of victim witnesses and other witnesses. Real-world experience shows that this methodology leads to much faster and more accurate investigative results compared to when public health agencies and the police work separately.
While the overall threat of crimes involving CBRN materials outside of regulatory control is low, their impact is high. Therefore, the nefarious deployment of CBRN materials presents a major challenge to any law enforcement organisation and any government. In individual cases, international assistance may be sought. Bilateral relations, group membership and international organisations are a source of support in this unfortunate eventuality. The multi-national Joint Investigative Team concept is discussed further in Chapter 6.
Two such examples of international investigative assistance are the INTERPOL Incident Response Team and the EU Agency for Criminal Justice Cooperation (EUROJUST) Joint Investigation Team Network. INTERPOL, known for its secure communications
system and coloured notice service, also provides specialised police services. Through its Chemical, Biological, Radiological, Nuclear and Explosives and Vulnerable Targets Sub-Directorate, it can provide specialist assistance to an RN materials investigation through an Incident Response Team at the request of a member country in need.
A EUROJUST JIT is an investigative response that empowers police and judicial authorities from two or more States to form a team to conduct an active investigation in one or more of those States. JITs are formed for targeted investigations, and team members are free to investigate and share investigative results. A legal framework exists, as does a JIT network, allowing for rapid JIT formation and certain operational postures. Seconded JIT personnel are equals, allowing for investigations unhindered by international formalities. EU Member States have an appointed JIT national expert who can be contacted to request support and initiate the JIT creation process.
In conclusion, RN crimes are low-frequency, high-consequence events. There is a public perception of the threat posed by RN material, both real and imagined, that creates additional challenges around an active RN material incident. The cases are complex and broad, requiring extensive pre-incident planning and an investment in expertise. No one single ministry, department or agency can handle an RN materials matter alone; a ‘whole of government’ approach is necessary. Investigative techniques are in place to meet this challenge, and international support is possible. Prosecutors will be under great pressure during the investigation, and it is reasonable to expect that complex investigations lead to complex trials.
1. https://www.Interpol.int
2. https://www.eurojust.europa.eu/judicial-cooperation/practitionernetworks/jits-network
3. The Joint Criminal-Epidemiological Investigations Handbook, Domestic Edition, FBI and CDC, Washington (2018).


CHAPTER FOUR

Nuclear Forensics
Challenges of Collecting and Processing Evidence
Expanded and Novel On-Scene Roles and Responsibilities
Post-Blast Investigation
Nuclear Forensics and Legal Requirements for Forensics Expertise
Model Action Plan
Laboratory Examinations and Facilities
Case Examples
References

This chapter introduces nuclear forensics, an element of a broader investigation into incidents involving nuclear or other radioactive (RN) materials encountered out of regulatory control. In addition to the RN material itself, these incidents often entail evidence contaminated with radionuclides. In this context, the phrase ‘out of regulatory control’ describes a situation where RN material is present in sufficient abundance that it should be under regulatory control, but control is absent. An investigation into the loss of RN material from regulatory control may have legal, regulatory, and national security implications.
Chapter Four begins with a description of nuclear forensic science, commonly known as nuclear forensics. It then delves into the challenges of collecting and processing evidence containing nuclear or other radioactive material, with a special emphasis on the complexities associated with investigations following explosions or bombings. Legal requirements associated with nuclear forensics are considered, as are the potential needs for specialised laboratory support that may surpass a State’s existing capabilities. Chapter 5 continues the discussion in more detail.
Nuclear forensics is the examination of nuclear or other radioactive material (RN material), or of evidence that is contaminated with radionuclides, in the context of legal proceedings under international or national law related to nuclear security. RN materials can be categorised into two broad types. First, nuclear materials represent a distinct class of radioactive materials that include plutonium, uranium-233, and uranium-235. Although they have several non-military applications (e.g. nuclear power reactors, research reactors, etc.), some types of uranium- and plutonium-rich nuclear materials (highly enriched uranium and weapons-grade plutonium, respectively) can be used in the fabrication of nuclear weapons. Criminal acts involving nuclear materials are concerning, as they indicate inadequate safeguarding as well as possible interest in their acquisition by non-nuclear weapon States or non-State actors.
Second, other radioactive materials can be divided into two broad types. These are:
1. radionuclides used for industrial purposes, medical instrumentation, and other technical and scientific applications, such as americium-241, cadmium-109, cobalt-60, and strontium-90 and
2. radionuclides associated with nuclear medicine, such as carbon-14, cobalt-57, iodine-131, and technetium-99m.
In some cases, nuclear forensics is concerned with the examination of non-radioactive materials that have been subsequently contaminated with radionuclides, for example, due to the prepara-
tion or detonation of a radiological dispersal device. In the context of nuclear forensics, the term ‘contaminated evidence’ means items of evidentiary interest that are tainted with radionuclides internally or on the surface.
Nuclear forensic examinations are typically conducted in order to generate technical conclusions that may be used in the context of legal proceedings, such as the determination of whether a legal statute was violated relating to the possession and use of the RN material. Nuclear forensic examinations are also conducted in the context of regulatory and national security investigations into the circumstances regarding the loss of RN material from regulatory control, and/or the discovery of RN material out of regulatory control. Nuclear forensic measurements and conclusions aim to reveal links among people, places, events, and materials. From an investigative and prosecutorial perspective, both inclusionary and exclusionary conclusions are important.
Regarding people, the questions to be addressed through nuclear forensics may include whether there is a person or a group who might have encountered this RN material since it left regulatory control or who otherwise might be associated with the loss of regulatory control. Similarly, nuclear forensics might prove helpful in ruling out a person or a group.
Regarding places, the questions to be addressed through nuclear forensics may include whether the RN material might be associated with either a single geographical location or several locations in terms of how it was mined, processed, manufactured, enriched, used, stored, or transported. Again, the prospect of ruling out locations is important to narrowing the investigation and bolstering any potential prosecution.
Regarding materials, the questions to be addressed through nuclear forensics may include whether there is ‘traditional’ (sometimes referred to as ‘conventional’) forensic evidence associated with the RN material that may enable people, places, or processes to be included or excluded relative to the investigation. As an example, the forensic properties of a feather found with the radioactive material may be consistent with feathers used for insulation in certain jackets and vests. This hypothetical result might prove useful where there is a person of interest who was wearing this same type of jacket or vest.
One analytical methodology for RN materials characterisation is radiochronometry, also known as age-dating. It is a laboratory method enabling the ‘age’ of an RN material to be determined in terms of when it was last purified and is an important predictive signature. Radiochronometry is a robust method in that it is widely used and is supported by extensive scientific literature attesting to its accuracy and precision. For example, results may establish that the material being investigated was last purified in 1983. These results would allow the exclusion of associations with more recent purification dates, narrowing down the places and processes to be considered in the investigation.
The value of nuclear forensics from investigative and prosecutorial perspectives is identical to those associated with traditional forensic examinations. Nuclear forensics contributes to inclusions and exclusions of evidence, much as do biological markers, fingerprints, and toolmarks, among others. Distinctions include (a) the expertise required for the laboratory examination of RN material; (b) the protective equipment and steps required during collection, transport, storage, and analysis of the RN material and of items contaminated with radionuclides; and (c) its evolving state-of-the-art.

Nuclear forensics also aids in identifying vulnerabilities within a nuclear security regime, even if no criminal activity is apparent or can be proven. Understanding these vulnerabilities may identify operational and physical security measures to be adjusted so that RN materials remain under regulatory control, thereby enhancing public safety and reducing the prospects for misuse of these materials. Finally, capabilities for nuclear forensics may serve to deter individuals or groups from committing criminal acts involving RN materials, if such groups perceive that these capabilities enhance the likelihood they will be identified and, when apprehended, prosecuted successfully.
4.2
A generalised scheme of operations at a crime scene where RN materials are present or are suspected is given in Figure 4-1.
Nuclear security event notified
Establish scene control
Initiate common hazards assessment
Activate response system
On-scene response measures
RADIOLOGICAL CRIME SCENE CONDUCT OF OPERATIONS
• Conduct common hazards risk assessment
• Identification of nuclear or other radioactive material
• Ascertain dispersion mode/pathways
• Apply danger reduction procedures
• Establish hazard control areas
• Develop: event action plan; scene safety plan; evidence collection plan
• Collect, package & manage evidence
• Apply chain of custody procedures
• Transport & submit evidence for examination
Release scene to competent authorities for consequence management
Conduct after action review
Figure 4-1. Conduct of operations where RN materials are present. [Ref. (5), p. 9]
While most activities at such a scene are identical to those at any other crime scene, the inherently hazardous nature of RN materials requires additional knowledge, specialised equipment, sophisticated instrumentation, and expanded or novel roles for crime scene personnel. Moreover, any scene where a release of radioactive material has occurred – that is, a post-blast scene presents additional challenges for on-scene operations and, as such, merits special attention.
These challenges should be reflected in an evidence collection plan, outlining (a) actions to be taken at or near the crime scene, especially regarding priorities for collection and subsequent analysis; (b) personnel designated to take these actions; and (c) the on-scene, near-scene, and laboratory destinations for evidence and any other materials collected.
Effective management of a crime scene where RN materials are present benefits from an integrated command structure, such as that depicted in Figure 4-2.
Release Public Info Flow (Instructions)
Strategic Area
Strategic Planning
Interagency Coordination
Legal Advice
Reachback Expert Capabilities
Release Public Info Flow
Control and Command Post
Law Enforcement
Public Info Flow (Source)
National Command
International Cooperation Coordination Information Management
Tactical Area Bomb Squad Local Commander Secured Area
Medical Care Radiation Protection Forensic Access Control
Decontamination Station Emergency Services
Contamination Control
Helicopter Meeting Point
Operational Area Access Control
• Scene Modeller
• Safety Specialist
• Hazardous Materials
• Operations Specialist
• Radiological Assessor
• Evidence Recovery Personnel
• Photographer Secured Area
Figure 4-2. Command Structure For Managing A Crime Scene Where Rn Materials Are Present Includes The Unique Position Of A Radiological Assessor. [Ref. (5), P. 14]
The presence of RN materials requires an expansion of the roles and responsibilities of the Hazardous Materials Operations Specialists and of the Safety Specialists. Specific roles and responsibilities of Hazardous Materials Operations Specialists at a scene involving RN materials should include (a) ensuring radiation monitoring is conducted at the scene and (b) establishing radiation safety objectives for crime scene personnel operating in areas where RN material is present or is suspected. Likewise, specific roles and responsibilities of Safety Specialists at such a scene should include (a) coordinating with the Radiological Assessor (see below) to provide guidance regarding the time-distance-shielding paradigm related to radiation safety; (b) identifying and monitoring personnel operating within the crime scene regarding both ‘stay times’ (the time the personnel are permitted to be in an area of potential exposure to radiation) and ‘work times’ (the time the personnel are permitted to perform work within an area of potential exposure); and (c) ensuring that appropriate decontamination facilities are operational for on-scene decontamination of personnel, equipment, evidence, and any other items as necessary, ‘decontamination’ referring expressly to the removal of radionuclide contamination.
The position of radiological assessor is unique to scenes where RN materials are present or are suspected. In brief, the radiological assessor is responsible for ensuring the radiation protection of crime scene personnel. The specific roles and responsibilities of the radiological assessor are extensive and critical to the health and safety of crime scene personnel. These include but are not limited to:
• Briefing on-scene personnel about the radiological situation and providing guidance on the personal protective measures needed to minimise exposure times and mitigate exposure risks.
• Identifying any radioactive material present.
• Measuring air-borne and surface radionuclide contamination.
• Measuring external radiation dose rates.
• Calculating the permissible and/or recommended stay times for crime scene personnel.
• Conducting and interpreting radiation surveys.
• Ensuring that external radiation monitoring logs and records are established and maintained for all crime scene personnel.
• Identifying appropriate procedures for decontamination of personnel, equipment, and evidence.
• Assisting in planning for the collection, packaging, radiation-specific labelling, storage, and transport of items of evidence.
• Ensuring any waste items, such as used PPE, produced at the scene are recorded and managed in accordance with national guidelines.
Given the extensive and unique roles and responsibilities of the radiological assessor, advance coordination with national entities beyond those routinely associated with crime scene operations might be required to ensure competent and qualified personnel are selected and have access to the specialised equipment and
sophisticated instrumentation associated with this position. Potential resources for such coordination include: academic institutions having nuclear science programs; defence-related nuclear laboratories; hospitals featuring nuclear medicine; regulatory authorities with operational capabilities; and industrial operations where radionuclides are handled routinely, such as nuclear power plants. (See also Ref. (2))
In addition to on-scene duties, one responsibility routinely handled outside the crime scene involves communicating with the public and other government agencies. Given the heightened concern regarding the presence of RN materials, the radiological assessor should be available to prosecutors and public information officers for contributions to public statements during incidents and trials, especially to counter the spread of misinformation, due to the adverse consequences for public safety and order. Guidance for dealing with misinformation in the context of RN materials is provided in Ref. (8), and its use is encouraged.
A device using conventional explosives to spread RN material is commonly referred to as a radiological dispersal device (RDD).
A post-blast investigation of an RDD merits special attention owing to hazards associated with the presence of radionuclides, the possibility that additional explosive devices are at or near the scene, and the structural and geological changes caused by the explosion.
The objective of post-blast investigation is to identify the technical characteristics, functionality, and mode of employment of the explosive device. The information gathered enables an assess-
ment of the technical capabilities of the perpetrator, as well as the modus operandi, that is, the method of operation. If the explosion took place close to the ground, a crater may be formed. If so, its dimensions, including depth and breadth, should be measured and recorded. The crater should be surveyed for residues of the explosives themselves and their reaction products. These activities are similar to other post-blast investigations related to improvised explosive device attacks. However, they differ, in that any activity in or near the crater must include monitoring for radioactivity and must be conducted in accordance with the radiation safety protocols for stay time and work time as directed by the radiological assessor.
A recommended initial step in a post-blast investigation involves using an unmanned aircraft system (UAS) or drone that might fly over and around the blast site for reconnaissance purposes. Such use should enable an overview and photographic record of the site to be developed and reduces the risk of harm to crime scene personnel on site in the event a secondary explosive device exists. Finally, the use of a UAS might require both equipment and expertise beyond those normally associated with crime scene operations. Therefore, resources might need to be requested from partner agencies or other national entities.
As soon as the blast scene is deemed safe for initiation of on-scene operations, the collection of evidence should start, with a focus on three elements of the RDD and the explosion: (a) remnants that might reasonably be tied to the RDD, such as fragments that appear to have come from an explosive device; (b) evidence that aids in identifying the builder of the RDD and the party that placed it, and (c) on-scene and near-scene evidence that aids in identifying the placement and functioning of the RDD, such as video-recording devices used for security and surveillance.
The spatial distribution of RN material following the detonation of an RDD depends on various parameters, such as:
• Amount and type of explosives used.
• Amount and type of radioactive material.
• Physical characteristics of the radioactive material, such as liquid, metal, metal alloy, or powder.
• Distance between the explosive charge and the radioactive material.
• Orientation of the explosive charge and the radioactive material.
In addition to on-scene evidence collection, investigators should identify and question anyone who witnessed the explosion or the events prior to the explosion. Their observations may provide additional information; for example, the colour of the post-blast plume can indicate the type of explosives used. Observations on the size of the plume, its drift direction, and its odour can help characterise the RDD, making the use of certain types of devices and explosives more likely than others and, consequently, deserving greater attention. (Additional guidance on post-blast investigations is provided in Ref. (1))
The development of a forensic examination plan is the initial step in the laboratory processes associated with nuclear forensics in support of an investigation. This plan marks the transition from crime scene operations to forensic laboratory activities. The Investigating Authority should take the lead in developing the plan, working in concert with laboratory personnel to ensure that (a) the examination meets investigative needs; (b) the Investigating Authority is aware of the timeline for conducting the examination and reporting results; and (c) the associated laboratory or laboratories and the Investigating Authority agree on the amount of evidence to be consumed and the disposition of evidence once the laboratory work is completed. Developing the plan requires knowledge of the needs and requirements of the investigative authority, as well as the requirements of each method to be used in the investigation (e.g. length of time for each analysis, amount of sample required, whether a portion of the sample is consumed by the analysis, expected measurement uncertainty, etc.).
The forensic examination plan should encompass two related but distinct parts of working with recovered RN material. One part involves various laboratory procedures associated with analytical chemistry. These procedures are necessary to categorise, identify, and characterise the RN material itself. Examples include mass determination (using an analytical balance), gamma spectrometry, mass spectrometry, X-ray fluorescence, scanning
electron microscopy, and other analytical techniques. This part demands expertise and specialised facilities not found in most ‘traditional’ (‘conventional’) forensic laboratories; instead, these methods may be found in national nuclear laboratories or facilities associated with a State’s nuclear fuel cycle, or in academic, industrial, national defence, and military facilities. The second part involves various laboratory procedures traditionally associated with forensic sciences, such as fingerprints and analysis of trace evidence and of biological markers, especially nuclear DNA. Although these procedures are well-established, conducting them on evidence contaminated with radionuclides presents relatively novel challenges, as discussed in Section 4.4.
The International Atomic Energy Agency (IAEA) has published an Implementing Guide describing processes for the conduct of nuclear forensics in support of investigations (See Ref. (3)). This process, known as the Model Action Plan, establishes goals for completing analyses and examinations and reporting results in terms of what may be expected to be accomplished in typically 24 hours, one week, and two months and is developed in conjunction with the nuclear forensic examiner. One issue that might be confronted is the expectation that results will be available nearly instantaneously, with minimal uncertainty, and provide an absolute answer to questions related to attribution of the RN material.
Regardless of the specifics covered by the forensic examination plan, its development should be a collaborative process between the Investigating Authority and the primary laboratory representative. Collaboration is essential to ensuring the investigation’s needs are captured while understanding the limitations of the laboratory
in terms of expertise, instrumentation, specialised facilities, and, especially, any potentially competing assignments. Approval of the analytical plan by both parties – the Investigating Authority and the laboratory – documents the needs and expectations of the investigation regarding timeliness of reporting results, defensibility of methods, and the rendering of expert testimony (should it be required). Similarly, such approval aids the laboratory in justifying the resources required to accomplish the work and in prioritising access to people and instruments.
As outlined in the Model Action Plan, within 24 hours of receiving the material, the nuclear forensics laboratory should be able to (a) assess the nature of the radiation risk, if any, to those responding to the scene; (b) predict the nature of the radiation risk relative to public health and safety; and (c), when used in combination. Nuclear forensic conclusions, when combined with other information, may help establish whether or not a legal statute has been violated. The knowledge gained in the initial 24 hours may help to provide a basis for proceeding with the investigation.
Within one week of receipt of the material, the nuclear forensics laboratory should be able to refine the initial analyses. Also, in one week the nuclear forensics laboratory should be able to develop additional information that may be used for routine law enforcement or judicial purposes (such as establishing investigative leads) or for national security purposes (such as ruling in or ruling out potential origins of the material).
Within two months of receipt of material, the nuclear forensics laboratory should be able to characterise the RN material. This characterisation would provide clues such as its originally intended use, its age since last purification, processing history, and storage
history. In addition, two months should be sufficient time to enable a comprehensive suite of traditional forensic examinations to be performed. Performing such examinations, however, might require outreach to, and collaboration with, national or international partners having the specialised facilities and qualified experts for conducting examinations on contaminated evidence. (See also Section 4.4 for additional information on potential partners).
Evidence associated with a crime scene involving RN material may require any of three distinct types of forensic examinations. First, there are examinations performed on evidence determined to be free of contamination from radionuclides. Second, there are examinations performed on evidence contaminated with radionuclides. Third, there are examinations performed on the RN materials themselves. The first type will require the facilities and expertise associated with conventional forensic laboratories. Conducting the second and third types of examinations will require use of specialised facilities

Figure 4-3. Nuclear scientist performing forensics analysis on contaminated evidence within a glovebox (photo provided by IFIN-HH, Romania).
and scientific expertise associated with a designated nuclear forensic laboratory.
An extensive, often informal network of conventional forensic laboratories exists regionally, nationally, and internationally. These laboratories are associated with traditional forensic disciplines, such as DNA and other biological markers, fingerprints (fingermarks), explosives, firearms, questioned documents, toolmarks, and paints and other chemicals. The traditional forensic disciplines and their associated facilities and personnel are well-recognised and, in most cases, have a history of supporting investigative and prosecutorial requirements. This history includes following documented procedures, establishing and maintaining proficiency in their associated disciplines, and providing expert testimony on results obtained and conclusions drawn.
Few laboratory facilities are known to be in operation that have the proper infrastructure as well as the scientists and technicians needed to process evidence potentially contaminated with radionuclides. Such specialised facilities are crucial to ensure the safety of laboratory personnel conducting these examinations and to provide for the safe and secure storage of all RN materials. Three such facilities are the Australian Nuclear Science and Technology Organisation (ANSTO), in New South Wales, Australia; the Joint Research Centre (JRC), in Karlsruhe, Germany, primarily serving EU Member States; and the Radiological Evidence Examination Facility (REEF), at the Savannah River National Laboratory in Aiken, South Carolina, United States, which is operated by the Federal Bureau of Investigation. Other facilities also exist. Access to the expertise available at these facilities may be possible through bilateral or multilateral negotiated agreements, either in response to a specific event or in anticipation of future needs.
There are knowledge gaps associated with the effects of radioactivity on the biological, documentary, and physical materials subjected to traditional forensic examinations. These gaps encompass questions such as whether radioactivity will alter a forensic signature, how such alterations, if they occur, may vary with time, and how they should be considered when reaching conclusions.
Any designated nuclear forensic laboratory should be capable of undertaking a nuclear forensic examination using validated analytical methods, staff with demonstrated competencies and documented procedures. Accreditation of the laboratory to an internationally recognised quality standard is advantageous (e.g. ISO 9001:2008 [23], ISO 14001:2004 [24], ISO/IEC 17025:2005 [25], OHSAS 18001:2007 [26]). Lack of proper validation raises concerns about the acceptability of results within the scientific community or may be challenged if presented in a legal context. Additionally, the scarcity or difficulty in obtaining standard reference materials for RN materials poses challenges for comparisons, potentially weakening the defensibility of results if presented in legal proceedings. Finally, databases and similar libraries of information regarding RN materials are often incomplete and may be subject to restrictions on sensitive information by the custodians. (See Refs. (6), (7), and (9)).


Figure 4-4. Screenshot of the ‘Gallery’ option from the ‘Detailed info’ menu, showing the image of PELLET-12, from its top view in (a) and its side view in (b) in the Romanian NNFL system.
Work has been underway to address these knowledge gaps. In particular, the Nuclear Forensics International Technical Working Group (ITWG) has been working since its founding in 1995 to advance nuclear forensics in support of investigating events involving RN materials out of regulatory control. The ITWG is an informal, non-aligned community of scientists and practitioners having expertise in fields related to RN materials, law enforcement, and emergency response. The ITWG community is developing and sharing best practices for the forensic analysis of RN materials and of radionuclide-contaminated materials. Additionally, the group collects and shares scientific and technical data on RN radioactive materials, facilitating the development of databases that may be used for comparisons with materials of otherwise unknown or suspect provenance. Such databases in some countries may also be known as national nuclear forensic libraries they help countries to determine whether seized material is or is not consistent with their material holdings.
The ITWG also plans, executes, and reports on voluntary, ungraded exercises in which participating laboratories perform a suite of analyses on a material. In these exercises, known as Collaborative Materials Exercises or CMXs, each laboratory receives subsamples of the same material, thereby permitting results to be compared with increased confidence that any variations in results among the participants can be attributed to differences in methods or practices rather than to differences in the material itself. Participants use each CMX to evaluate their performance, identifying individual strengths as well as areas in need of further work. Conduct of the exercises has broadened to include traditional forensic disciplines applied to materials contaminated with radionuclides.
Through ITWG initiatives, a network has been established among experts and laboratories among the ITWG community such that these experts, their expertise, and their specialised facilities might be called upon in a situation where RN material is found or is believed to be out of regulatory control. This network contributes to nuclear security by enhancing the possibilities that the point at which regulatory control was lost will be identified and that the responsible party or parties will be prosecuted successfully for their crimes. This network should be available to assist investigating authorities in addressing the needs of the investigation and the prosecuting authorities in interpreting and defending laboratory results.
Case Title:
Date of Investigation:
May–June 2017
Level:
National/Federal
Incident Summary:
Country of Origin: Georgia
Region/State: Tbilisi
Case Category: RADIOLOGICAL
• On May 17, 2017, Georgian law enforcement officers received information that several persons illegally possessed radioactive material and were, at that time, driving a Mercedes sedan (with other vehicle details) in Tbilisi.
• The State Security Service of Georgia immediately launched an investigation under Article 230 of the Criminal Code of Georgia (Illegal handling of nuclear material or equipment, radioactive waste and radioactive substances).
• The Mercedes sedan was identified, located and stopped in a safe place.
• A search revealed four people in the car, along with a smoke detector containing Americium 241 (241Am), a radioactive material, which was then seized.
• The search and seizure procedures were conducted with the support of specialists from the Nuclear and Radioactive Safety Agency.
• All four individuals present in the car were arrested under Article 230.
Investigative Focus:
• Identify the radioactive material in question.
• Determine how the material came to be in Georgia.
• Identify all individuals involved in the illegal handling of the material.
• Determine if criminal culpability exists and, if so, who among the four arrestees committed what criminal acts.
Key Points of Evidence:
• Radiological evidence: The seized object was a smoke detector containing 241Am.
• Biological evidence: Biological samples obtained from the smoke detector and the packaging where it was kept belonged to two perpetrators from the car.
• Fingerprint evidence: Fingerprints discovered on the smoke detector belonged to one perpetrator from the car.
• Electronic/Digital evidence: A video of the seized smoke detector was found on the mobile phones of two perpetrators. Text messages on the phones explicitly stated that the object contained radioactive material. The seized smoke detector was determined to be the same as in the video on the perpetrators’ mobile phones.
Prosecutorial Priorities
• To prove that the smoke detector contained illegal radioactive material.
• To prove that all four perpetrators were involved in the illegal storage and transportation of radioactive material.
• The smoke detector underwent examination twice. First, at the crime scene, when representatives from the Nuclear and Radioactive Safety Agency arrived and used their field equipment, determining that the smoke detector contained 241Am.
• Second, following the seizure, the smoke detector was sent to the forensic department special storage and expert facility of the of the Georgian Ministry of the Interior. Expert radiological testing revealed illegal levels of gamma radiation were present, along with an amount of 241Am at levels dangerous to human health.
• None of the perpetrators confessed.
• The defence tried to prove that the smoke detector did not belong to the accused persons, and the accused persons were unaware that it contained radioactive material.
• The central challenge for the prosecution was to prove that all the perpetrators were knowingly involved in the crime.
• Of course, radiological expertise played a crucial role in establishing the nature of the crime and the involvement of radioactive material. First, the prosecution needs to prove that the case is about RN materials and that it needs to rely on radiological expertise in this respect.
• We learned here again that, when it comes to proving concrete links between perpetrators and the RN material, traditional investigation and expertise provide very important information.
• In this case, biological expertise, fingerprint expertise and video expertise provided crucial evidence for the prosecution, allowing them to prove the involvement of all four perpetrators in the illegal storage and transportation of radioactive material.
1. United States Department of Justice, Office of Justice Programs. A Guide for Explosion and Bombing Scene Investigation, National Institute of Justice, Washington (2000).
2. International Atomic Energy Agency, Method for Developing Arrangements for Response to a Nuclear or Radiological Emergency, EPR-METHOD 2003, IAEA, Vienna (2003).
3. International Atomic Energy Agency, Nuclear Forensics in Support of Investigations, IAEA Nuclear Security Series No. 2-G (Rev. 1), STI/PUB/1687, IAEA, Vienna (2014).
4. International Atomic Energy Agency, Nuclear Security Systems and Measures for the Detection of Nuclear and Other Radioactive Material out of Regulatory Control, IAEA Nuclear Security Series No. 21, IAEA, Vienna (2013).
5. International Atomic Energy Agency, International Criminal Police Organization-Interpol, United Nations Interregional Crime and Justice Research Institute, Radiological Crime Scene Management, IAEA Nuclear Security Series No. 22-G, IAEA, Vienna (2014).
6. Nuclear Forensics International Technical Working Group, ITWG Guideline, Importance of Uncertainty in Nuclear Forensics Measurements, ITWG-INFL-UNCR-v1 (April 2017).
7. International Atomic Energy Agency, Development of a National Nuclear Forensics Library: A System for the Identification of Nuclear or Other Radioactive Material out of Regulatory Control, IAEA-TDL-009, Vienna (2018).
8. United Nations Interregional Crime and Justice Research Institute, Handbook to Combat CBRN Disinformation, UNICRI, Torino (2022).
9. International Atomic Energy Agency, Establishing a Nuclear Forensic Capability: Application of Analytical Techniques, IAEA-TECDOC-2019, Vienna (2023).

CHAPTER FIVE

Radiation Detection, Alarm Adjudication and Scene Security
Non-Destructive Techniques Applied at the Radiological Crime Scene
Laboratory
Technology Applied to Forensic Analysis of Nuclear or Other Radioactive Material
Forensic Techniques Applied to Items Contaminated with Radionuclides
Use of Analytical Data for Investigative Conclusions
Quality Assurance and Quality Control
Example
The main difference between crimes involving nuclear or other radioactive materials and other crimes is the presence of ionising radiation. While crimes using non-ionising radiation are possible, as discussed in Chapter 1.1, with a case example in Chapter 9, ionising-radiation makes criminal investigation more complex. This chapter will describe the technologies and methods commonly used to assist national authorities and subject matter experts in investigating crimes involving RN material or items contaminated with radionuclides.
Ionising radiation interacts with matter allowing scientists to use various materials to create systems capable of detecting and analysing this radiation. These systems provide information on the presence and characteristics of nuclear or other radioactive materials. In their efforts to build a comprehensive nuclear security regime, many States have integrated various types of radiation detection systems following international guidance and best practices. These systems can be divided into three main categories: stationary radiation detection technologies, mobile radiation detection and monitoring technologies, and radiation analysis equipment.
Stationary radiation detection technologies are mainly represented by high-efficiency electromagnetic and neutron radiation detectors installed at points of interest, such as state borders, facilities holding nuclear or other radioactive material, scrap yards or other locations with increased probability of radiation detection.
Mobile radiation detection and monitoring technologies are represented by similar detectors, either portable or installed in ground or aerial vehicles.
Radiation analysis equipment provides important information about nuclear or other radioactive materials present at the scene.
Given the complex nature of ionising radiation, no single detector can offer a perfect solution. For example, alpha radiation can travel only a few centimetres in air, and



is easily shielded. The discovery of alpha radiation requires a detector with exposed crystals at very short distances from the source. In cases involving very small quantities of nuclear material or radioisotopes with a low probability of emitting beta particles, gamma rays or neutrons, in addition to alpha particles, alpha detectors may be the only option. Historical incidents have demonstrated the use of such sources in radiological and nuclear crimes. A good example is polonium-210, which is one of the isotopes of polonium requiring alpha radiation-dedicated technologies for its detection and analysis.
Beta radiation, on the other hand, can be measured by detectors similar to those used for alpha particles, and the approach is analogous. However, beta radiation travels much further and has greater penetration than alpha radiation. Additionally, beta radiation can sometimes generate secondary electromagnetic radiation. This secondary radiation can be picked up by X-ray or gamma detectors. Typically, the alpha or beta decay of a radioactive atom is accompanied by gamma radiation, which makes detection and analysis easier.
Nonetheless, some isotopes are pure beta minus emitters and require dedicated beta equipment. Examples of such isotopes include phosphorus-32 and -33, chlorine-36, calcium-45, nickel63, strontium-90/yttrium-90, technetium-99 and thallium-204. If sources containing such isotopes are found outside of regulatory control, special equipment dedicated to beta radiation, coupled with subject matter expertise, may be required.
Some nuclear materials undergo a type of decay called spontaneous fission, emitting neutrons that are highly penetrative and discernible by detectors made of light materials, such as
helium-3. If a neutron alarm were triggered, it should immediately raise concern among front-line officers, prompting special attention to the possible presence of undeclared nuclear materials, such as plutonium.
The majority of radioactive decay includes the deexcitation of atoms via electromagnetic ionising radiation, specifically X-rays or gamma rays. Currently, there are numerous types of detectors capable of identifying and measuring such radiation, and using the data to provide information about the interdicted nuclear or other radioactive material.
There have been numerous cases where radiation detection technology was the first indication of unauthorised actions involving nuclear or other radioactive materials. The activation of a detection alarm may be the first sign of the presence of radioactive material exceeding legal limits. However, it does not automatically indicate the commission of a crime. Therefore, evaluating radiation alarms is required. When circumstances indicate a radiation detection alarm is associated with undeclared radioactive materials, state authorities should investigate.
In States that criminalise unauthorised actions involving nuclear or other radioactive material, any non-judicial executive agencies acquiring knowledge about suspicious activities constituting a criminal offence are obligated to report such incidents to the appropriate law enforcement agency. Such an incident must be treated as a potential crime and its location must be secured as it can represent a potential crime scene. This is done by delineating the perimeter within which the crime was potentially committed and implementing safety precautions related to radiation exposure and/or contamination.
This chapter discusses technologies employed at crime scenes involving nuclear or other radioactive materials. While the primary purpose of managing a radiological crime scene aligns with that of a conventional crime scene, special attention must be paid to the radiation protection of experts working in the radiological environment and with potentially contaminated items.
Initially, a radiation dose and radioactive contamination survey should be conducted by qualified and authorised personnel using dose rates and contamination meters. If dose rates are significant, calculations for time, distance and shielding must be performed to avoid exposing the experts to unsafe levels of radiation. In environments where dose rates pose a danger to human health, experts may consider deploying unmanned ground or aerial vehicles with radiation measurement equipment. Prosecutors should be aware that in cases of extremely high radiation, such equipment may fail.
If the dose rates do not indicate a significant radiation exposure risk, experts may decide to enter the crime scene. Meticulous planning for each entry, with the goals of reducing exposure time, maintaining distance from the source as much as possible, and utilising existing shielding, is essential. Contamination of people or items with radionuclides is another factor that must be considered. Sealed sources do not lead to contamination, however, there may
be cases where the risk of contamination is present due to a damaged sealed source or an undiscovered unsealed source.

5-4. Picture of PPE provided by Horia Hulubei National Institute for R&D in Physics and Nuclear Engineering (IFINHH).provided by EUSECTRA
Experts working in potentially contaminated environments should always wear PPE comprising a watertight suit, mask, gloves, overshoes and a personal dosimeter. It is recommended to wear both passive dosimeters (which accumulate and process doses at a later stage) and active dosimeters (which enable real-time visualisation of dose rate). Moreover, when certain items are potentially contaminated and represent significant and urgent investigative value, they can be analysed at the crime scene within a portable glovebox. A glovebox is a watertight plastic container or bag equipped with special gloves and sections for handling samples. They can be used to process contaminated items with evidentiary value while preventing additional contamination.
In addition to the technologies employed during conventional crime scene management, radiological crime scene investigations use radiation detection and measurement equipment. Dose rate and contamination meters will provide information on radiological
hazards, dose rates and the presence of radioactive contamination. Radioisotope identification devices (RIDs) can detect, localise and identify the source of radiation. High-purity germanium-based RIDs, in particular, can provide precise information on isotopes, identify the type of nuclear material and often offer significant initial information on nuclear forensics signatures associated with the analysed sample.


5-5. Image of conventional forensics tool (left) and radiation measurement equipment (right) provided by IFIN-HH.
Conventional forensic analysis at a radiological crime scene can be conducted in gloveboxes and under the supervision of a radiation safety specialist. Good practices for analysing contaminated items involves radiation or nuclear specialists working under the guidance of traditional forensics experts.
Upon receiving information from a radiological crime scene, a laboratory designated to perform nuclear forensics analysis should ensure that all the arrangements related to the radiological and evidentiary value of the samples are in place. After receiving a request (i.e. prosecutorial ordinance), the laboratory should develop an evidence analysis plan as well as a nuclear forensics analytical plan, submitting both for approval to the lead investigative body.
The analysis results obtained at the radiological crime scene should be confirmed by the laboratory in a controlled environment. Items with potential evidentiary value should be double-checked for dose rate and contamination. Items that are not contaminated should be sent to a traditional forensics laboratory for further processing. Two possible solutions exist for items that are found to be contaminated: a) analysis within a controlled area, considering radiation protection aspects such as PPE and gloveboxes, or b) decontamination and analysis using traditional forensics approaches. However, the second approach might destroy traces of evidence, as special solutions are used for decontamination.
The radioactive sources or nuclear material should be analysed only in controlled areas, with all necessary radiation protection precautions in place. There are two generic categories of technologies employed by nuclear forensics laboratories to characterise
nuclear or other radioactive material. These include non-destructive techniques such as dosimetry, gamma spectrometry (GS), neutron counting, scanning electron microscopy (SEM), X-ray fluorescence (XRF), X-ray diffraction (XRD) and computed tomography (CT). Additionally, there are destructive techniques that require significant sample preparation, often using acids for sample dissolution. These destructive techniques include alpha, beta or mass spectrometry.
Techniques that are commonly applied for the analysis of nuclear or other radioactive materials and their nuclear forensics applications provide information on the physical, chemical, isotopic and elemental signatures of the scrutinised nuclear or other radioactive material. When combined with other information of investigative value, these signatures establish links between the analysed sample, its origin and the point of loss of the last authorised control, connecting individuals with places and events. The information obtained through laboratory techniques can assist criminal investigators in uncovering the truth about a specific incident by answering the questions of what, where, how, when and why an illicit activity occurred and potentially identifying those involved.
Items of evidentiary value that are contaminated with radionuclides might need to undergo forensic analysis. However, such samples are normally analysed by traditional forensics experts who may not be trained to work with radioactive contamination and/or in radiation exposure environments. To overcome this challenge, scientists have developed approaches that allow traditional forensics experts to conduct their work safely. A notable example of such an approach is the DNA extraction method, which is performed within a watertight box specifically designed for items contaminated with radionuclides. Another example is the fingerprint development system, which uses cyanoacrylate evaporation methods within a glovebox.

Physical proprieties, such as colour, dimensions, weight and density, can also be examined on contaminated items within a glovebox. More complex analysis, such as identification of chemical form, microstructure or morphology, elemental impurities, or even digital forensics, can be performed using analytical techniques that are connected to a glovebox for safe sample introduction and handling.
Figure 5-7 illustrates an example of a scanning electron microscope connected to a glovebox and ventilation system. Traditional forensic analytics techniques can be efficiently applied to items contaminated with radionuclides if all required radiation safety precautions are implemented and the experimental setup is authorised by competent authorities.
Special attention should be paid to the risk of cross-contamination of items at the crime scene, during transport and in the laboratory. Traces of radionuclides found on various items can reveal links between these items. Therefore, it is important that every item with evidentiary value is packed individually to avoid accidental connections with other items, including those from other criminal cases.

Experts working with contaminated items should undergo radiation protection–related training and be informed about health and safety precautions related to the presence of radionuclides. Trained and qualified radiation protection personnel should assist with the handling of contaminated items throughout the process. The radioactive waste generated from this activity should be collected and stored in designated and authorised areas.
The data obtained at the radiological crime scene, as well as in the laboratory performing nuclear or traditional forensic analysis, could be unfamiliar to investigative authorities. Therefore, subject matter expertise is often required to interpret the raw data and draw relevant investigative conclusions to answer the questions posed by the judiciary or law enforcement. These conclusions are designed to assist with a criminal investigation and subsequent prosecution. Therefore, scientists and lawyers should, in advance, establish and use a common lexicon within radiological crime scene management and nuclear forensics reports.
A combination of information technology and subject matter expertise is essential in obtaining and interpreting the analytical data, as well as in using it to draw conclusions relevant to criminal investigation. A good example is the gamma spectrometric measurement of a uranium sample to establish whether it can be used to produce nuclear weapons. Such a measurement gen-
erates a histogram with energy (characteristic to isotope) on the X axis and counts (proportional to the quantity of that isotope in the sample) on the Y axis. This histogram can then be introduced into software called Multi-Group Analysis for Uranium (MGAU), which will semi-automatically provide the isotopic composition of that sample.
Figure 5-8 illustrates the process of transforming raw gamma spectrometric data into information interpretable by subject matter experts. This depiction reveals that the analysed sample contains approximately 0.2% of 235U, an isotope of uranium primarily used in nuclear reactions. This abundance of 235U indicates depleted uranium samples that are no longer viable for nuclear reactions. Moreover, this type of material is commonly found outside of regulatory control and does not pose a significant radiation exposure risk. However, even this material may warrant criminal prosecution as 235U, when inhaled or ingested, presents a significant health hazard. Adversaries may be strategising or taking advantage of these health risks.

The implementation of a robust quality assurance and quality control system is an important part of any forensics programme offering analytical services in support of criminal investigations and prosecutions related to radiological and nuclear crimes. This is especially critical for technical reachback and laboratories applying analytical techniques in these contexts, where the validity of the generated results becomes a top priority.
Entities providing radiological crime scene management and forensics laboratory support should adhere to a comprehensive set of requirements, including:
• Implementation, maintenance and continual improvement of the quality management system in accordance with the requirements of the Joint Technical Committee 1, ISO/IEC 17020:2012 and ISO/IEC 17025:2018 standards.
• Selection and deployment of competent staff possessing the necessary qualifications, training and experience appropriate to their assigned role in the process.
• Ensuring staff awareness regarding the importance of their activities and the responsibility they bear in achieving the objectives.
• Regular training programmes for staff aimed at enhancing their professional knowledge and contribution to the effectiveness of the quality management system.
• Choosing and declaring work methods aligned with the requirements of clients.
• Provision of appropriate reference equipment and materials at internationally recognised standards, with ongoing efforts for improvement and updates.
• Ensuring the quality of the results through participation in intercomparison exercises with similar accredited national and international entities.
• Ensuring a suitable and safe working environment.
• Guaranteeing that staff remuneration does not depend on the number of services provided.
• Adherence to the principles of impartiality and independence.
• Respect for the confidentiality and property rights of the clients.
• Avoidance of any influence or pressure, internally or externally, that could compromise data and/or decisions for any reason.
• Abstaining from activities that could undermine confidence in competence, decisions or functional integrity.
• Ensuring that technical activities comply with the requirements of reference documents in accordance with the provisions of the management system.
The quality assurance and quality control policy must undergo periodic analysis and evaluation to ensure its continued compliance with the requirements and expectations of the clients, as well as with national legal and regulatory frameworks, including criminal procedural legislation.
Case Title:
Presented here from a technical perspective and in Chapter 8 from a prosecutorial perspective.
Date of Investigation: July 2018–January 2019
Level
National/Federal
Incident Summary:
Country of Origin: Romania
Region/State: Bucharest
Case Category: RADIOLOGICAL
• In July 2018, two alarms were triggered at Henri Coanda International Airport in Otopeni, Romania.
• A technical support team identified the presence of iodine in the form of 125I, which is used by the medical community. Isotopic contamination was present on decks of playing cards. The amount of radioactivity exceeded Romania’s legal limits.
• A criminal case was opened by the Directorate for Investigations of Organized Crime and Terrorism (DIICOT).
• The NFL-RO laboratory of the Horia Hulubei National Institute for R&D in Physics and Nuclear Engineering was tasked via prosecutorial ordinance to perform nuclear forensics analysis of the contaminated items. Two detailed forensics reports were generated revealing that the cards’ suits (clubs, diamonds, hearts and spades) were intentionally contaminated in such a way that the doses generated by the backs of the marked cards were approximately 2.5 times those of their fronts.
• Criminal investigation revealed that the confiscated items, along with other equipment, were intended to be used for illicit gambling activities within the Vietnamese community in Romania.




Figure 5-9. Image of one piece of evidence, the 5 of hearts playing card, along with CT images of a clean card, a card with lead + 125I injections, and card with silver + 125I injections.
• The investigation aimed to prove membership in the organised crime group and expose unlawful activities, ultimately resulting in illicit profits.
• All main cards (covered in aluminium foil) contained radioactive 125I shielded on one side with lead or silver. The activity per sample ranged from 9.15 MBq to 19.2 MBq.
• A small blue device, which proved to be a Geiger-Müller counter –apparently custom-made for detecting 125I – was found in the second incident. This was used covertly to help direct the betting during the Xóc Đĩa game to detect the number of tokens retrieved face-up after shaking the bowl.
• Although cards, iodine solution, and iodine detectors were available for purchase on Vietnamese sites, it became apparent that these were industrially produced in a third country by individuals or companies that probably had access to a medical source of 125I.


Figure 5-10. Image of one piece of evidence, the 5 of diamonds, revealing the injections with a flashlight and a scalpel.
• The prosecution focused on finding proof of the existence of the organised crime group, its structure and the offenders’ roles, determining the group’s duration and criminal scope, and identifying and confiscating unlawful financial assets.
• The two leaders of the criminal activities were fully aware of the nature of the materials used in the playing cards. Following the confiscation of the packages, they had made plans to introduce another set of radioactive playing cards into Romania.
• The two leaders were lending money to interested players at interest rates of 50 percent and keeping debtors’ bank cards and mobile phones as guarantees. It was established that illicit gains ranging from a few thousand to tens of thousands of euros had been made.
• At the same time, the prosecution aimed to disrupt criminal activity and prevent further attempts by the group members to introduce hazardous materials into Romania.
• Dosimetry, contamination and radiological risk assessment were initially conducted at the detection site. The radioactive items were detected at the exit point of Henri Coanda International Airport in Otopeni, Romania, which is equipped with radiation detection portal monitors for passengers, as illustrated in Figure 5-11.
• The secondary inspection was performed on-site by a border police officer using a hand-held RID.
• During the criminal investigation, nuclear forensics methods were employed, including high-resolution gamma spectrometry and X-ray radiography.
Challenges
• Swipe samples taken from the surfaces of the playing card decks revealed the presence of 125I, indicating that radioactive contamination was leaking outside the card decks.
• Due to the contamination, these decks and their surroundings had to be handled with utmost care at the crime scene, during transport and in the laboratory. Moreover, given the chemical nature of 125I, its volatility and its ability to leak through the smallest openings, the use of additional radiation PPE was necessary throughout the investigative and analysis process.

• Radioactive material was recovered and transported in accordance with the Criminal Procedural Code of Romania and the National Legal and Regulatory Framework related to nuclear safety and security.
• All the examined samples (decks of cards) contained radioactive 125I. No other isotopes were identified, while lead was detected in the examined samples of the first batch.
• Each card presented for analysis exhibited a significant amount of 125I, exceeding Romania’s legal limits.
• Some decks of cards had one card with four distinct points of lead or silver deposits, where the highest concentrations of 125I were found. Some of these cards were wrapped in aluminium foil.
• In the first batch (first alarm, 18 July), 125I was deposited on a lead substrate while the second batch (second alarm, 22 July), a silver substrate was used.
• The cards were not visibly damaged, suggesting that the substrates of lead and silver with depositions of 125I were introduced inside the cards during the manufacturing process, indicating links to the existence of organised criminal activities.
• The 125I was deposited on the cards’ suits (e.g., hearts, diamonds or clubs) and on the opposite side of the attenuators (lead or silver), leading to the conclusion that the playing cards were used in a game that had to do with guessing which side the cropped part of the card was flipped. This was facilitated by using a hidden radiation detector, a small ionising camera sensitive to low energies.
• The contaminated cards were wrapped in aluminium foil to minimise the probability of detection during transport, indicating intentional smuggling.
• Potential origins of the 125I were reported as oncology treatment hospitals, laboratories specialised in the radiochemical separation of 125I and research institutes. 125I is primarily produced in research reactors after irradiation of 124Xe with neutrons. Subsequently, it undergoes chemical separation and is used for cancer treatment (e.g., prostate or thyroid cancer).


CHAPTER SIX

6.1 6.2 6.3 6.4 6.5 6.6 6.7 6.8 6.9 6.10
Components of Building the Case
Evidence Admissibility: Crime Scene Management in Support of Prosecution
Evidence Admissibility: Competent Storage and Chain of Custody
Evidence Validation: The Use of the RN Forensics Report
Evidence Validation: Validation and the Use of the Expert Witness
Traditional Forensics in the Contaminated Environment
International Cooperation
Human Rights Considerations
Preliminary Stage Public Communication and Media Management
Case Examples
The need to strengthen investigative capacities and focus the attention of prosecutors on crimes utilising nuclear and other RN materials is determined by the increased social impact of these illicit acts and by the risks and threats to national security, public order and people’s lives and health as a result of their commission. RN crimes are exceptional and most prosecutors (and investigators) will therefore not be familiar with handling such a case. This chapter seeks to guide prosecutors through the inherent complexities, and provide the reader with an organisational framework, should an RN matter arise.
In the course of investigations, criminal prosecutors and the team of investigators, as a rule, focus their attention and efforts on proving the guilt of perpetrators, instigators and accomplices of the crime — i.e., on the enforceability of the prejudicial act — without revealing other potential members of the criminal organisation, such as organisers and those who coordinated and financed the crime. It is necessary to warn prosecutors about the need to expand investigations beyond the ‘visible circle’ of the immediate participants in the commission of these crimes. The suppression of crime entails not only punishing the offenders but also preventing the recurrence of such acts in the future. This underscores the importance of discussing the capacity for further investigation and prosecution with team leaders, police and other involved actors at an early stage, given that complex cases like these may span several years, including the appeal stage.
Depending on the jurisdiction, the police could take the lead as in common law countries. In continental (also known as civil law) systems, particularly in the criminal procedure of the Commonwealth of Independent States, the prosecutor is assigned the primary role in the criminal prosecution phase. Prosecutors typically organise, conduct, coordinate and control the activity of the criminal investigation officers by performing the following tasks:
• Confirming the order to initiate the criminal investigation.
• Approving the plan of criminal investigation actions.
• Exercising the authority, often via writ, to initiate criminal investigation actions and take special investigative measures, obtaining appropriate authorisations from the investigating judge.
In continental systems, the prosecutor, of course, relies on the knowledge and experience of investigators; however, they are primarily responsible for the quality and admissibility of the evidence collected in a criminal case and therefore need basic knowledge themselves. But also, in common law jurisdictions, the prosecutor must have at least basic knowledge of the science of radiological and nuclear materials.
Problems can arise, especially when examining radioactive materials. The expert must hold the right licence for the required type of forensic expertise, so that the evidence will be acceptable in criminal proceedings.
Carrying out criminal proceedings (e.g., coercive measures such as a house search, interception and recording of communications, or
installing electronic surveillance equipment in premises), assumes obtaining judicial authorisation in advance, which will often be at stake. Due to complex criminal procedural regulations, obtaining certain permissions for evidence collection might become excessively bureaucratic in certain jurisdictions, impacting the prompt execution of investigative actions.
The main risks and challenges in criminal investigations are as follows:
• The leakage of operative information about the tactics of the planned investigations and the conduct of criminal proceedings. This may happen because criminal prosecution officers and investigative officers are usually employees of the Ministry of Internal Affairs or Justice, respectively. They are hierarchically subservient to the leaders of these government institutions, having to report their actions not only to the prosecutor, who is in charge of the case, but also to the heads of the subdivisions to which they belong. Consequently, the number of people who know the progress of an investigation (and the prosecution team’s plans) increases. In case of bad faith, this data can reach suspicious persons or those who favoured the preparation or commission of the crime, who, in turn, may take actions aimed at distorting or destroying evidence, avoiding the prosecuting body or the court.
• Because the prosecution officers and the intelligence officers are often employees of different state agencies, primarily concerned with their own institutional interests, the prosecutor, as the leader of the prosecution team, faces great difficulty in ensuring cohesion and effective
collaboration among the members of the investigative team.
• The third challenge for prosecutors is when intelligence services provide insufficient operational information for use as evidence in criminal proceedings. In some jurisdictions, intelligence services officers may be part of the team. Intelligence officers’ reports are often informative in nature and do not necessarily lead to admissible evidence supporting criminal prosecution.
• It is also imperative for intelligence officers involved in the investigation to be trained in criminal procedure so that they may contribute to the criminal justice process and know exactly what must be established and proved by the state in a concrete criminal prosecution. In this respect, prosecutors must guide and coordinate the actions of the intelligence officers. In common law and other jurisdictions, there may be a strict distinction between the role of intelligence services and law enforcement, so they cannot be part of the investigative team; however, they can provide relevant information through the proper channels.
Integrating the evidentiary conclusions from the crime scene investigation is a critical phase for prosecutors, especially regarding the following:
• Revealing all material evidence by stating, determining, preserving, transporting and keeping material evidence in compliance with the rules of the relevant legislation and those regarding the radiological and nuclear safety
of handling substances and objects of increased danger, while tracking exhibits for future submission to judicial authorities.
• Creating a multidisciplinary team for criminal prosecution by prosecutor’s order, or in common law countries, by the (leading) police investigator.
• Prompt elaboration of forensic versions on possible committed actions. Concurrent evaluation of investigative hypotheses developed by subgroups of investigators within a multidisciplinary team, foreclosing the implausible versions and identifying the criminal method of operation in the matter.
• Conducting the investigation according to the forensic hot pursuit method, administrating material samples without delay, identifying the circle of suspects and initiating special surveillance techniques as required.
It should be noted that specialists from the appropriate nuclear and radiological authorities must examine, determine, choose and preserve radiological or nuclear materials. These experts employ special techniques and methods throughout this process. Police (in common law countries) or the criminal prosecutive body (in countries with a continental system) is responsible, in the given case, for recording all actions carried out by the experts in the minutes of the procedural action. In the different jurisdictions, the task of the leading police investigator or prosecutor is to supervise unconditional compliance with the norms of the Criminal Procedural Code when carrying out criminal prosecution actions.
In some jurisdictions, experts, by virtue of the principle of immediacy of judicial investigation, must be presented in court by the prosecutor, so that the judge and all other participants in the case can examine them thoroughly. In cases where experts and their reports on RN materials constitute the sole ‘physical evidence’, this approach is both reasonable and prudent, given the danger associated with radioactive evidence presents.
In the initial stage of any investigation, a plan for criminal police or prosecution actions must be meticulously developed. The formulation of such a plan is determined by the problems that an investigation or inquiry seeks to clarify. Drawing inspiration from Roman jurisprudence, the formula of the seven questions (quis, quid, ubi, quibus auxilis, curr, quomodo and qu’on) aims to clarify the following aspects:
• What act has been committed, and what is its nature?
• Where was or will the crime under investigation be committed?
• When was or will the act be committed?
• Who are the perpetrators and other participants in the commission of the crime?
• How and in what way was the act committed?
• With whose help was it committed?
• What was the purpose of the committed deed?
In the continental law system, the use of technical and scientific means in criminal proceedings is typically explicitly regulated by law. These technologies are permissible in criminal proceedings solely for evidence collection, and specialists involved in the criminal process take responsibility for their utilisation, acting under the order of the prosecutor or the prosecuting magistrate. The status of specialists, along with their rights and obligations, is expressly addressed in most criminal codes. Any technical or scientific means used in criminal proceedings must be official, standardised and recognised in the codes. Violating the provisions of the criminal procedure code related to the use of these means, may result in the inadmissibility of the evidence collected through such means.
Each stage of criminal investigation involves the analysis of the obtained evidence by both the prosecutor and investigators. Based on the conclusions drawn from that stage, the next investigative steps are planned. If the complexity of the case increases, the leading investigator or prosecutor must evaluate the competence and capabilities of the initial police/prosecution team and assess whether the investigators, in the initial composition, possess the requisite skills to address the evolving challenges. Possible solutions include:
• Revision of the composition of the police/prosecution team and potential additional staffing. If the investigation reveals elements of cross-border crimes, it may be necessary to initiate procedures for the provision of international legal assistance in criminal matters (e.g., requests for an international rogatory commission, extradition, transfer of criminal prosecution, etc.).
• Creation of a joint investigation team.
In summary, we can conclude that the prosecutor building a case related to a radiological or nuclear incident, should strive to gain or establish the following elements:
• A comprehensive understanding of applicable legislation prior to any incident or event suggesting a criminal violation, anticipating that those criminal laws addressing radiological and nuclear attacks often involve complex (international) legislation with which most prosecutors have no prior experience.
• Access to case-specific necessary expertise within law enforcement or from academia and sometimes the private sector.
• A well-defined timeline for the case, including the assigning of clearly defined roles among the prosecution/ investigative team.
• The complexities of the case lifecycle, including considering that criminal planning, acquisitions and production may have foreign connections, leading to potential international cooperation.
• Choices must be made at an early stage regarding the disposition of available investigative and prosecutive resources and how that impacts the prosecution through the appeal stage.
• Motive and target considerations are appropriately
reassessed throughout the course of the investigation to ensure that the scope of the attack and its perpetrators are fully known.
Investigators should work closely with prosecutors who have prior experience in building cases involving RN materials. The body of relevant legislation is often specific and nuanced, and the science behind the creation of RN weapons is often complicated, making it challenging to navigate these investigations and prosecutions for those unfamiliar with RN matters.
Meanwhile, it is important for inexperienced prosecutors and investigators to familiarise themselves with various types of RN cases. Law enforcement may initiate an investigation into RN crimes in two different situations:
• When RN material is already seized, law enforcement collects evidence to establish the guilt of the perpetrator.
• When information about RN material or the preparation/ attempt of an RN crime has been received, law enforcement conducts investigative activities to prevent a criminal incident.
In the first situation, RN forensics is a key component of the successful prosecution, while in the second situation (especially during the preparation and attempt stages), crucial support in the courtroom comes from other types of evidence, such as witnesses, digital evidence and information from undercover operations. It is also important to mention RN crimes that are linked to terrorism, in which prosecutors need to prove terrorism intent and collect and demonstrate evidence in this direction.
Crime scene management is requested, administered or overseen, depending on the system, by the investigative authority (prosecutor, judge or law enforcement). This process is essential for establishing the truth by determining or clarifying facts and circumstances at the scene of a potential crime. When nuclear or other radioactive material is present, special radiation protection precautions must be considered. In such situations, personnel authorised to work with nuclear or other radioactive material, following criminal procedural requirements, are responsible for the discovery and collection of items representing potential evidentiary value. Items found at the crime scene that contain traces related to the crime and any other item that can be used to find the truth are considered items of evidence. At a radiological crime scene, items of interest can include nuclear or other radioactive materials themselves or any other item that might be contaminated with radionuclides.
The criminal investigative authorities or the supervising court should consult with subject matter experts and

Figure 6-1. Radiological crime scene management in support of a criminal investigation (provided by IFIN-HH, Romania).
public health authorities to limit access to a radiological crime scene to persons already present at the scene or those entering the scene with proper authorisation. All such entry and exit must be recorded for future judicial examination purposes. They could also prohibit any person from communicating with others regarding the investigation or from leaving before being released by investigators, to preserve the integrity of the witness information.
All steps taken regarding evidence collection must be documented with the intent of supporting the admission of the evidence in court. The criminal investigation authority can manage the radiological crime scene in the presence of witnesses, except when circumstances are prohibitive. On-site investigations are conducted in the presence of the interested parties when necessary and safe. The absence of interested parties does not prevent experts from carrying out the investigation. Often, the criminal investigative body informs those individuals detained or arrested of their right to legal representation; upon request, the investigative body also ensures such representation. In some jurisdictions, the court itself can conduct the crime scene investigation in the presence of interested parties and the prosecutor when their participation in the trial is mandatory, provided it be safe to do so.
To support the eventual admission of the evidence in court, all exhibits of interest must be individually packaged following the
relevant criminal procedures for the collection of RN material and evidence contaminated with radionuclides. A radioactivity label must be placed on every item that was proven to be radioactive. The label must indicate the dose rate and/or level of contamination, as well as the identified radionuclides. Radioactive exhibits must be securely transported in a manner authorised by the competent authority.
The actions performed at the crime scene, the data on the persons involved, the relevant findings and any other relevant information must be summarised in the minutes of the investigation. This report shall be signed by all the competent authorities present at the scene and, if needed, by witnesses.
The findings, clarifications, evaluations and opinions of the expert are recorded in a report. Regarding crimes involving nuclear or other radioactive material, radioactive exhibits cannot be brought into the court of law; therefore, a detailed forensics report describing the findings and conclusions related to the radioactive items will be presented. The nuclear forensics report, upon its completion, is submitted to the investigative authority that requested the forensics analysis. Such a report would normally contain the following:
• Introduction, including the name of the investigative authority that requested the forensic analysis, the date on which the forensic analysis was requested, the personal data of the experts, the objectives and questions the experts will answer, the date on which the analysis was carried out, the items of evidence that were analysed, and the date on which the report was produced.
• Explanatory section, which describes the operations used for the forensics analysis, the methods, computer programs and equipment used.
• Conclusions, which address the objectives and questions established by the investigative authorities, as well as any other clarifications and findings resulting from the forensic analysis of the submitted items.
If the forensic analysis was carried out in the absence of the interested parties, they or their lawyers are informed about the preparation of the forensics report and about their right to study it. This is the case when nuclear or other radioactive material is involved, as its forensic analysis is typically performed in a controlled area with limited access due to safety and security-related procedures implemented by the nuclear facility tasked with conducting the analysis and providing expertise.
The specifics of the nuclear forensics report may require further clarification of its conclusions. The investigative authority and/or the court of law may request the physical presence of an expert to provide or clarify additional details. The forensics report is printed in a limited number of copies and is filed for the long term, both at the authority that requested the report and the facility that produced it.
Crimes involving nuclear or other radioactive materials are rare and unique in nature. Given the limited experience of judiciary systems around the world addressing such crimes, close communication with subject matter experts in this domain becomes essential. Most of the time, a laboratory nuclear forensics report is accompanied by formal and informal communication between lawyers, traditional forensics experts and specialists in the nuclear field. It therefore becomes clear that an expert witness in the court of law is both a requirement and a challenge.
There are a multitude of approaches in the selection of expert witnesses across different jurisdictions. In some cases, experts are selected from a list of experts, which is approved a priori by a competent authority (i.e., ministry of justice). In others, experts are selected directly by the judiciary that adjudicates the competence of a specific expert during the judicial process. In all circumstances, prosecutors should expect all the formalities of a strict criminal proceeding will be followed.
Only highly competent professionals in their field of expertise, impartial, independent and qualified, may qualify as experts. Given the specificity of crimes involving nuclear or other radioactive material, it is often difficult for the investigative authorities to assess the accuracy of the findings, the methodology used and/ or the conclusions presented by the expert. In case of uncertainty, incompleteness of the forensics report, contradictory opinions or
any other aspect that adds doubt to the judicial process, the judicial authorities may request an additional or even a new opinion. Chapter 9 includes more information about the role of the nuclear forensics expert at trial.
According to criminal proceedings within various jurisdictions, expert witnesses have certain rights and obligations. They can refuse to testify in court, be deemed incompatible for appointment, or be designated as experts for specific cases. In some countries, it is even mandatory for an expert to reject an engagement in the event of a conflict of interest, a practice highly recommended in any case. In exceptional circumstances, the expert must be protected against threats of harm from criminals. Given that a very limited number of experts are eligible to testify in the adjudication of crimes involving RN material, prosecutors must diligently ensure that their available pool is thoroughly prepared, vetted and protected before commencing such a prosecution.
Radiological/nuclear expert testimony is one of the most important types of evidence in establishing proof for RN crimes. However, traditional forensics can play a vital role in supporting prosecution. Forensic evidence frequently contributes to establishing the guilt or innocence of potential suspects and can be instrumental in linking crimes believed to be related. The justification for ad-
mitting radiological and traditional evidence into court must be seamlessly integrated.
The international best practice is for traditional evidence at a hazardous crime scene to be collected by forensic experts in their various disciplines who have been trained, qualified and exercised to work in the contaminated environment on contaminated traditional evidence. Even a casual reader can see that this is a resource-intensive, expensive solution for a nation-state. A working alternative is a CBRN team trained in traditional evidence collection methods, which has the benefit of reducing the number of people in the contaminated area. Ordering a traditional forensics team to ‘suit up’ and deploy into a contaminated area on an emergency basis, without the proper training, is to be avoided at all costs for quite obvious reasons.
The increasingly transnational nature of crime means that information, evidence, witnesses or suspects may be located outside the jurisdiction of the country in which the principal offence took place. Effective international cooperation is essential to ensure that offences are investigated fully and that all relevant evidence is available to be put before the tribunal of fact. Differences in laws, procedures and traditions mean that obtaining assistance from another state can be time-consuming, cumbersome and without guarantee of success. It is therefore imperative that prosecutors consider whether it is necessary to seek assistance from another
state as early as possible and keep this under review as the case progresses. Requests for assistance or evidence from another state should only be pursued when the enquiry is reasonable, necessary and proportionate.
International considerations should be integral to a prosecutor’s case strategy from the outset rather than as an afterthought as the case nears trial. Any requests for assistance should be submitted in a timely manner and comply with the rules of the requested state (i.e., the state to whom the request is made) to maximise the likelihood of the request being granted in a reasonable timeframe.
Requests for assistance to another state can be via formal or informal cooperation methods. The extent to which assistance can be provided through informal cooperation depends on multiple factors, including the type of assistance requested and the domestic laws of the requested state. As a rule, informal channels are suitable for acquiring intelligence and information, whereas formal channels are required to obtain evidence intended for use in a criminal trial. It is worth noting that some jurisdictions will provide evidential material via informal cooperation where it can be obtained through non-coercive measures. However, when a judicial order or coercive measures are required to obtain evidence, formal cooperation methods are required.
Informal assistance is the process by which law enforcement or prosecutors contact counterparts or partner agencies directly to obtain information in support of an investigation, usually within a short timeframe. Where the contact is between law enforcement agencies, it is often referred to as police-to-police cooperation. The formal requirements of the mutual legal assistance process do not need to be met. Informal cooperation can be extremely
important in determining the direction and scope of an investigation. Additionally, it is also a useful way to verify facts, such as the existence of a bank account, before a formal request for assistance is made. However, there could be restrictions on the admissibility of information/material obtained informally.
Informal cooperation will normally not be available for any enquiry that requires a coercive measure. Prosecutors should also consider whether the information required is accessible in the public domain. Again, this is a useful way to confirm the existence of information/material before any formal request for assistance is submitted, if required.
Formal legal assistance can take the form of a letters rogatory or a mutual legal assistance request. Both are formal processes of cooperation by which States request and provide assistance in gathering evidence for use in criminal investigations and prosecutions.
The more traditional method of obtaining legal assistance is to submit a letter rogatory to another country to request support. A letter rogatory must be transmitted by the judicial authorities in one country to the judicial authorities in another country via diplomatic channels.
Mutual legal assistance (MLA) requests, also known as letters of request, are directly transmitted between central authorities (i.e., agencies or organisations that are the central point for matters of international cooperation with other states) rather than between judicial authorities using diplomatic channels. Mutual Legal Assistance Treaties (MLATs) are agreements between two or more countries for the purpose of gathering and exchanging information
related to criminal matters. These treaties can be bilateral, regional or multilateral. Multilateral conventions may also provide a basis for the requesting and provision of mutual legal assistance. In addition, some States utilise their domestic law as the foundation for mutual legal assistance, or such assistance may take place based on reciprocity.
Seeking and obtaining assistance through the MLA process can be time-consuming and resource-intensive. It is not always successful due to the requirements that need to be met by the requesting State (i.e., the State seeking the assistance). However, information obtained via an MLA request can be used for evidential purposes, and it is generally the only way to obtain material if coercive measures are required.
The following is a non-exhaustive list of factors that prosecutors should consider when deciding whether to send a letter of request and/or when drafting such a letter:
• Timescales: requests should not be overcomplicated and should avoid asking for extraneous material, as this will increase the time taken to execute the request. Prosecutors should maintain a realistic expectation of the time that it may take to receive a response and so should only ask for material deemed necessary.
• Dual criminality: some States provide assistance only if the alleged conduct constituting the offence in the requesting State is also an offence in the requested State. Prosecutors should assess the underlying conduct of the alleged offence to determine whether dual criminality exists, focusing on the nature of the conduct rather than
attempting to match offence names or categories between jurisdictions.
• Reciprocity: some States may require reciprocity, meaning that under the same conditions and circumstances, the requested State’s future requests for similar assistance to the requesting State would be met.
• Collateral use: in some States, evidence obtained pursuant to an MLA request can only be used for the purpose specified in the original request. Prosecutors should therefore be mindful not to unnecessarily limit the purpose to which the evidence obtained may be used when drafting a request.
• Confidentiality: If confidentiality of the request is sought, it must be expressly requested.
• Causal link: prosecutors must ensure that there is a clear causal link between the facts that form the subject of the investigation or prosecution and the assistance or evidence that is sought. In other words, they should clarify how the requested evidence or assistance is relevant to the case.
• Language: prosecutors should confirm the appropriate language for the letter of request and, if necessary, provide an official translation.
• Data protection: the content and transmission of any letter of request must comply with any domestic or other applicable rules relating to data protection.
• Applicable law: the legal framework governing the execution of a request for legal assistance will be the law of the state where the request is executed. If the requesting state requires the evidence to be obtained in a particular manner, especially where this may not be the usual process in the requested state, the prosecutor must explicitly outline the necessary manner in the letter of request.
Requirements for the content of a request for mutual legal assistance may be determined by a bilateral, regional or multilateral treaty or convention, or by national law. Before drafting a letter of request, it is essential that prosecutors fully understand the requirements of the requested state so that the letter can be formulated clearly and concisely, with all necessary information included in it. Failure to do so will lead to a delay in the execution of the request and may result in refusal. Many jurisdictions now publish guidelines online to assist other jurisdictions in making requests for legal assistance to them. Guides are often available on the websites of central authorities, ministry of foreign affairs, the attorney general’s office or the Director of Public Prosecutions’ (DPP) office for the relevant state. Alternatively, direct communication between prosecutors or central authorities will enable prosecutors to determine what assistance can be sought and by what method.
The nature of the request and the type of assistance sought will also have bearing on the content required for a letter of request. However, as a rule, a request for mutual legal assistance should include the following information:
• Details of the issuing authority.
• Details of the receiving authority.
• Purpose of the request: specifying whether the material is sought for information or evidential purposes.
• Nature of the investigation, prosecution or legal proceedings to which the request relates.
• Legal basis for the request, i.e. bilateral treaty, regional, multilateral treaty or national law.
• Description of the assistance sought.
• Description of the conduct that caused the alleged offence.
• Outline of the essential relevant facts.
• Details (including text) of the statutory provision(s) creating the offence and determining the penalty.
• Clear description of the causal link between the facts and the assistance sought.
• Identity and nationality of the suspect/accused, if known.
• Details of any procedure that the requesting state wishes to be followed in the execution of the request.
• Time frame within which the request is sought to be executed, including full details if urgency is required.
• Confirmation if confidentiality is sought and, if so, on what basis.
• Reciprocity undertaking, if required.
• Transmission details.
• Any other information that is required pursuant to the relevant treaty or convention under which the request is being made.
• Signature of issuing authority.
The type of assistance that can be sought will vary depending on the legal basis for the request and the domestic laws of the requesting and requested States. It may typically include identifying and locating persons, service of process and documents, the taking of evidence, search and seizure, and the restraint, freezing or confiscation of property.
A JIT facilitates the coordination of investigations and prosecutions conducted in parallel in several countries or in cases with a cross-border dimension. A JIT comprises a written legal agreement between the competent authorities of two or more States for the purpose of conducting specific criminal investigations in one or more of the participating States. JITs are typically composed of investigators, prosecutors and judges and are normally established for a fixed period. It is important to note that JITs could also prove beneficial in the appeal stage. JITs allow for the direct gathering and exchange of information and evidence. Members of a JIT are required to carry out their duties in accordance with the national laws of the territory in which investigative measures are taking place.
Information and evidence collected in accordance with the legislation of the participating country in which it was obtained can be shared based on the JIT agreement among the members of the JIT without the need for formal mutual legal assistance processes. JITs also avoid duplication of work, ensure that the conducting of an investigation in one country does not compromise the investigation in another country, help obtain the best evidence and ensure that jurisdictional issues can be considered at an early stage.
Extradition is the formal process by which one state (the requesting state) requests the surrender of a person who is present in another state (the requested state) for the purpose of prosecution, sentencing or carrying out a sentence that has been imposed. Extradition may take place pursuant to a bilateral, regional or multilateral treaty or convention or on a case-by-case basis.
When determining whether to make an extradition request, prosecutors must consider the following:
• Extraditable offence: does the law allow extradition for the offence that is alleged in the extradition request? Extraditable offences may be determined by either a list of offences contained within the applicable extradition treaty or by the penalty that can be imposed on conviction.
• Speciality: the rule of speciality requires that the requested person can only be prosecuted or sentenced for the offence or offences specified in the extradition request.
• Nationality bar: some States will refuse to extradite their own nationals or will only extradite their own nationals based on certain conditions.
Prosecutors should also consider alternatives to extradition, including transfer of proceedings (which may be appropriate if the existence of a nationality bar will prevent extradition) and transfer of sentence.
The importance of establishing direct connections with prosecutorial colleagues in other jurisdictions cannot be underestimated when prosecuting any criminal offence that has an international nexus to it. In the context of seeking informal or formal assistance, it assists prosecutors in understanding the legal system of another jurisdiction and their requirements for making requests for assistance. It also enables prosecutors to follow up on requests for assistance that have been made and for additional information to be sought and provided, if required, for the execution of a request. It enables potential challenges to the execution of a request to be addressed at an early stage, saving time and resources and maximising the prospects of a request being fully executed. It may also obviate the need for a formal request altogether if the information sought can be obtained via informal channels of assistance. Early engagement between prosecutors and a prompt consideration of the international aspects of a case are both essential to ensure expeditious and effective progress of cases with an international nexus.
It is axiomatic that a prosecutor’s role carries great responsibility in both the enforcement of laws and in giving full effect to rights, including human rights. Owing to space constraints, this subchapter does not attempt to cover the full scope of human rights considerations that apply to investigations and prosecutions. Instead, it focuses on internationally recognised standards for prosecutors and demonstrates how those standards of professional conduct are integral to ensuring that human rights are protected and upheld. The principles outlined in this subchapter are of equal applicability to all prosecutors in the discharge of their professional duties regarding the investigation and prosecution of offences, irrespective of the legal system within which they work.
The Universal Declaration of Human Rights (UDHR), proclaimed as a common standard of achievement by the United Nations General Assembly in 1948, contains multiple articles that are of direct applicability to the investigation and prosecution of offences and to the making of requests for mutual legal assistance and extradition. Prosecutors must therefore ensure that they are fully cognisant of these rights at every stage of the investigation and prosecution process and that they uphold the rights enshrined in the UDHR as they conduct all their prosecutorial functions.
The relevant articles are:
• Article 5: No one shall be subjected to torture or to cruel, inhuman or degrading treatment or punishment.
• Article 6: Everyone has the right to recognition everywhere as a person before the law.
• Article 7: All are equal before the law and are entitled without any discrimination to equal protection of the law. All are entitled to equal protection against any discrimination in violation of this Declaration and against any incitement to such discrimination.
• Article 8: Everyone has the right to an effective remedy by the competent national tribunals for acts violating the fundamental rights granted by the constitution or by law.
• Article 9: No one shall be subjected to arbitrary arrest, detention or exile.
• Article 10: Everyone is entitled in full equality to a fair and public hearing by an independent and impartial tribunal in the determination of his rights and obligations and of any criminal charge against him.
• Article 11:
• (1) Everyone charged with a penal offence has the right to be presumed innocent until proved guilty according to law in a public trial at which he has had all the guarantees necessary for his defence.
• (2) No one shall be held guilty of any penal offence on account of any act or omission that did not constitute a penal offence, under national or international law, at the time when it was committed. Nor shall a heavier penalty be imposed than the one that was applicable at the time the penal offence was committed.
To assist prosecutors in protecting and upholding human rights, international organisations have promulgated recognised standards for prosecutors. The Guidelines on the Role of Prosecutors (hereafter ‘the UN Guidelines’) were adopted by the Eighth United Nations Congress on the Prevention of Crime and the Treatment of Offenders in 1990. Their purpose was to assist Member States to secure and promote the effectiveness, impartiality and fairness of prosecutors in criminal proceedings. The UN Guidelines provide guidance relating to the selection, training and status of prosecutors, their expected tasks and conduct, the means to enhance their contribution to the smooth functioning of the criminal justice system, their cooperation with the police, the scope of their discretionary powers and their role in criminal proceedings. In the preamble to the Guidelines, reference was made to the UDHR and, in particular, the principles of equality before the law, the presumption of innocence and the right to a fair and public hearing by an independent and impartial tribunal. It was noted that prosecutors play a crucial role in the administration of justice and that rules concerning the performance of their responsibilities should promote respect for and compliance with the principles to contribute to fair and equitable criminal justice and the effective protection of citizens against crime.
The International Association of Prosecutors (IAP) was established in 1995 as the first global network of prosecutors. One of the most important objectives of the IAP is to ‘promote and enhance those standards and principles which are generally recognised internationally as necessary for the proper and independent prosecution of offences.’ In support of this objective, the IAP Standards of Professional Responsibility and Statement of the Essential Duties and Rights of Prosecutors (‘the IAP Standards’) were developed and adopted by the IAP in 1999. The IAP Standards serve as an
international benchmark for the conduct of individual prosecutors and prosecution services. They are designed to be a working document that prosecuting authorities can use to develop their own standards of practice. The IAP Standards were endorsed by the United Nations Commission on Crime Prevention and Criminal Justice in 2008, and Member States were invited to encourage their prosecution services to take both the UN Guidelines and the IAP Standards into consideration when reviewing or developing rules for prosecutorial conduct in their own countries. Notwithstanding the different legal systems and traditions around the world, the IAP Standards are of general applicability to all prosecutors as they carry out their functions.
The IAP Standards recognise that prosecutors play a crucial role in the administration of justice. They highlight standards of professional conduct to which prosecutors must adhere, including the need to be consistent, independent and impartial, to protect and serve the public interest and to protect the rights of the accused to a fair trial. They outline the role and duties of prosecutors in criminal proceedings and underscore the need for prosecutors to cooperate with other national or international actors in the criminal justice sphere to ensure the fairness and effectiveness of prosecutions. They also require prosecutors to render assistance to the prosecution services of other jurisdictions in accordance with the law and in a spirit of mutual cooperation – highlighting the importance of international collaboration. Finally, the IAP Standards also stress that prosecutors should be protected against arbitrary action by governments and that they are entitled to carry out their professional functions without intimidation, hindrance, harassment or improper interference. A (non-exhaustive) list of fundamental duties and responsibilities of prosecutors, as outlined in the UN Guidelines and the IAP Standards, are detailed below.
Prosecutors must be independent. It is recognised that different legal systems deal with the concept of the independence of prosecutors differently. The critical factor is that a prosecution service must have a sufficient degree of independence to perform its duties free from intimidation, hindrance, harassment, improper interference or unjustified exposure to civil, penal or other liability – in other words, free from all inappropriate outside pressures.
In practice, this means that where prosecutorial discretion is permitted, it should be exercised independently and be free from political or other interference. In jurisdictions where non-prosecutorial authorities have the right to institute or discontinue proceedings or have the right to give instructions to prosecutors, such instructions should be transparent, lawful and subject to guidelines to safeguard both the appearance and fact of prosecutorial independence.
Prosecutors must carry out their functions impartially. Prosecutorial independence is intrinsically linked to the concept of impartiality. To fulfil the role of an independent prosecution service, prosecutors must not be affected by individual, governmental, public, media or other interests as to do so would compromise their independence. In this way, the impartiality of prosecutors is protected.
Prosecutors must also have regard for all relevant circumstances in a case, regardless of whether they are to the advantage or disadvantage of the accused. It is not the role of the prosecutor to secure a conviction in every case at any cost. Instead, a prosecutor must always search for the truth as the guiding objective of any criminal process.
Prosecutors must always conduct themselves professionally. As with any profession, prosecutors have the right to enjoy the private life of their choosing, but they must do so within the boundaries of the law and in accordance with the rules and ethics of their profession. In both their private and public lives, they must demonstrate the highest standards of integrity. Prosecutors must also adhere to their professional responsibilities and rules of conduct as essential mechanisms to protect fundamental human rights. Prosecutors must always protect the right of an accused to a fair trial, always act in accordance with public interest, and always protect and uphold the concepts of human dignity and human rights.
Prosecutors must adhere to the highest levels of professional and ethical standards while fulfilling their role in criminal proceedings. It is recognised that the role that prosecutors perform during the investigative phase of a criminal case will differ depending on the legal framework in each state. However, the principles that apply are of generic application – the obligation to perform duties fairly, consistently and expeditiously and, where prosecutors have an active role in the investigation, to do so objectively, impartially and professionally. Similarly, the tests for admissibility of evidence and the rules governing the presentation of inculpatory and exculpatory material to the accused will differ from state to state. Despite these practical differences, prosecutors must always examine evidence for potential unlawful or inappropriate acquisition. In adherence to international norms, prosecutors should refuse to use evidence against an accused where such evidence is reasonably believed to have been obtained through unlawful means constituting a grave violation of the accused’s human rights. Prosecutors should also disclose relevant prejudicial and beneficial information to an accused as soon as reasonably
practicable and in accordance with the law and the requirements of a fair trial. Prosecutors play a critical role in the administration of justice and the criminal justice system and thus must always be mindful of protecting human rights and acting against those who fail to do so in the investigative or prosecutorial process.
To uphold the fairness of prosecutions, prosecutors must cooperate with other elements of the criminal justice system – the police, the courts, the legal profession and other government agencies – both nationally and internationally. However, this collaboration should not compromise their independence. Given the increasing transnational nature of criminal activity, prosecutors must also assist counterparts in other jurisdictions, in accordance with the law, to progress investigations and prosecutions with an international nexus.
Prosecutors must be empowered. It is the responsibility of the state to ensure that prosecutors can exercise their responsibilities impartially, independently and in line with recognised international standards. Prosecutors must therefore be protected against arbitrary actions by governments and are entitled to minimum standards in relation to their safety and terms of recruitment and employment. Critically, they must be able to perform their professional functions without intimidation or improper interference, ensuring that a fair trial and wider human rights standards are upheld.
Public information and media management are deceptively simple: the public has both the right and desire to know, and the prosecutor has the information and the obligation to inform. Unfortunately, mishandling public information efforts can lead to a failure in meeting obligations and create a lasting negative perception of the prosecuting agency. This brief section does not aim to be exhaustive or cover media messaging during an ongoing crisis. Such efforts will be left to public information professionals, here referred to as public information officers (PIO), or individuals with formal training. This discussion is intended for prosecutors moving into the primary leadership position because a criminal scheme involving nuclear and other RN materials outside of regulatory control has moved into the adjudicative phase.
The prosecutors’ office should have been participating fully with the crisis management public information effort in the event of a completed attack or with the police in the event of a successfully interrupted attack. Coordinating the handover of the primary public information role from the police or other entity holding that position during the crisis phase of the case to the prosecutor’s office PIO, or a prosecutor assigned PIO duties, is a priority. Once in the primary information source position, prosecutors now have a duty to share information, particularly addressing the presence of RN material in the case. After that, there is no need to change normal information-sharing policies for the office. For further discussion on media management during the trial, please refer to Chapter 9.
A justifiable reason should exist when deciding not to share information. Do not disclose information that places individuals in danger. There is no need to share legal strategy, work product, other sensitive information or national classified information. Clear general statements about pending prosecutive actions and the schedule of steps in the adjudication process meet the obligation to disclose information in the pre-trial phase.
Having a dedicated career PIO on staff is a valuable resource for the office. Where this is not possible, training a staff member who has public information responsibilities is essential. Prior to sharing any information, an information plan should be drafted. This can be quite simple, but even a short plan can help keep the office on the same page when dealing with the public. Authorisation from a decision-making supervisor or manager should be obtained prior to dissemination. Continued coordination with inter-ministerial partners is essential.
During this phase, specific information regarding the pending prosecution will most likely not be released. General information addressing the public’s concerns should be shared sympathetically, respectfully and in understandable language, absent of jargon. Thought should be given to the use of social media in reaching the public. Due to the challenges presented by the length and breadth of the social media landscape and the potential for missteps, professional advice should be sought and a social media action plan should be drafted. Then, of course, stick to the plan when posting.
Case Title: Uranium
Date of Investigation:
April – June, 2016
Level
National/Federal
Incident Summary:
Country of Origin: Georgia
Region/State: Tbilisi
Case Category: RADIOLOGICAL/ NUCLEAR
• On April 20, 2016 Georgian law enforcement received information that four citizens of Georgia illegally possessed radioactive material and intended to sell it for USD 4,500,000.
• The State Security Service of Georgia immediately launched investigation under the article 230 of Criminal Code of Georgia, which pertains to illegal handling of nuclear material or equipment, radioactive waste and radioactive substances.
• Investigative and procedural actions carried out:
. Witness interviews;
. Searches and seizures;
. Covert investigative actions (covert audio-video surveillance);
. Embedding undercover agents;
. Forensic examinations.
• During the first stage of the investigation, undercover operations identified five persons, who were involved in illegal handling of nuclear/ radioactive material.
• The material was seized and identified as uranium. The seizure was carried out with the support of specialists from the Nuclear and Radioactive Safety Agency and the material was sent for examination.

• According to the Nuclear Examination Report, the objects seized during the investigation were 81 (eighty-one) cylinder-shaped objects, with the total weight of 1,665.5 grams, which contained two radioactive isotopes of uranium: U238 and U235 belonging to the category of nuclear materials.
• After detention, the mobile phones of the perpetrators were inspected, providing additional information such as images and chats about the material and the people involved.
• The collected evidence, including witness statements and digital evidence, was sufficient to obtain court permission for the detention of the sixth person.
Investigative Focus:
• What type of material was seized?
• How it was transported to Georgia?
• Who was involved in illegal handling of material?
• What was the aim of illegal handling of nuclear material?
Key Points of Evidence:
• Nuclear expert report.
• Witness statements.
• Physical evidence.
• Covert audio-video recordings.
• Digital evidence.
Prosecutorial Priorities:
• Proving that seized objects contained nuclear material.
• Proving all six perpetrators were involved in the illegal storage of nuclear material.
• Identifying additional members of the group.
• Analysing concrete circumstances for future prevention.
Detection Methods:
• The seized objects were examined twice: the first time at the crime scene, when representatives from the Nuclear and Radioactive Safety Agency arrived, used their equipment and determined that the objects contained radioactive material.
• After the seizure, 81 (eighty-one) units of cylinder-shaped objects were sent to the special storage facility and where an expert from the Forensic Department of Ministry of Internal Affairs analysed them and provided a conclusion.
Challenges:
• In the beginning, some of the perpetrators did not confess to the crimes.
• The defence attempted to prove that the objects did not belong to the defendants and they were unaware of the true nature of the material.
• Proving that all of the suspects were involved in the crime with the goal of selling the nuclear material.
Outcomes:
• All six perpetrators were charged under Article 230 of Criminal Code of Georgia (Illegal handling of nuclear material or equipment, radioactive waste and radioactive substances).
• They have all been convicted.
Date of Investigation:
October 2014 –
January 2015
Level: National/Federal
Country of Origin: Republic of Moldova
Region/State: Chisinau
Case Category: RADIOLOGICAL
Incident Summary:
• In December 2013, a citizen of the Republic of Moldova (ROM) organised a sophisticated criminal group to obtain radioactive material for illegal resale.
• The leader of the group directed others to smuggle depleted uranium from Moscow, Russian Federation, to ROM. In March 2014, two members of the group did so by travelling by train to Moscow and, at the railway station, took from an unidentified person 1000 grams of metal, which they knew to be depleted uranium. They carried the radioactive metal to ROM by rail.
• In April of the same year, they transported the radioactive substance to Ukraine, where they attempted to find a potential buyer.
• In December 2014, the members of the group smuggled 200 grams of depleted uranium back into ROM from Ukraine. In Moldova, they attempted to find a potential buyer.
• The information became known to the legal authorities and officers from the General Prosecutor’s Office started a criminal investigation into commission of the crime of smuggling radioactive materials.
• The investigative results and the provision of specialised assistance in the form of expertise in prohibited substances justified a request from the General Prosecutor’s Office to the US FBI for assistance.
• In addition to surveillance operations, an undercover investigation was conducted, with a police officer posing as a buyer of the radioactive material. USD 15,000, provided by FBI special agents, was used for the purchase of the depleted uranium. The FBI agents participated in the investigation, providing expertise and operational support.
• As a result of the investigations, all the persons involved in the commission of the crime were detained and later arrested while in possession of natural uranium in metallic form weighting 5.25 grams and depleted uranium in metallic form weighing 193 grams.
• Depleted uranium poses increased danger and can be used for terrorist purposes.
• During the criminal prosecution and the judicial investigation, the accused persons pleaded guilty. They were sentenced by the court to prison for three years. The convicts filed appeals against the conviction, but their requests were rejected and the prison sentence established by the court was upheld.
• Conduct investigative measures to verify and assess the veracity of the preliminary information developed by the investigating officers.
• In the course of the criminal investigation, it was decided to both visually track the persons involved in the commission of the crime to establish the circle of subjects involved and to use global positioning system (GPS) equipment as well, to intercept telephone conversations and carry out a controlled acquisition of the dangerous substances possessed by the participants in the commission of the crime.
• A police officer was recruited and given operative instructions to infiltrate the organised criminal group, acting as an undercover investigator in the role of a buyer.
• As part of the undercover investigation, a controlled acquisition was carried out, from which the radioactive material was checked, and subsequent search measures were ordered. On-site searches were executed to detect and remove the prohibited materials from the circuit. The offenders were detained and arrested.
• Results of special investigative measures:
. Visual tracking and monitoring of transportation means through GPS.
. Interception and recording of telephone communications and environmental conversations between the undercover investigator and the perpetrators during negotiations the terms of the sale of radioactive materials.
. The UC purchased a control sample, a small part of the radioactive material controlled by the offenders, in return for USD 15,000. The purpose was to obtain a sample for the FBI to analyse pursuant to the investigation.
• Results of prosecution actions:
. Objects and documents obtained during house and vehicle searches.
. Statements of witnesses and the undercover investigator.
. Statements of the defendants.
. Reports and statements of specialists from the National Agency for the Regulation of Nuclear and Radiological Activities.
• Establishing the inter-institutional criminal investigation group and identification of police officers with the necessary experience to investigate such cases.
• Ensuring the confidentiality of the criminal investigation and preventing the leakage of operational information.
• Engaging nuclear and radiological specialists to provide expert conclusions on evidence.
• Securing the assistance of FBI special agents to ensure the success of undercover operations, and provide financial support for a controlled purchase of evidence from the offenders.
• Controlling, coordinating and managing criminal prosecution actions and special investigative measures to ensure compliance with the provisions of the criminal procedure code and ensure the admissibility of evidence.
• Protection of the identity of the undercover investigator and ensuring his safety during the criminal trial.
• Verifying the actions of members of the organised criminal group carried out in the territory of Ukraine and the Russian Federation. Their criminal activity outside of Moldova became known post factum and only from the self-incriminating statements provided by the accused, as it was difficult to investigate and establish their veracity.
• Establishing the origin of the depleted uranium and the circumstances under which the criminals came into possession of it.
Detection Methods
• Undercover investigation.
• Interception and recording of communications.
• Visual tracking and tracking by special technical means.
• Searching homes and vehicles using ionising radiation detection equipment.
• Interrogations of the accused, witnesses and the undercover investigator.
• The conclusions and statements of specialists in the field of nuclear expertise.
Challenges
• Confirming the material was as (criminally) advertised.
• Obtaining the material.
• Collecting sufficient evidence to ensure a guilty verdict.
Date of Investigation: July 2010 –January 2010
Level
National/Federal
Incident Summary:
Country of Origin: Republic of Moldova
Region/State: Chisinau
Case Category: RADIOLOGICAL
• The employees of the General Police Inspectorate (GPI), Ministry of Internal Affairs (MIA), initiated a case focusing on a criminal enterprise which, according to intelligence gathered, sought to smuggle nuclear or other radiological materials.
• The criminals claimed they had smuggled 1.8 kg of 238U into Moldova from Kazakhstan and were willing to sell it for €9 million.
• Based on information gathered by the GPI, under the supervision of the General Prosecutor’s Office, two criminal cases were initiated for smuggling, violating Article 248(5)(b) of the Criminal Code, and manufacture, purchase, processing, storage, transportation, use and neutralization of explosives or radioactive materials, Article 292(1).
• The sophisticated investigative techniques used included two controlled purchases of 238U totalling 0.075 g, which were sent for forensic analysis via the US embassy to the FBI.
• Participating in the operations were four FBI experts who arrived in Chisinau on the day of the offenders’ arrest, representatives from the Emergency Situations Department of the Moldovan MIA, Moldovan Ministry of Defence and the Moldovan state agency regulating nuclear and radiological activity.


• Twelve searches were conducted at homes and auxiliary buildings belonging to the defendants, including the garage owned by the Moldovan citizen (the retired police lieutenant colonel). The searches yielded the following items:
. Approximately 620 rounds of two types of ammunition for AK-74 assault rifles and combat pistols;
. F-1 hand defensive fragmentation grenades;
. A combat pistol;
. Various vehicle licence plates from different jurisdictions, including Moldova, EU countries and the no longer existent Soviet Union (USSR);
. Soviet-type passports and birth certificates, totalling 3,300 pieces;
• At the same person’s home, a revolver, six cartridges for a gas pistol, two cartridges for a semi-automatic pistol, and hidden communications equipment;
• Experts from the Moldovan National Agency for Regulation of Nuclear and Radiological Activity along with the Emergency Situations Department of the MIA, confirmed that the seized uranium was 238U. While naturally occurring, 238U can be used to create an area of radiation contamination.
• The evidence was taken by the Emergency Situations Department and is now stored as radioactive waste.




• Intelligence officers identified an organised crime cell, consisting of citizens of the Republic of Moldova, offering to sell radioactive material on the black market.
• Led by the General Prosecutor’s Office, a criminal investigation was initiated for crimes related to smuggling and possession of radioactive materials. A team of prosecutors and criminal investigation officers was formed.
• Investigative measures were undertaken to verify and assess the veracity of the preliminary information held by investigators.
• In the framework of the criminal investigation, it was decided to trace (visual tracking) the persons involved in the crime to establish the circle of subjects involved, to intercept their telephone conversations, and conduct a controlled acquisition of an evidentiary sample for laboratory analysis of the dangerous substances possessed by the participants.
• The selection of the police officer to act as an undercover investigator, playing the role of a buyer, and development of the officer’s cover story for infiltrating the organised crime group.
• As part of the undercover investigation, a controlled acquisition was carried out and radioactive material was checked. Subsequently, a search was ordered and on-site searches were conducted to detect and remove prohibited materials (explosives and radioactive materials). The offenders were detained and arrested.
• Results of the special investigation:
. Physical surveillance;
. Interception and recording of telephone communications;
. Interception and recording of in-person conversations between the undercover investigator and the perpetrators during the negotiations for sale of the radioactive materials;
. Controlled purchase of a portion of the radioactive material.
• Results of the prosecution actions:
. Objects and documents obtained during house and vehicle searches;
. Statements from witnesses and the undercover investigator;
. Statements from the defendants;
. Reports and statements from specialists from the Moldovan National Agency for Regulation of Nuclear and Radiological Activity.
• Identifying nuclear and radiological specialists who could providing expert conclusions on objects raised as corpus delicti.
• Engaging FBI special agents to ensure the success of the undercover operations.
• Controlling, coordinating and managing criminal prosecutive actions and special investigative measures to ensure compliance with the provisions of the criminal procedure code and ensure the admissibility of evidence.
• Supervising the actions of the investigating officers to exclude actions that could be considered provocation to commit the crime (entrapment).
• Establishing the origin of the depleted uranium and the circumstances under which the criminals came into possession of it.
• Undercover investigation.
• Interception and recording of communications.
• Visual tracking through special technical means.
• Searching homes and vehicles using ionising radiation detection equipment.
• Interrogations of the accused, witnesses and the undercover investigator.
• The conclusions and statements of specialists in the field of nuclear expertise.
Challenges
• Ensuring the confidentiality of the criminal investigation and avoiding leaks of operative information.
• Protecting the identity of the undercover investigator and ensuring his safety during the criminal trial.
Outcomes
• The criminal case was submitted in court, resulting in a three-year prison sentence for the first defendant, a two-year prison term for the second, and one-and-a-half-year sentence for the third. The latter was based on a plea bargain agreement signed by the defendant.
1. Romanian Criminal Procedural Code, Art. 173, Art. 178, Art. 192.
2. United Nations. Guidelines on the Role of Prosecutors, UN Guidelines (1990).
3. IAP. Standards of Professional Responsibility and Statement of the Essential Duties and Rights of Prosecutors: IAP Standards, (1999).
4. The Status and Role of Prosecutors: A UNODC and IAP Guide: UNODC and IAP Guide (2014).
5. IAP Human Rights Manual for Prosecutors: IAP Human Rights Manual, 1st edition (2003) 2nd completely revised edition (2009).
6. Federal Emergency Management Agency. National Incident Management System Basic Guidance for Public Information Officers, FEMA, Washington (2020).


CHAPTER SEVEN

International Legal Frameworks Compacts
Incorporation into Legislative Frameworks
Criminal Jurisdiction and Legislation
Offences Under International Legal Instruments Relating to Radiological and Nuclear Crimes
Jurisdiction Under International Instruments Relating to Radiological and Nuclear Crimes
While the responsibility for establishing appropriate measures for the prevention and suppression of radiological and nuclear crimes at the national level rests with the government of each State, the effectiveness of the measures taken will ultimately depend on other States having in place equally adequate measures, as well as the level of cooperation among the different States involved. One of the objectives of the international legal framework is to facilitate the harmonisation of the different types of measures required to address the threat of radiological and nuclear crimes.
The international legal framework currently primarily consists of the following legally binding instruments: four conventions, one amendment, two protocols and of two United Nations Security Council resolutions issued under Chapter VII of the United Nations Charter. These instruments are part of the international legal instruments against terrorism. Also, crucial components of the international legal framework are legally non-binding instruments in the area of nuclear security, namely the Code of Conduct on the Safety and Security of Radioactive Sources, as well as international consensus guidance on all aspects of nuclear security developed under the auspices of the International Atomic Energy Agency (IAEA). The adoption of the various instruments spans over a twenty-five year period, addressing evolving trends and needs. The resulting instruments are thus supplementary to each other. In cases where conduct qualifies as an offence in several instruments, it will be the responsibility of prosecutors to determine where the gravest threat to the community was posed in order to determine the applicable charges.
Among the various outcomes of the first Review Conference of the Parties to the Treaty on the Non-Proliferation of Nuclear Weapons in May 1975, was the declaration calling upon all States engaging in peaceful nuclear activities to enter into such international agreements and arrangements as may be necessary to ensure the proper protection of nuclear material. The Convention on the Physical Protection of Nuclear Material (CPPNM) was adopted in October 1979 after two years of negotiations. The CPPNM entered into force on February 8, 1987. Its depositary is the Director General of the IAEA. The Convention has a threefold scope of application, establishing obligations for Parties with respect to: the physical protection of nuclear material used for peaceful purposes during international nuclear transport and storage incidental to that transport; the criminalisation of offences involving nuclear material; and international cooperation, for example, in the case of theft, robbery or any other unlawful taking of nuclear material or credible threat thereof.
The 1992 Review Conference of the Parties to the CPPNM found the Convention to be adequate. However, in the following years, it was determined that there was a need to revise the Convention in order, inter alia, to strengthen the international physical protection regime. In July 2005, States Parties to the CPPNM unanimously adopted an Amendment to the CPPNM, which entered into force on May 8, 2016. The Amendment to the CPPNM strengthens the original CPPNM in a number of important ways. It requires Parties to establish a physical protection regime for all nuclear material and nuclear facilities used for peaceful purposes under
their jurisdiction. It also expands on the list of offences under the Convention, adding offences related to illicit trafficking and sabotage. The Amendment further provides for strengthened international cooperation in light of the expanded scope, such as assistance and information sharing in the event of sabotage.
The Amendment to the CPPNM was the first instrument to establish nuclear smuggling as an offence. By making it a stand-alone offence, the Amendment to the CPPNM conveys the seriousness of the offence and the need for States to criminalise the smuggling of nuclear material separately and with appropriate penalties.
By the mid-1990s, different international legal instruments dealing with counter-terrorism had addressed acts such as hostage-taking, hijacking or acts against the safety of air or maritime navigation, but had not specifically addressed terrorist bombings as such. Thus, a series of bombings in 1995 and 1996 in different parts of the world led to the adoption of the International Convention for the Suppression of Terrorist Bombings (also referred to as ‘Terrorist Bombings Convention’) in December 1997. The Terrorist Bombings Convention entered into force on May 23, 2001. Its depositary is the United Nations Secretary-General.
The negotiations for the International Convention for the Suppression of Acts of Nuclear Terrorism (ICSANT) were initiated to address gaps in the international legal framework for preventing
and responding to acts of nuclear terrorism. The CPPNM was limited to the transportation of nuclear material used for peaceful purposes and did not address other radioactive material, nuclear material of military origin and the associated sites and facilities, including military sites and facilities, where nuclear and/or other radioactive material was produced, stored, processed, or transported. ICSANT overlaps in some provisions with the CPPNM, broadening the definition of nuclear facility and adding the requirement of a specific intent in order for an act to be qualified as an offence. ICSANT was adopted by the General Assembly in April 2005 after seven years of preparatory work. It entered into force on 7 July 2007. Its depositary is the United Nations Secretary-General.
After the attacks on targets in the United States on September 11, 2001, the International Civil Aviation Organization (ICAO) Assembly adopted a resolution directing the ICAO Council and its Secretary General ‘to address the new and emerging threats to civil aviation, in particular to review the adequacy of the existing aviation security conventions.’ The Convention on the Suppression of Unlawful Acts Relating to International Civil Aviation (2010 Beijing Convention) was adopted in September 2010. Among States parties, its provisions prevail over those of the 1971 Montreal Convention and the 1988 Airport Protocol. The Beijing Convention introduces new offences related to biological, chemical and nuclear (BCN) weapons and radioactive substances which were not included in previous aviation instruments. It is therefore the first international legal instrument specifically addressing the prevention and suppression of aviation-related CBRN terrorism.
Protocol to the 1988 Convention for the Suppression of Unlawful Acts Against the Safety of Maritime Navigation and Protocol to the 1988 Protocol for the Suppression of Unlawful Acts Against the Safety of Fixed Platforms Located on the Continental Shelf
The main purpose of the 1988 Convention was to ensure that appropriate action is taken against persons committing unlawful acts against ships. These include the seizure of ships by force; acts of violence against persons on board ships; and the placing of devices on board a ship which are likely to destroy or damage it. The 1988 Protocol adapted those provisions to fixed platforms on the continental shelf. However, the continued vulnerability of maritime transport to terrorist attacks was demonstrated by the bombing in February 2004 of the vessel MV SuperFerry 14 in the Philippines. Considerations for amending the 1988 Convention and its relevant Protocol coincided with the international community focusing efforts on the control of biological, chemical, radiological and nuclear weapons, including through deliberations on and subsequent adoption of Security Council resolution 1540.
Under the auspices of the International Maritime Organization (IMO), amendments to the 1988 Suppression of Unlawful Acts (SUA) Convention and to the SUA Protocol were adopted in October 2005. The 2005 IMO instruments introduce new offences relating to biological, chemical and nuclear (BCN) weapons and nuclear and other radioactive material, and are therefore the first international legal instruments dealing with the prevention and suppression of maritime-related CBRN terrorism. According to Article 15 of the 2005 Protocol, the Protocol is to be read and interpreted between its States parties as a single instrument together with the 1988 SUA Convention, and the new 2005 provisions together with the
revised articles of the 1988 SUA Convention are to be referred to as the ‘Convention for the Suppression of Unlawful Acts against the Safety of Maritime Navigation, 2005’, abbreviated as ‘2005 SUA Convention’.
Protocols can also be modified, as with the 2005 Protocol to the Protocol for the Suppression of Unlawful Acts against the Safety of Fixed Platforms Located on the Continental Shelf (2005 SUA Protocol). Similar to the 2005 SUA Convention, the 2005 Protocol to the Protocol for the Suppression of Unlawful Acts against the Safety of Fixed Platforms Located on the Continental Shelf updates the 1988 Protocol, to the extent appropriate to its more limited subject matter, in some of the same ways the 2005 SUA Convention updates the 1988 SUA Convention.
Security Council resolution 1373 (2001) was adopted shortly after the terrorist attacks of September 11, 2001 in the United States of America, under chapter VII of the United Nations Charter. This chapter empowers the UN Security Council (UNSC) to adopt measures legally binding on all UN Member States concerning threats to the peace, breaches of the peace, and acts of aggression. Resolution 1373 is not limited to condemning specific manifestations of terrorism in certain parts of the world, but addresses terrorism as a general phenomenon. It establishes a framework for improved international cooperation against terrorism. The resolution notes with concern the close connection between international terrorism and the illegal movement of nuclear, chemical, biological, and other potentially lethal materials. In this regard, it emphasises the need to enhance coordination efforts on national, subregional, regional, and international levels to strengthen a global response to this serious challenge and threat to international security.
The United Nations Security Council adopted resolution 1540 unanimously on 28 April 2004 under chapter VII of the United Nations Charter. It is the first Security Council resolution to focus on the potential acquisition of weapons of mass destruction by Non-State Actors. The resolution affirms the ‘proliferation of nuclear, chemical and biological weapons, as well as their means of delivery, constitutes a threat to international peace and security.’ Resolution 1540 (2004) purposely attempts to address threats not covered by the existing non-proliferation instruments, particularly those associated with illicit trafficking in nuclear, chemical and biological weapons, their means of delivery, and related materials. These are identified as a new dimension in proliferation.
Resolution 1540 also calls upon States to promote cooperation on non-proliferation. It affirms support for the multilateral treaties aimed at eliminating or preventing the proliferation of weapons of mass destruction (WMD) and underscores the importance for all Member States to implement them fully. Implementing the criminalisation provisions of the other international legal instruments mentioned in this chapter is one step that Member States may take towards fulfilling their criminalisation obligations under resolution 1540.
The IAEA issued the Code of Conduct on the Safety and Security of Radioactive Sources in 2004 to assist countries tackle risks and protect people and the environment from accidental radiation exposure or intentional unauthorised acts involving radioactive sources. Following the terrorist attacks on September 11, 2001, the Code’s provisions relating to the security of sources were strengthened. The Code addresses materials beyond the scope of
application of the CPPNM and its Amendment, which apply only to nuclear material, except for sources incorporating plutonium-239.
Among its provisions, the Code stipulates that Member States should establish an effective national legislative and regulatory system to control the management and protection of radioactive sources. This system should include measures to reduce the likelihood of malicious acts, including sabotage, consistent with the threat defined by the Member State. Additionally, it should mitigate or minimise the radiological consequences of accidents or malicious acts involving radioactive sources.
In international law, compacts can be broadly defined. For our purposes, a compact is a prescribed agreement between countries undertaken to establish mutual obligations and responsibilities without the formalities of treaty negotiations and ratifications. Regarding nuclear and other radiological materials (RN) and their potential illegal use, the three most significant compacts are the Zangger Committee, the Nuclear Suppliers Group and the Wassenaar Arrangement.
The Zangger Committee, sometimes referred to as the ‘Nuclear Non-Proliferation Treaty (NPT) Exporters Committee’, assists members in complying with the export controls memorialised in the NPT in Article III, Paragraph 2. This treaty obligation requires signatories to export nuclear material of concern and pertinent specialised equipment only to non-nuclear States, subject to the
safeguards of the NPT. The Committee, established in 1971 and chaired by Prof. Claude Zangger of Switzerland. The attendees committed themselves to an informal status and to consensus-based decisions, which would be non-binding. The Committee was tasked with the creation of a ‘trigger list’ encompassing source or special fissionable materials and equipment or materials designed for the processing, use, or production of such materials.
According to Article III.2 of the Nuclear Non-Proliferation Treaty (NPT), these items must be subject to the IAEA safeguards when provided by NPT parties to non-nuclear weapon States (NNWS). The objective is to prevent the diversion of material and equipment exported for peaceful purposes from that goal. In 1974, the Zangger Committee issued the Trigger List, specifying items that would activate a requirement for safeguards and guidelines (‘common understandings’) governing their export to NNWS not party to the NPT. The Zangger Committee Trigger List serve as a resource for prosecutors, investigators and analysts working in this area. The list and related guidance are published by the IAEA in the Information Circular (or INFCIRC) INFCIRC/209 series. Legally, States accepted these decisions via direct, unilateral communications. Legal authority arises from adoption of the Zangger Committee decisions into national legislation.
The Zangger Committee Member States are: Argentina, Australia, Austria, Belarus, Belgium, Bulgaria, Canada, China, Croatia, Czech Republic, Denmark, Finland, France, Germany, Greece, Hungary, Ireland, Italy, Japan, Kazakhstan, Republic of Korea, Luxembourg, The Netherlands, New Zealand, Norway, Poland, Portugal, Romania, Russian Federation, Slovakia, Slovenia, South Africa, Spain, Sweden, Switzerland, Türkiye, Ukraine, United Kingdom and United States of America. The EU is a permanent observer. The Committee maintains a website at: https://zanggercommittee.org/.
The Nuclear Suppliers Group (NSG) focuses on contributing to the non-proliferation of nuclear weapons through consensus-based guidelines concerning nuclear trade. While the NSG has been in existence since 1975, in 1994 the NSG adopted the ‘non-proliferation principle,’ stipulating that sellers should only participate in a transaction when certain that the sale will not contribute to the further proliferation of nuclear weapons. The work of the NSG primarily falls in two main areas: nuclear transfers and transfers of nuclear-related dual-use equipment, materials, software, and related technology. The guidelines are published by the IAEA and can be found in INFCIRC/254, Parts 1 and 2, respectively.
In a regularly scheduled series of meetings, the NSG deliberates on the dissemination of information to support non-proliferation and facilitate trade. Decisions are made through a consensus-based approach and published. Authority and enforcement are through the adoption of these decisions into individual State legislative frameworks.
Participating Governments in the NSG are: Argentina, Cyprus, Ireland, New Zealand, South Africa, Australia, Czech Republic, Italy, Norway, Spain, Austria, Denmark, Japan, Poland, Sweden, Belarus, Estonia, Kazakhstan, Portugal, Switzerland, Belgium, Finland, Latvia, Romania, Türkiye, Brazil, France, Lithuania, Republic of Korea, Ukraine, Bulgaria, Germany, Luxembourg, Russia, United Kingdom, United States of America, Canada, Greece, Malta, Serbia, China, Hungary, Mexico, Slovakia, Croatia, Iceland, Netherlands and Slovenia. The EU and Zangger Committee are observers. The NSG maintains a website at https://nuclearsuppliersgroup.org.
The Wassenaar Arrangement (WA) is dedicated to promoting transparency and responsibility in transfers of conventional arms
and dual-use goods and technologies. RN materials and equipment often fall into the dual-use category. The WA organises goods into two lists: the List of Dual-Use Goods and Technologies and the Munitions List. Through these lists, the WA supports the measures of Member States with guidelines, elements and procedures for translating WA goals and objectives into national frameworks. Bodies within the WA include a General Working group and an Experts group, as well as a regular Licensing and Enforcement Officers Meeting. Participants, through their national policies, ensure that transfers of conventional arms and dual-use goods do not contribute to the development or enhancement of destabilising military capabilities and are not diverted to support such capabilities. Simultaneously, they work to prevent the acquisition of these items by terrorists.
Established in 1995, the WA grew out of a previous cold war era international body and today concentrates specifically on the exports of dual-use goods and related items. The WA Control Lists cover military equipment and twelve categories of dual use goods and technologies. Authority and enforcement are executed through the adoption of concepts into Member State legislative schemes.
The Participating States are: Argentina, Australia, Austria, Belgium, Bulgaria, Canada, Croatia, Czech Republic, Denmark, Estonia, Finland, France, Germany, Greece, Hungary, India, Ireland, Italy, Japan, Latvia, Lithuania, Luxembourg, Malta, Mexico, Netherlands, New Zealand, Norway, Poland, Portugal, Republic of Korea, Romania, Russian Federation, Slovakia, Slovenia, South Africa, Spain, Sweden, Switzerland, Türkiye, Ukraine, United Kingdom and United States. The WA maintains a website at https://www. wassenaar.org.
A key feature in many international legal instruments against terrorism is an obligation that generally requires States Parties to establish specific acts identified in the instruments as criminal offences in their national law. The provisions creating these offences share several common features, summarised as follows:
1. Each criminal conduct is defined according to its objective and material elements (actus reus, e.g., causing destruction, placing explosives, seizing aircraft or ships, etc.). In some cases, a further constituent element of a crime is the creation of danger, regardless of whether the causation of such danger was intentional. (For example, not all acts of violence committed on board an aircraft are covered by the Convention for the Suppression of Unlawful Acts against the Safety of Civil Aviation, the relevant offence only includes those likely to endanger the safety of the aircraft in flight). The international legal instruments against terrorism do not define ‘terrorist acts’ and do not always require terrorist motivation as a conditio sine qua non for the criminalisation of certain conduct. Only in certain cases is the terrorist motivation an element of the offence, introduced as the intent ‘to compel a natural or legal person, international organisation or State to do or to refrain from doing any act’ or ‘to intimidate a population, or to compel a government or an international organisation to do or to abstain from doing any act’.
2. The subjective and intentional element (mens rea) included within the offence-creating provisions generally requires that the offence be committed ‘intentionally’. This ‘general’ intention is often accompanied by a ‘special’ one (for example, the additional intention of the perpetrator to cause death or serious bodily injury).
3. The instruments further obligate States parties to establish the acts defined as criminal offences under their domestic law, including ancillary offences such as attempt and complicity (aiding and abetting).
4. The International Convention for the Suppression of Terrorist Bombings, the International Convention for the Suppression of Acts of Nuclear Terrorism, the Amendment to the Convention on the Physical Protection of Nuclear Material, and the civil aviation and maritime security instruments mentioned in this chapter contain additional criminalisation requirements related to the contribution to the commission of offences by a group of persons acting with a common purpose.
5. The instruments do not prescribe specific penalties but instead require that the offences be made punishable by appropriate penalties that take into account their grave nature.
One of the primary objectives of the international legal instruments against terrorism is to ensure that as many States Parties as possible have jurisdiction to prosecute the offences defined by these instruments, in order to avoid the creation of safe havens. These instruments advance this goal through provisions that obligate State Parties to establish jurisdiction over defined offences in various circumstances. Generally, under these instruments, States Parties are required to establish jurisdiction when the offence is committed within the territory of the State, on board a vessel flying the flag of that State or on an aircraft registered in that State. They also mandate jurisdiction when the offence is committed by a national of that State. These are often referred to as mandatory bases for jurisdiction, which means that States Parties are obligated to incorporate them into their national laws.
These instruments also impose an obligation to establish jurisdiction over offences when the alleged offender is present in a State Party’s territory which does not grant extradition upon request by another State Party that has jurisdiction. Additionally, the instruments provide various optional jurisdictional grounds, such as the passive nationality principle, whereby State Parties could establish jurisdiction over offences committed abroad against one of their nationals.
All international legal instruments against terrorism except UNSC resolutions, incorporate an obligation known as ‘aut dedere aut

judicare’ — to extradite or prosecute. The relevant provisions state that, whenever the extradition of an individual present in a State Party’s territory is requested, that State must either hand over the person concerned to the requesting State Party or submit the case to the competent domestic authorities for prosecution.
For example, the Terrorist Bombings Convention (along with other instruments using identical or very similar language) provides in paragraph 1 of its Article 8 that a State Party failing to extradite a person to a requesting State Party shall ‘be obliged, without exception whatsoever and whether or not the offence was committed in its territory, to submit the case without undue delay to its competent authorities for the purpose of prosecution, through proceedings in accordance with the laws of that State. Those authorities shall take their decision in the same manner as in the case of any other offence of a grave nature under the law of that State’.
The international legal instruments against terrorism do not address which State agency will have the responsibility to prosecute a case. This aspect is left for each State Party to decide individually. For example, States may choose to centralise the prosecution of terrorism-related offences through specialized units or distribute the workload in different ways. Such decisions are based entirely on domestic policies.
The added value of international legal instruments against terrorism in the field of extradition includes the following:
• The offences set forth in the international counter-terrorism instruments are deemed to be included as extraditable offences in any existing extradition treaty between States Parties.
• States Parties commit to including these offences as extraditable offences in any future extradition treaty they may concluded between them.
• States Parties that do not make extradition conditional on the existence of a treaty are required to consider the offences set forth in international legal instruments against terrorism as extraditable offences between themselves.
• States Parties that normally require a treaty as a condition for extradition may, at their discretion, use the international instrument as a legal basis for extradition when a request is made by another State Party.
• All extradition treaties and arrangements between States Parties to the same international instrument regarding the
relevant offences are ‘deemed to be modified’ if they are incompatible with that international instrument.
• States Parties are prohibited from rejecting another State Party’s extradition request (concerning any conventionbased offence) on the grounds that it concerns a political offence, an offence connected with a political offence or an offence with political motives. This prohibition is in place because none of the defined offences are to be regarded as political for extradition purposes.
• Nothing in the instruments imposes an obligation on States Parties to extradite (concerning any offence established by the instruments) if the requested Party has substantial grounds for believing that the request was made for the purpose of prosecuting or punishing a person because of his or her race, religion, nationality, ethnic origin or political opinion, or if his or her position would be prejudiced for that reason.
The intentional commission of:
(a) An act without lawful authority which constitutes the receipt, possession, use, transfer, alteration, disposal or dispersal of nuclear material and which causes or is likely to cause death or serious injury to any person or substantial damage to property;
(b) A theft or robbery of nuclear material;
(c) An embezzlement or fraudulent obtaining of nuclear material;
(d) An act constituting a demand for nuclear material by threat or use of force or by any other form of intimidation;
(e) A threat:
(i) To use nuclear material to cause death or serious injury to any person or substantial property damage, or
(ii) To commit an offence described in subparagraph (b) in order to compel a natural or legal person,
international organisation or State to do or to refrain from doing any act;
(f) An attempt to commit any offence described in subparagraphs (a), (b) or (c); and
(g) An act which constitutes participation in any offence described in subparagraphs (a) to (f) shall be made a punishable offence by each State Party under its national law.
1. Any person commits an offence within the meaning of this Convention if that person unlawfully and intentionally delivers, places, discharges or detonates an explosive or other lethal device in, into or against a place of public use, a State or government facility, a public transportation system or an infrastructure facility:
(a) With the intent to cause death or serious bodily injury; or
(b) With the intent to cause extensive destruction of such a place, facility or system, where such destruction results in or is likely to result in major economic loss.
2. Any person also commits an offence if that person attempts to commit an offence as set forth in paragraph 1.
3. Any person also commits an offence if that person:
(a) Participates as an accomplice in an offence as set forth in paragraph 1 or 2; or
(b) Organises or directs others to commit an offence as set forth in paragraph 1 or 2; or
(c) In any other way contributes to the commission of one or more offences as set forth in paragraph 1 or 2 by a group of persons acting with a common purpose; such contribution shall be intentional and either be made with the aim of furthering the general criminal activity or purpose of the group or be made in the knowledge of the intention of the group to commit the offence or offences concerned.
1. Any person commits an offence within the meaning of this Convention if that person unlawfully and intentionally:
(a) Possesses radioactive material or makes or possesses a device:
(i) With the intent to cause death or serious bodily injury; or
(ii) With the intent to cause substantial damage to property or to the environment;
(b) Uses in any way radioactive material or a device, or uses or damages a nuclear facility in a manner which releases or risks the release of radioactive material:
(i) With the intent to cause death or serious bodily injury; or
(ii) With the intent to cause substantial damage to property or to the environment; or
(iii) With the intent to compel a natural or legal person, an international organisation or a State to do or refrain from doing an act.
2. Any person also commits an offence if that person:
(a) Threatens, under circumstances which indicate the credibility of the threat, to commit an offence as set forth in paragraph 1 (b) of the present article; or
(b) Demands unlawfully and intentionally radioactive material, a device or a nuclear facility by threat, under circumstances which indicate the credibility of the threat, or by use of force.
3. Any person also commits an offence if that person attempts to commit an offence as set forth in paragraph 1 of the present article.
4. Any person also commits an offence if that person:
(a) Participates as an accomplice in an offence as set forth in paragraph 1, 2 or 3 of the present article; or
(b) Organises or directs others to commit an offence as set forth in paragraph 1, 2 or 3 of the present article; or
(c) In any other way contributes to the commission of one or more offences as set forth in paragraph 1, 2 or 3 of the present article by a group of persons
acting with a common purpose; such contribution shall be intentional and either be made with the aim of furthering the general criminal activity or purpose of the group or be made in the knowledge of the intention of the group to commit the offence or offences concerned.
1. The intentional commission of:
(a) an act without lawful authority which constitutes the receipt, possession, use, transfer, alteration, disposal or dispersal of nuclear material and which causes or is likely to cause death or serious injury to any person or substantial damage to property or to the environment;
(b) a theft or robbery of nuclear material;
(c) an embezzlement or fraudulent obtaining of nuclear material;
(d) an act which constitutes the carrying, sending, or moving of nuclear material into or out of a State without lawful authority;
(e) an act directed against a nuclear facility, or an act interfering with the operation of a nuclear facility, where the offender intentionally causes, or where he knows that the act is likely to cause, death or
serious injury to any person or substantial damage to property or to the environment by exposure to radiation or release of radioactive substances, unless the act is undertaken in conformity with the national law of the State Party in the territory of which the nuclear facility is situated;
(f) an act constituting a demand for nuclear material by threat or use of force or by any other form of intimidation;
(g) a threat:
(i) to use nuclear material to cause death or serious injury to any person or substantial damage to property or to the environment or to commit the offence described in sub-paragraph (e), or
(ii) to commit an offence described in sub-paragraphs (b) and (e) in order to compel a natural or legal person, international organisation or State to do or to refrain from doing any act;
(h) an attempt to commit any offence described in subparagraphs (a) to (e);
(i) an act which constitutes participation in any offence described in subparagraphs (a) to (h);
(j) an act of any person who organises or directs others to commit an offence described in sub-paragraphs (a) to (h); and
(k) an act which contributes to the commission of any offence described in subparagraphs (a) to (h) by a group of persons acting with a common purpose; such act shall be intentional and shall either:
(i) be made with the aim of furthering the criminal
activity or criminal purpose of the group, where such activity or purpose involves the commission of an offence described in sub-paragraphs (a) to (g), or
(ii) be made in the knowledge of the intention of the group to commit an offence described in sub-paragraphs (a) to (g)
shall be made a punishable offence by each State Party under its national law.
Article 3bis
1. Any person commits an offence within the meaning of this Convention if that person unlawfully and intentionally:
(a) When the purpose of the act, by its nature or context, is to intimidate a population, or to compel a government or an international organisation to do or to abstain from doing any act:
(i) uses against or on a ship or discharges from a ship any explosive radioactive material or BCN weapon in a manner that causes or is likely to cause death or serious injury or damage; or
(ii) discharges, from a ship, oil, liquefied natural gas, or other hazardous or noxious substance, which
is not covered by subparagraph (a)(i), in such quantity or concentration that causes or is likely to cause death or serious injury or damage; or
(iii) uses a ship in a manner that causes death or serious injury or damage; or
(iv) threatens, with or without a condition, as is provided for under national law, to commit an offence set forth in subparagraph (a)(i), or (iii); or
(b) Transports on board a ship:
(i) any explosive or radioactive material, knowing that it is intended to be used to cause, or in a threat to cause, with or without a condition, as provided for under national law, death or serious injury or damage for the purpose of intimidating a population, or compelling a government or an international organisation to do or to abstain from doing any act; or
(ii) any BCN weapon, knowing it to be a BCN weapon as defined in Article 1; or
(iii) any source material, special fissionable material, or equipment or material especially designed or prepared for the processing, use or production of special fissionable material, knowing that it is intended to be used in a nuclear explosive activity or in any other nuclear activity not under safeguards pursuant to an IAEA comprehensive safeguards agreement; or
(iv) any equipment, materials or software or related technology that significantly contributes to the design, manufacture or delivery of a BCN
weapon, with the intention that it will be used for such purpose.
Any person commits an offence within the meaning of this Convention if that person unlawfully and intentionally transports another person on board a ship knowing that the person has committed an act that constitutes an offence set forth in Article 3, 3bis or 3quater or an offence set forth in any treaty listed in the Annex, and intending to assist that person to evade criminal prosecution.
Any person also commits an offence within the meaning of this Convention if that person:
(a) Unlawfully and intentionally injures or kills any person in connection with the commission of any of the offences set forth in Article 3, paragraph 1, Article 3bis, or Article 3ter; or
(b) Attempts to commit an offence set forth in Article 3, paragraph 1, Article 3bis, paragraph 1(a)(i), (ii) or (iii), or subparagraph (a) of this article; or
(c) Participates as an accomplice in an offence set forth in Article 3, Article 3bis, Article 3ter, or subparagraph (a) or (b) of this article; or
(d) Organises or directs others to commit an offence set forth in Article 3, Article 3bis, Article 3ter, or subparagraph (a) or (b) of this article; or
(e) Contributes to the commission of one or more offences set forth in Article 3, Article 3bis, Article 3ter or subparagraph (a) or (b) of this article, by a group of persons acting with a common purpose, intentionally and either:
(i) with the aim of furthering the criminal activity or criminal purpose of the group, where such activity or purpose involves the commission of an offence set forth in Article 3, 3bis or 3ter; or
(ii) in the knowledge of the intention of the group to commit an offence set forth in Article 3, 3bis or 3ter.
Protocol for the Suppression of Unlawful Acts against the Safety of Fixed Platforms located on the Continental Shelf (2005 SUA Protocol) Articles 2bis and 2ter
Article 2bis
Any person commits an offence within the meaning of this Protocol if that person unlawfully and intentionally, when the purpose of the act, by its nature or context, is to intimidate a population, or to compel a government or an international organisation to do or to abstain from doing any act:
(a) Uses against or on a fixed platform or discharges from a fixed platform any explosive, radioactive material or BCN weapon in a manner that causes or is likely to cause death or serious injury or damage; or
(b) Discharges, from a fixed platform, oil, liquefied natural
gas, or other hazardous or noxious substance, which is not covered by subparagraph (a), in such quantity or concentration that causes or is likely to cause death or serious injury or damage; or
(c) Threatens, with or without a condition, as is provided for under national law, to commit an offence set forth in subparagraph (a) or (b).
Any person also commits an offence within the meaning of this Protocol if that person:
(a) Unlawfully and intentionally injures or kills any person in connection with the commission of any of the offences set forth in Article 2, paragraph 1, or Article 2bis ; or
(b) Attempts to commit an offence set forth in Article 2, paragraph 1, Article 2bis, subparagraph (a) or (b), or subparagraph (a) of this article; or
(c) Participates as an accomplice in an offence set forth in Article 2, Article 2bis or subparagraph (a) or (b) of this article; or
(d) Organises or directs others to commit an offence set forth in Article 2, Article 2bis or subparagraph (a) or (b) of this article; or
(e) contributes to the commission of one or more offences set forth in Article 2, Article 2bis or subparagraph (a) or (b) of this article, by a group of persons acting with a common purpose, intentionally and either:
(i) with the aim of furthering the criminal activity or criminal purpose of the group, where such activity
or purpose involves the commission of an offence set forth in Article 2 or 2bis; or
(ii) in the knowledge of the intention of the group to commit an offence set forth in Article 2 or 2bis.
Beijing Convention)
1. Any person commits an offence if that person unlawfully and intentionally:
(g) Releases or discharges from an aircraft in service any BCN weapon or explosive, radioactive, or similar substances in a manner that causes or is likely to cause death, serious bodily injury or serious damage to property or the environment; or
(h) Uses against or on board an aircraft in service any BCN weapon or explosive, radioactive, or similar substances in a manner that causes or is likely to cause death, serious bodily injury or serious damage to property or the environment; or
(i) Transports, causes to be transported, or facilitates the transport of, on board an aircraft:
(1) any explosive or radioactive material, knowing that it is intended to be used to cause, or in a threat to cause,
with or without a condition, as provided for under national law, death or serious injury or damage for the purpose of intimidating a population, or compelling a government or an international organisation to do or to abstain from doing any act; or
(2) any BCN weapon, knowing it to be a BCN weapon as defined in Article 2; or
(3) any source material, special fissionable material, or equipment or material especially designed or prepared for the processing, use or production of special fissionable material, knowing that it is intended to be used in a nuclear explosive activity or in any other nuclear activity not under safeguards pursuant to a safeguards agreement with the International Atomic Energy Agency; or
(4) any equipment, materials or software or related technology that significantly contributes to the design, manufacture or delivery of a BCN weapon without lawful authorisation and with the intention that it will be used for such purpose; provided that for activities involving a State Party, including those undertaken by a person or legal entity authorised by a State Party, it shall not be an offence under subparagraphs (3) and (4) if the transport of such subparagraphs or materials is consistent with or is for a use or activity that is consistent with its rights, responsibilities and obligations under the applicable multilateral non-proliferation treaty to which it is a party including those referred to in Article 7.
3. Any person also commits an offence if that person:
(a) Makes a threat to commit any of the offences in subparagraphs (a), (b), (c), (d), (f), (g) and (h) of paragraph 1 or in paragraph 2 of this Article; or
(b) Unlawfully and intentionally causes any person to receive such a threat, under circumstances which indicate that the threat is credible.
4. Any person also commits an offence if that person:
(a) Attempts to commit any of the offences set forth in paragraph 1 or 2 of this Article; or
(b) Organises or directs others to commit an offence set forth in paragraph 1, 2, 3 or 4(a) of this Article; or
(c) Participates as an accomplice in an offence set forth in paragraph 1, 2, 3 or 4(a) of this Article; or
(d) Unlawfully and intentionally assists another person to evade investigation, prosecution or punishment, knowing that the person has committed an act that constitutes an offence set forth in paragraph 1, 2, 3, 4(a), 4(b) or 4(c) of this Article, or that the person is wanted for criminal prosecution by law enforcement authorities for such an offence or has been sentenced for such an offence.
5. Each State Party shall also establish as offences, when committed intentionally, whether or not any of the offences set forth in paragraph 1, 2 or 3 of this Article is actually committed or attempted, either or both of the following:
(a) Agreeing with one or more other persons to commit an offence set forth in paragraph 1, 2 or 3 of this
Article and, where required by national law, involving an act undertaken by one of the participants in furtherance of the agreement; or
(b) Contributing in any other way to the commission of one or more offences set forth in paragraph 1, 2 or 3 of this Article by a group of persons acting with a common purpose, and such contribution shall either:
(i) be made with the aim of furthering the general criminal activity or purpose of the group, where such activity or purpose involves the commission of an offence set forth in paragraph 1, 2 or 3 of this Article; or
(ii) be made in the knowledge of the intention of the group to commit an offence set forth in paragraph 1, 2 or 3 of this Article.
Operative paragraph 1 (b)
Operative paragraph 2 (e)
1. Decides that all States shall:
(b) Criminalise the wilful provision or collection, by any means, directly or indirectly, of funds by their nationals or in their territories with the intention that the funds should be used, or in the knowledge that they are to be used, in order to carry out terrorist acts.
(e) Ensure that any person who participates in the financing, planning, preparation or perpetration of terrorist acts or in supporting terrorist acts is brought to justice and ensure that, in addition to any other measures against them, such terrorist acts are established as serious criminal offences in domestic laws and regulations and that the punishment duly reflects the seriousness of such terrorist acts.
2. Decides also that all States, in accordance with their national procedures, shall adopt and enforce appropriate effective laws which prohibit any non-State actor to manufacture, acquisition, possession, development, transportation, transfer or use nuclear, chemical or biological weapons and their means of delivery, in particular for terrorist purposes, as well as attempts to engage in any of the foregoing activities, participate in them as an accomplice, assist or finance them.
1. Each State Party shall take such measures as may be necessary to establish its jurisdiction over the offences set forth in Article 7 in the following cases:
(a) When the offence is committed in the territory of that State or on board a ship or aircraft registered in that State;
(b) When the alleged offender is a national of that State.
2. Each State Party shall likewise take such measures as may be necessary to establish its jurisdiction over these offences in cases where the alleged offender is present in its territory and it does not extradite him/her pursuant to Article 11 to any of the States mentioned in paragraph 1.
3. This Convention does not exclude any criminal jurisdiction exercised in accordance with national law.
4. In addition to the States Parties mentioned in paragraphs 1 and 2, each State Party may, consistent with international law, establish its jurisdiction over the offences act forth in Article 7 when it is involved in international nuclear transport as the exporting or importing State.
1. Each State Party shall take such measures as may be necessary to establish its jurisdiction over the offenses set forth in Article 2 when:
(a) The offence is committed in the territory of that State; or
(b) The offence is committed on board a vessel flying the flag of that State or an aircraft which is registered under the laws of that State at the time the offence is committed; or
(c) The offence is committed by a national of that State.
2. A State Party may also establish its jurisdiction over any such offence when:
(a) The offence is committed against a national of that State; or
(b) The offence is committed against a State or government facility of that State abroad, including an embassy or other diplomatic or consular premises of that State; or
(c) The offence is committed by a stateless person who has his or her habitual residence in the territory of that State; or
(d) The offence is committed in an attempt to compel that State to do or abstain from doing any act; or
(e) The offence is committed on board an aircraft which is operated by the Government of that State.
3. Upon ratifying, accepting, approving or acceding to this Convention, each State Party shall notify the SecretaryGeneral of the United Nations of the jurisdiction it has established in accordance with paragraph 2 under its domestic law. Should any change take place, the State Party concerned shall immediately notify the SecretaryGeneral of the United Nations of the jurisdiction it has established in accordance with paragraph 2 under its domestic law. Should any change take place, the State Party concerned shall immediately notify the SecretaryGeneral.
4. Each State Party shall likewise take such measures as may be necessary to establish its jurisdiction over the offences set forth in Article 2 in cases where the alleged offender is present in its territory and it does not extradite that person to any of the States Parties which have established their jurisdiction in accordance with paragraph 1 or 2.
5. This Convention does not exclude the exercise of any criminal jurisdiction established by a State Party in accordance with its domestic law.
1. Each State Party shall take such measures as may be necessary to establish its jurisdiction over the offences set forth in Article 2 when:
(a) The offence is committed in the territory of that State; or
(b) The offence is committed on board a vessel flying the flag of that State or an aircraft which is registered under the laws of that State at the time the offence is committed; or
(c) The offence is committed by a national of that State.
2. A State Party may also establish its jurisdiction over any such offence when:
(a) The offence is committed against a national of that State; or
(b) The offence is committed against a State or government facility of that State abroad, including an embassy or other diplomatic or consular premises of that State; or
(c) The offence is committed by a stateless person who has his or her habitual residence in the territory of that State; or
(d) The offence is committed in an attempt to compel that State to do or abstain from doing any act; or
(e) The offence is committed on board an aircraft which is operated by the Government of that State.
3. Upon ratifying, accepting, approving or acceding to this Convention, each State Party shall notify the SecretaryGeneral of the United Nations of the jurisdiction it has established under its national law in accordance with paragraph 2 of the present article. Should any change take place, the State Party concerned shall immediately notify the Secretary-General.
4. Each State Party shall likewise take such measures as may be necessary to establish its jurisdiction over the offences set forth in Article 2 in cases where the alleged offender is present in its territory and it does not extradite that person to any of the States Parties which have established their jurisdiction in accordance with paragraph 1 or 2 of the present article.
5. This Convention does not exclude the exercise of any criminal jurisdiction established by a State Party in accordance with its national law.
[No changes to CPPNM jurisdiction provisions]
1. Each State Party shall take such measures as may be necessary to establish its jurisdiction over the offences set forth in Articles 3, 3bis, 3ter and 3quater when the offence is committed:
(a) against or on board a ship flying the flag of the State at the time the offence is committed; or
(b) in the territory of that State, including its territorial sea; or
(c) by a national of that State.
2. A State Party may also establish its jurisdiction over any such offence when:
(a) it is committed by a stateless person whose habitual residence is in that State; or
(b) during its commission a national of that State is seized, threatened, injured or killed; or
(c) it is committed in an attempt to compel that State to do or abstain from doing any act.
3. Any State Party which has established jurisdiction mentioned in paragraph 2 shall notify the SecretaryGeneral. If such State Party subsequently rescinds that jurisdiction, it shall notify the Secretary-General.
4. Each State Party shall take such measures as may be necessary to establish its jurisdiction over the offences set forth in Articles 3, 3bis, 3ter and 3quater in cases where the alleged offender is present in its territory and it does not extradite the alleged offender to any of the States Parties which have established their jurisdiction in accordance with paragraphs 1 and 2 of this Article.
5. This Convention does not exclude any criminal jurisdiction exercised in accordance with national law.
for the Suppression of Unlawful Acts Against the Safety of Maritime Navigation, Protocol for the Suppression of Unlawful Acts against the Safety of Fixed Platforms located on the Continental Shelf (2005 SUA Protocol)
1. Each State Party shall take such measures as may be necessary to establish its jurisdiction over the offences set forth in Articles 2, 2bis and 2ter when the offence is committed
(a) against or on board a fixed platform while it is located on the continental shelf of that State; or it is committed by a stateless person whose habitual residence is in that State; or
(b) by a national of that State.
2. A State Party may also establish its jurisdiction over any such offence when:
(a) it is committed by a stateless person whose habitual residence is in that State; or
(b) during its commission a national of that State is seized, threatened, injured or killed; or
(c) it is committed in an attempt to compel that State to do or abstain from doing any act.
3. A State Party which has established jurisdiction mentioned in paragraph 2 shall notify the Secretary-General. If such State Party subsequently rescinds that jurisdiction, it shall notify the Secretary-General.
4. Each State Party shall take such measures as may be necessary to establish its jurisdiction over the offences set forth in Articles 2, 2bis and 2ter in cases where the alleged offender is present in its territory and it does not extradite the alleged offender to any of the States Parties which have established their jurisdiction in accordance with paragraphs 1 and 2.
5. This Protocol does not exclude any criminal jurisdiction exercised in accordance with national law.
1. Each State Party shall take such measures as may be necessary to establish its jurisdiction over the offences set forth in Article 1 in the following cases:
(a) When the offence is committed in the territory of that State;
(b) When the offence is committed against or on board an aircraft registered in that State;
(c) When the aircraft on board which the offence is committed lands in its territory with the alleged offender still on board;
(d) When the offence is committed against or on board an aircraft leased without crew to a lessee whose principal place of business or, if the lessee has no such place of business, whose permanent residence is in that State;
(e) When the offence is committed by a national of that State.
2. Each State Party may also establish its jurisdiction over any such offence in the following cases:
(a) When the offence is committed against a national of that State;
(b) When the offence is committed by a stateless person whose habitual residence is in the territory of that State.
3. Each State Party shall likewise take such measures as may be necessary to establish its jurisdiction over the offences set forth in Article 1, in the case where the alleged offender is present in its territory and it does not extradite that person pursuant to Article 12 to any of the States Parties that have established their jurisdiction in accordance with the applicable paragraphs of this Article with regard to those offences.
4. This Convention does not exclude any criminal jurisdiction exercised in accordance with national law.
Operative paragraph 2 (e)
2. Decides also that all States shall:
(e) Ensure that any person who participates in the financing, planning, preparation or perpetration of terrorist acts or in supporting terrorist acts is brought to justice and ensure that, in addition to any other measures against them, such terrorist acts are established as serious criminal offences in domestic laws and regulations and that the punishment duly reflects the seriousness of such terrorist acts.
Operative paragraph 2
2. Decides also that all States, in accordance with their national procedures, shall adopt and enforce appropriate effective laws which prohibit any non-State actor to manufacturing, acquiring, possessing, developing, transporting, transferring or using nuclear, chemical or biological weapons and their means of delivery, in particular for terrorist purposes. This includes attempts to engage in any of the foregoing activities, participation as an accomplice, assistance, or financing.
1. More detailed information on the international legal instruments addressed in this Chapter can be found in UNODC’s Module on The International Legal Framework against CBRN Terrorism (2023) at https://www.unodc.org/documents/terrorism/for%20web%20stories/1-WS%20CBRN%206%20modules/CBRN_module_-_E.pdf
2. ICSANT: (https://unodc.org/icsant)
3. Zangger Committee (https://zanggercommittee.org/)
4. Nuclear Suppliers Group (https://www.nuclearsuppliersgroup.org/ en/)
5. The Wassenaar Arrangement (https://www.wassenaar.org)
6. S/RES/1373 (2001) on ‘Threats to International Peace and Security Caused by Terrorist Acts’.
7. S/RES/1540 (2004) on ‘Non-proliferation of Weapons of Mass Destruction’.

CHAPTER EIGHT

Legislation Framework and Variance
References 8.1 8.2 8.3 8.4
Coordination and Collaboration with Other Stakeholders (National and International)
Categories of Radiological and Nuclear Crimes
Case Examples
As part of the criminal justice and overall national security systems, the prosecutor plays an essential role in combating crime while ensuring adherence to legal procedures, imposing penalties on offenders, protecting vulnerable persons, upholding the rights of all parties and re-establishing the rule of law. While in some countries prosecutors enjoy increased autonomy and even possess judicial authority, in others, they operate under the authority of the Ministry of Justice or equivalent executive bodies. Consequently, prosecutors, beyond their direct role in combating crime, serve as the proactive arm of criminal justice and state authority in many legal systems. They also bear a general duty to ensure the legal protection of society and its rights. Moreover, successful prosecutions can have a preventative effect in discouraging criminal activities and building public confidence in and support for the criminal justice system. Prosecutors are responsible for the decision to prosecute, and their impact on the interpretation and application of the law is profoundly significant.
National legal systems around the globe predominantly fall into two categories: common law or civil law, with some jurisdictions combining elements of both. In certain countries, Islamic law (Sharia, traditional Islamic law and structures) or customary law are applicable. The civil law system (Roman system) is present in the majority of nations, including the EU Member States, the Russian Federation and South America (excluding Guyana). On the other hand, the common law system is represented in the United Kingdom, the British Commonwealth and the United States.
Some nations in Asia and Africa combine the two legal systems or incorporate Islamic law.
For the purpose of this guide, efforts have been directed towards gaining insights into a variety of criminal justice systems in the world to offer a more comprehensive understanding of the applicable legal frameworks. However, the analysis is limited by access to pertinent literature, the availability of an in-depth knowledge of legal peculiarities and mostly, space in the text. Priority has been given to sources concerning countries with more developed nuclear facilities or radiological installations, along with published case studies.
Although civil and common law systems share some fundamental principles, they have developed independently, each possessing distinct substantive and procedural norms. Despite mutual historical influences, the two systems have developed unique characteristics. Examples of factors driving convergence include globalisation, tools for international collaboration supported by international organisations, contemporary European integration and the free flow of people and goods. Nevertheless, there are several divergent elements, such as historical customs, unique political and economic circumstances, the Western emphasis on decentralisation and cultural distinctions. Common law operates on an adversarial model, where the prosecution and the defence challenge each other before the court. On the other hand, civil law follows an inquisitorial approach, with the prosecution leading the penal process.
In civil law systems, a codified body of laws specifies the crimes subject to legal punishment (substantive penal law), procedures for participants in the criminal justice system, their rights, obligations, and enforcement mechanisms, as well as their respective
roles and responsibilities (procedural law) and what the nature and severity of the penalties are. Judicial actors are responsible for establishing facts, identifying accessible and relevant evidence and determining applicable legal rules during prosecution and trial. The judge is compelled to review the evidence as part of the inquisitorial aspect of the criminal proceedings.
In contrast, while common law systems rely on written laws, case law also plays a significant role. Common law systems use an adversarial method in adjudication, with the judge serving as the trier of pertinent law, deciding legal issues as they arise, moderating hearings and other proceedings and determining penalties. Juries, composed of untrained citizens, serve as triers of fact, deciding guilt or innocence.
Both systems use a pre-trial framework to outline the issues at hand. Still, in civil law systems, an investigation is typically overseen or directed by the judicial authorities (prosecutors or investigating judges) with the aim of revealing relevant aspects and ensuring a legality check when administering evidence. Evidence is presented both in support of and against the accused. This is different from the common law system, where the defendant bears the primarily responsibility to provide exculpatory evidence, both parties engage in cross-examining evidence, thus providing greater latitude for interpretation. That said, common law prosecutors are obligated to disclose exculpatory evidence. Both systems adhere to written rules of evidence and methods of proof, such as admissibility and relevance.
The accepted practice in civil law systems is the free assessment of evidence. In such systems, the burden of proof rests with the prosecution. Although once considered a common law principle, the right to remain silent has now extended to civil law systems
and is deemed by the European Court of Human Rights an international standard underlying a fair trial. Due to the right to remain silent and the burden of proof, the prosecution must often produce additional forms of evidence that must be legal, pertinent and compelling to prove the defendant’s guilt and achieve a conviction.
In civil law systems, the prosecutor typically decides whether to prosecute a criminal matter. Unlike common law jurisdictions, some European legal systems, such as those in France or Romania, have judges and prosecutors who are both magistrates and members of the judiciary. However, in France, prosecutors are institutionally subordinated to the Minister of Justice, who is part of the executive branch of government. The two professional groups undergo the same training, take the same professional exams and have careers that are interchangeable in many European legal systems.
Within common law systems, the prosecution’s duty varies significantly and can occasionally be exercised by specific agencies or even by an interested party. For instance, in England and Wales, the Crown Prosecution Service (CPS), although independent of both the executive branch and the judiciary, has no authority to lead investigations or participate in witness hearings. The police have the power to charge someone for committing an offence, and the CPS becomes involved only after the police investigation is completed and a decision on prosecution is made. In India and Pakistan, prosecutors are officers appointed by the state or provincial government, respectively, and have limited authority in criminal proceedings. In common law or mixed systems, the prosecutor, after assessing the evidence and determining that the case falls within the scope of the law, has much more discretion in deciding whether to initiate criminal proceedings. This approach
favours the opportunity principle over the legality principle, which applies in many civil law systems.
In States with federal political structures, legal systems may be bifurcated. In the United States, the prosecuting authority is generally split between national (federal) and local (provincial [read: ‘state’ in the US nomenclature]) offices and significant criminal events with nationwide impact are often pursued by federal authorities. State governments have general jurisdiction in all 50 American states, and the prosecutor’s office is traditionally connected to the local community (which elects the head of the office in some states). Law enforcement agencies fall under the executive branch of government, with investigative powers not subject to the authority of the prosecutor’s office. The police decide when to refer an investigation to the prosecutor’s office for prosecution or legal advice.
Depending on the gravity of the offence, common law procedures frequently allow for variations in the procedural legal framework. In certain legal systems, even the court’s composition varies, such as in the UK, where professional judges and magistrates (laypeople) coexist. In the United States, a person may be taken before courts of varying jurisdictions based on the charges presented by the prosecutor. The grand jury plays an important role at this stage of the judicial process, when formal criminal charges are formulated. Bail is frequently granted pending trial, and plea negotiation between the prosecutor and defence lawyer usually lead to agreements that obviate the need for a formal trial. In civil law countries, the court can consist of either judges only or both judges and lay assessors. Even in expedited proceedings where the defendant accepts guilt, the court must nevertheless evaluate evidence to ground its decision.
Investigations and prosecutions of criminal cases concerning RN materials may raise specific challenges, starting with understanding the characteristics and dangerous nature of the material evidence and the need to prevent contamination and confine the potential effects on people and the environment. Furthermore, regulatory restrictions regarding activities, information and personnel involved in operations with such substances and installations apply. These restrictions may result in delays or impediments to obtaining swift and full access to information and evidence. Other essential factors to be considered are the availability of special equipment and technical capabilities to examine the crime scene and analyse the evidence. Therefore, specialised knowledge and expert competencies are required for successful inquiries and evidence retrieval.
In large-scale and complex investigations in particular, prosecutors are required to coordinate activities with various national (and sometimes international) authorities and bodies, including police, specialised first responders, intelligence agencies, regulatory bodies, forensic experts and medical personnel. They must lead large interdisciplinary teams, organise activities efficiently and expeditiously, manage relations with a multitude of organisations amid public scrutiny, understand and communicate technical information and data, issue requests for specific expert evidence, assess evidentiary needs and order the collection
of evidence, manage numerous intricated case files and write complex indictments. It is obvious that such competencies must be cultivated beforehand and reinforced through training to ensure preparedness. Consequently, in some legal systems, specialised prosecutors and branches of the prosecutor’s office have been established to lead investigations and carry out the prosecution of particularly serious offences, including those related to RN materials, terrorism, organised crime, etc.
Coordination with the police and other investigative bodies should be considered as standard practice because, similar to other offences, criminal investigations regarding nuclear and other radioactive materials are typically initiated by the police following complaints, alerts of ongoing incidents or notifications from specialised first responders. Depending on the peculiarities of the national legal system, prosecutors may be called to oversee the police investigation in complex cases or serious offences, provide legal counsel when necessary and direct the investigation and prosecution of grave crimes and cases with international ramifications in specific legal systems.
In many countries, the prosecutor also has the authority to initiate public legal action whenever suspicions of a crime exist and can contact other national authorities and agencies to solicit their active involvement, assistance or support during criminal investigations. Especially in civil law systems, the prosecutor often leads the multidisciplinary investigative teams; this is particularly true in cases concerning RN materials. Such proceedings, by nature, require expert involvement and sometimes large teams, where role management, effective communication and coordination are paramount for achieving successful investigations and prosecutions.
Throughout the investigation and prosecution phases, one of the prosecutor’s key roles is that of gatekeeper, which guarantees compliance with the principles of a fair criminal process. Prosecutors monitor the legality of the proceedings and correct irregularities to ensure the equity and swiftness of the procedures. Moreover, in their primary role as prosecution leaders, particularly in civil law systems, they can order or confirm urgent investigative and freedom-restricting measures, assess evidence when sending the case to trial and seek final legal resolution in criminal matters throughout the judicial proceedings and trial stages. In some legal systems, prosecutors are responsible for authorising temporary interception of communications, surveillance, undercover investigations, controlled deliveries, confiscation of assets, house and computer searches, collection of DNA samples and freedom-restraining measures in urgent situations or for serious crimes. Simultaneously, they are expected to balance the interests of the prosecution and the rights and freedoms of individuals, such as the victim and the offender’s rights in criminal proceedings, while protecting privacy and personal data.
Prosecution of terrorist activities or crimes against national security, especially in cases related to RN materials, may impose higher levels of confidentiality or even handling of classified information and may involve exchanges with intelligence agencies. Often, information concerning RN substances is sensitive and is transferred via dedicated channels. Though not always conducive to evidence, intelligence and information provided by various agencies with responsibilities for national security, countering crimes or regulatory bodies can prove highly valuable. Thus, trust, networking and common operational agreements between organisations should be established as preparedness strategies.
The role of RN experts in the prosecution of these offences cannot be understated, and collaboration with them is the cornerstone of effective prosecution. In civil law systems, it is usually the judicial authorities that decide on the prosecution or even investigation of a case, the legal qualification that determines the competence ratione materiae and ratione loci (by reason of the subject matter and location), as well as the use of special investigative techniques and measures that restrict freedom or the exchange of information and cooperation with foreign authorities to secure evidence. Nevertheless, there are instances where international programmes aimed at building capabilities to combating crimes concerning RN materials tend to neglect the training of prosecutors, as they primarily focus on first responders and regulatory authorities. As a result, this occasionally leads to a lack of awareness among prosecutors, investigative judges and judicial police about nuclear and radiological security issues, nuclear forensic capabilities, ineffective handling of situations involving RN materials, lengthy investigative delays, inadequate exchanges of relevant information and even failure to open criminal cases when appropriate or conducting investigations properly.
Nuclear forensics plays an important role in criminal investigations related to illicit acts involving RN materials. It employs methods and techniques that reveal the origin and history of the materials, indicating possible transit routes and purposes, and facilitating investigative leads and links between persons, materials and locations. Nuclear forensics is an invaluable resource for identifying radioactive material out of regulatory control, which can indicate a violation of law and/or security (including the physical protection of facilities housing such materials). Nuclear forensics can also assist in determining the legal implications of the deeds. This determination is contingent upon the legal provisions of
each nation, where a distinction must be made regarding the seriousness of the offence based on the materials involved or their prospective use. At the same time, by establishing the provenience of the material, nuclear forensics can provide an early indication of national or foreign ties, assisting the criminal investigation in directing attention toward potential sources of evidence or evaluating the need for cooperation. Regulatory bodies or other national stakeholders with information about RN materials may provide informational support to the criminal investigation, as well as subject matter expertise, to allow forensics experts to draw relevant conclusions from laboratory findings.
Experts are relied upon when it is necessary to establish, clarify or assess facts or conditions critical to determining the truth during prosecution or trial. In cases where specialised expertise is required to interpret evidence, prosecutors or judges can request expert assistance from forensic specialists. These experts must be objective and well-qualified. In civil law systems such as in Austria, Germany, Japan, China, Romania and others, science experts are normally selected by court authorities from a list of certified professionals, although they can also be employed as party experts. The Ministry of Justice maintains a list of certified judicial experts. When no qualified experts are accessible, approved specialists from a court-maintained list or other known available experts can be called upon. Furthermore, forensics specialists can be certified or recognised by an institutions, such as the Ministry of Justice, following a prescribed process to ensure their impartiality, lack of bias and professional qualifications.
Experts often submit written reports, but they may also be called into court as oral witnesses if the judicial authority deems it necessary (e.g., China, India). In Argentina, for example, as per the rules of criminal procedure, experts present their conclusions orally
during the trial. They support their statements with documents and employ any other necessary means to explain the steps, methods and activities undertaken to arrive at their conclusions.
The importance of communication between prosecutors and experts must be emphasised. On the one hand, prosecutors must be informed, to the greatest extent possible, about the relevant aspects of the RN materials that are the object of the case. This allows them to ask pertinent questions, request answers to relevant questions to the criminal investigation and prosecution, solicit expert reports, interpret findings and ensure clear and knowledgeable exchanges with experts. On the other hand, experts must be informed of the constraints of criminal proceedings and provide comprehensible conclusions that all interested parties and the court can understand.
Experts may be granted some leeway in expressing their opinions, as it can be difficult for representatives of justice to fully assess the accuracy of the expert’s findings, methods and conclusions, particularly in specialised fields such as nuclear forensics. However, in cases where the report is questioned, deemed incomplete, faces challenges from an interested party, or exhibits contradictions between findings and conclusions, it is advisable for the prosecutor or judge to request a supplementary report and even a new expert opinion.
In common law countries, experts are recognised and certified by the trial court judge during individual proceedings. After an expert has been examined regarding credentials and qualifications, the expert will be expected to justify the science behind the expert conclusions placed before the court for admission into the trial record. The methodology is often found in case law. In the US case Daubert v. Merrell Dow Pharmaceuticals, Inc., 509 U.S. 579 (1993),
the nationally recognised criteria for verifying scientific testimony at trial has been laid out: when the expertise being relied upon has been examined, subjected to peer review, its known error rate documented, and wide acceptance in the scientific community can be demonstrated, can the recognised expert use it as a basis for testimony. The US Federal Rules of Evidence compel judges to evaluate not just the relevance of the experts, but also their reliability, in this manner. In the UK, expert evidence must meet three criteria: relevance, dependability and impartiality.
The prosecutor’s role also extends to establishing contacts via formal or informal channels to secure international cooperation whenever necessary. In most cases, a MLA request, grounded in international conventions or bilateral agreements, must be issued by and addressed through the central authorities of the requesting and requested state. Certain frameworks for legal assistance in criminal matters, like mutual recognition instruments in the EU, provide swift and effective solutions for evidence collection, surrendering of offenders and multiparty investigative coordination facilitated by EUROJUST and EUROPOL. Furthermore, JITs can be established between the interested parties based on an agreement signed by the representatives of the judicial authorities leading the prosecution.
Various prosecutor networks worldwide generally facilitate international cooperation in criminal matters or offer legal assistance for the prosecution of specific crimes. Examples include the International Association of Prosecutors (IAP), the European Judicial Network (EJN), the Ibero-American Network of Judicial Cooperation (IberRed), the Judicial Cooperation Network for Central Asia and Southern Caucasus (CASC), the South East Asia Justice Network (SEAJust) and the West African Network of Central Authorities and Prosecutors (WACAP).
International legal assistance can be obtained for prosecution or extradition based on legal instruments developed by the United Nations (ICSANT, UNTOC and other counter-terrorism conventions), the IAEA (CPPNM) and the EU (Directive 2017/541 on combating terrorism).
Several international legal instruments developed under the UN auspices criminalise illicit activities related to radioactive and nuclear materials, ranging from theft to terrorism. Chapter 1 of this guide discusses the categories of crimes involving RN materials. Given the expectation for UN Member States to transpose the provisions of ratified conventions and treaties into their legislation, it is generally understood that national frameworks sanctioning unlawful activities with RN materials converge. Nevertheless, some variance might exist, and this is elaborated upon in Chapter 7.
The Convention on the Physical Protection of Nuclear Material focuses on safeguarding nuclear materials used for peaceful purposes during international transport. It mandates the criminalisation of certain offences involving nuclear material and encourages international cooperation, for example, in the case of theft, robbery or any other unlawful taking of nuclear material or credible threat thereof. States pledge to cooperate, coordinate, exchange information and provide each other assistance to the maximum feasible extent in resolving such incidents.
The International Convention for the Suppression of Acts of Nuclear Terrorism codifies the criminalisation of the intentional and unlawful possession of radioactive material with the intent to cause death or serious bodily injury, or substantial damage to property or the environment; the use or threat of use of radioactive material or device, or damage to nuclear facilities, with the intent to cause death or serious bodily injury, or substantial damage to property or the environment, or to compel a natural or legal person, an international organisation or state to do or refrain from doing an act. States must also criminalise threats to commit any of the listed offences, as well as unlawful demands of radioactive material, devices or nuclear facilities by threat or use of force. An attempt or contribution in any form, including as a group, to the commission of such offences should be punished.
Other terrorist offences as foreseen by EU Directive 2017/541 on combating terrorism could include activities such as the manufacture, possession, acquisition, transport, supply or use of explosives or weapons, including chemical, biological, radiological or nuclear weapons, as well as research into, and development of, chemical, biological, radiological or nuclear weapons.
In addition to the types of crimes discussed above, other offences that may occur more frequently in practice include non-compliance with the legal regime of radioactive and nuclear materials, infringements in waste management, environmental crimes, breaches of laws and regulations concerning professional conduct, work safety and security, etc.
Case Title:
Presented here from a prosecutorial perspective, and previously in Chapter 5 from a technical perspective.
Date of Investigation: July 2018 –January 2019
Level: National/Federal
Country of Origin: Romania Region/State: Bucharest
Case Category: RADIOLOGICAL
Incident Summary:
• In July 2018, in two separate incidents, two individuals were identified at Bucharest Otopeni Airport in possession of several decks of cards that triggered the alarm of the radiation detection portal.
• The radioactive isotope (125I) was identified on all the cards.
• The carriers of the packages stated that they received the cards from colleagues in Vietnam and intended to hand over the cards to another Vietnamese colleague working in Romania.
• The police did not open an investigation, treating the incidents as misdemeanours; therefore, the prosecutor’s office was not informed at the time.
• A few days later, the prosecutor learned of the incidents during an unrelated meeting at the headquarters of the national regulatory body for nuclear activities.
• Drawing on preliminary information and consultations with national experts and leveraging insights gained from previous awareness of similar cases through exchanges with foreign experts, the prosecutor requested a police incident report.
• Subsequently, the specialised prosecutor’s office opened a case file on suspicions of an organised crime group illegally bringing playing cards treated with 125I into Romania with the purpose of defrauding co-nationals wagering on the outcome of the game Xóc Đĩa for which cut-outs from the cards were used. The criminals would then wire the illicit gains back to their country of origin.
• Under Romanian law, the prosecutor leads the criminal investigation and prosecution of serious offences, such as non-compliance with the legal regime on nuclear and radioactive materials, particularly when organised crime groups are involved.
• The investigation aimed to prove membership in the organised crime group and uncover the unlawful activities that were committed, resulting in illicit profits.
• All main cards (covered in aluminium foil) contained radioactive iodine shielded on one side with lead or silver. The activity per sample ranged from 9.15 MBq to 19.2 MBq.
• In the second incident, a small blue device, later identified as a custom-made Geiger-Müller counter, apparently for detecting the iodine isotopes, was discovered. This was covertly used during the Xóc Đĩa game to determine the number of tokens retrieved face-up after shaking the bowl, thereby influencing betting decisions.
• Though the cards, the iodine solution and the iodine detector were available for purchase on Vietnamese sites, it became apparent they were industrially produced in a third country, likely by individuals or companies with access to a medical source of 125I.
• The prosecution focused on finding proof of the existence of the organised crime group, its structure, the offenders’ roles, the group’s duration and criminal scope and the identification and confiscation of unlawful financial assets.
• The two leaders of the criminal activities were fully aware of the nature of the materials used in the playing cards. Following the confiscation of the packages, they had made plans to bring another set of radioactive playing cards into Romania.
• The two leaders were lending money to interested players at interest rates of 50 percent and keeping debtors’ bank cards and mobile phones as guarantees. It was established that illicit gains ranging from a few thousand to tens of thousands of euros had been made.
• At the same time, the prosecution aimed at disrupting criminal activity and preventing further attempts by the group members to introduce hazardous materials into Romania.
• Dosimetry, contamination and radiological risk assessment were initially conducted at the detection site.
• Nuclear forensics methods were employed during the criminal investigation (high-resolution gamma spectrometry and X-ray radiography).
• Although the criminal activity was halted, the radioactive materials were secured and additional evidence was confiscated, the perpetrators were not brought to trial.
• They were deported and left the country for their own safety after becoming the target of their enraged victims who, by chance, discovered they had been deceived.
1. Merryman J.H. On the Convergence (and Divergence) of the Civil Law and the Common Law. Stanford Journal of International Law, 17(2), (1981), 357–388.
2. Berkeley University. The common law and civil law traditions. The Robbins Collection, Berkley (2010). Available at https://www.law.berkeley. edu/research/the-robbins-collection/exhibitions/common-law-civil-law-traditions
3. Jackson, J.D., & Summers, S.J. The Internationalisation of Criminal Evidence. Cambridge University Press (2012).
4. Verrest P. The French Public Prosecution Service. European Journal of Crime, Criminal Law and Criminal Justice, 8(3), (2000), 210–244.
5. Ashworth A. Developments in the Public Prosecutor’s Office in England and Wales, European Journal of Crime, Criminal Law and Criminal Justice, 8(3), Kluwer Law International (2000), 257–282.
6. Johnson, D.T., Fukurai, H., & Hirayama, M. Reflections on the TEPCO Trial: Prosecution and Acquittal after Japan’s Nuclear Meltdown. The Asia-Pacific Journal, 18(2), (2020), 5336.
7. Walther S. The Position and Structure of the Prosecutor’s Office in the United States, European Journal of Crime, Criminal Law and Criminal Justice, 8(3), (2000), 283–295.
8. Andrew W. Jurs. Balancing Legal Process with Scientific Expertise: Expert Witness Methodology in Five Nations and Suggestions for Reform of Post-Daubert U.S. Reliability Determinations, Marquette Law Review 95(4), (2012), 1329.
9. Edmond G. Is Reliability Sufficient – The Law Commission and Expert Evidence in International and Interdisciplinary Perspective (Part 1), International Journal of Evidence and Proof, 16(1), (2012), 30–65.


CHAPTER NINE

Public Communication and Media Management
Preparation of the RN Case for Trial
Drafting the Charging Documents
General Roles of Expert Witnesses and Forensic Reports
Trial Presentation of an RN Expert
Qualifying the Expert to Testify Roles of the Expert at Trial
Trial Preparation of the Expert Cross-Examination of the Expert
Sentencing and Appeals
Case Example
The public’s general right to be informed about significant events affecting personal safety, coupled with the government’s specific role in addressing an RN event, may require prosecutors to balance a variety of factors. During the trial stage of prosecution, a media management plan must consistently answer three basic questions regarding public communication:
1. WHEN should information be shared with the public?
2. WHAT information should be shared?
3. WHO should be releasing the information?
As previously noted, illicit activity involving RN material may trigger a response effort from an array of different agencies – both national and local – with separate legal authorities and roles. During an ongoing investigation, the media’s publication of sensitive information may create risks, including the potential destruction of evidence, perpetrators fleeing the jurisdiction or compromising confidential sources. To avoid inadvertent disclosure of sensitive information, the lead investigative agency should ensure the development of a coordination plan for responding to media inquiries among these agencies. After formal charges have been initiated, media coordination will often shift, at least in part, to the public affairs office of the prosecuting authority. As a result, prosecutors must collaborate closely with their public affairs
officials to anticipate potential media issues during and after the trial. When formulating a media plan, the approach should, at a minimum, answer the following questions:
• Will there be a designated lead or a single spokesperson who coordinates with the public affairs officials in other agencies to provide a primary source of information to the media?
• Should the lead spokesperson possess both technical and law enforcement expertise to adequately address inquiries from the press?
• How will media spokespersons coordinate with victim counsellors to ensure that victims are not unfairly impacted or surprised by news stories?
Prosecutors should also be aware that apart from the law enforcement team, other groups may perceive affected interests that prompt them to publicly comment about the case. For example, local politicians, the original owners of stolen radiological material and consequence management responders may each seek to address the public concerning the nature of the threat (for instance, terrorist vs. accidental) and the health risks to the general public from their respective vantage points. Awareness of these potentially competing interests, along with early coordination and established lines of communication, can prevent adverse effects upon the prosecution due to unnecessary or conflicting public messaging.
After litigation has begun, prosecutors must be mindful of the risks posed by the release of sensitive information during discovery or
subsequently at trial. Although not every media question can be anticipated, several common lines of questioning may be expected:
• What is the specific form of radiation involved in the release/theft/transfer, etc.?
• If an evacuation of a certain geographical area has occurred or is being contemplated, when may the residents safely return? Which governmental agency is responsible for providing transportation, emergency provisions and temporary housing?
• Are there other perpetrators at large or other dangerous materials not yet recovered?
• What was the original source of the radiological material? Is a nation-state or a terrorist group involved in its acquisition/deployment? Were there failures in physical protection or regulation that allowed for the material to be illicitly obtained?
Throughout the trial and appeal stages of a case, the protection of sensitive sources and methods remains a paramount responsibility. Additionally, the improper disclosure of sensitive information may create the risk that future perpetrators will attempt to replicate the modus operandi of the wrongdoing by learning regulatory vulnerabilities, critical protective measures, possible means of weaponisation, etc. These risks can be significantly mitigated by obtaining judicial orders restricting the disclosure of sensitive information during trial and continuing through any appellate review. To adequately explain these risks to a judicial officer, prosecutors will likely need to obtain affidavits or decla-
rations from law enforcement or technical experts. (Of course, these affidavits describing the sensitive information must be filed with the court under seal and in camera.)
As a general matter, prosecutors must avoid discussing with the press a case that is currently in trial. Courts may look unfavourably on any press releases or interviews during trial because of the risk that resulting media publications could unfairly influence witnesses or jurors. Prosecutors perceived as using media messages for their advantage may encounter scepticism from courts when making subsequent requests to limit the disclosure of sensitive information. In short, the public’s right to be informed must be balanced against the protection of sensitive law enforcement information throughout the various stages of a criminal case.
When an investigation enters the charging and litigation phases, prosecutors may encounter various challenges. A primary issue concerns the form of the charging document. While the legal requirements will vary across jurisdictions, prosecutors will likely face a common drafting question: How much information about the technology or criminal scheme should (or must by law) be included in the charging instrument? Generally speaking, there are two options: (1) a concise ‘notice’ pleading that seeks to set forth
all the criminal offences while providing as little background or evidential information as is necessary, and (2) a longer ‘speaking’ document that provides a somewhat detailed explanation of the illicit activity that resulted in the alleged criminal offences. If the precise description of an RN source would create risks such as those described above in the media section, prosecutors should consider using a suitable replacement term or phrase that is less descriptive. Prior to the public filing of charges, an expert may confirm that any substitute term is accurate yet does not disclose unduly sensitive or proprietary information.
Of course, the charging document should be sufficiently precise so that the accused parties fully understand the nature of the offences brought against them, so that they can fairly prepare their defence. Frequently, disclosure of the underlying evidence supporting the charges will accompany the charging document. A decree of charges may require the inclusion of conclusions from the RN expert. Accordingly, the prosecutor must be fully versed in the technical issues related to the underlying evidence – and be prepared to obtain any judicially authorised protective orders – before providing the same to the defence.
Technical experts may serve several functions during an investigation and throughout the course of a trial and an appeal. Prosecutors and investigators may utilise an expert to serve as a consultant to assist in understanding the science or technology at issue. As explained in earlier chapters, an initial understanding is crucial to ensuring a thorough investigation and an accurate evaluation that the evidence obtained will support the alleged criminal offences.
Especially when the offence involves dual-use or emerging technologies (such as in some export control violations), early expert assistance may be critical in understanding whether a crime has, in fact, occurred. The expert may also provide guidance important to maintaining an appropriate chain of custody, as discussed in Chapter 5. When requesting pretrial detention or other restrictions on a defendant, prosecutors may need the expert’s input to adequately explain the risk to public safety implicated by the radioactive material at issue. This consultant role often continues throughout the trial and appellate stages. In some systems, judges may appoint an expert to advise them concerning the technical aspects of the case.
Often, such an expert is employed by the investigating agency. The expert may also rely on additional knowledge or input from colleagues working in the relevant field, either with the military, a national laboratory or even the private sector. Before the anticipated trial, the expert solicits such assistance; however, the expert should coordinate with the prosecutor. Information to be shared outside the prosecution team may be restricted either by classification level or by court order. In preparing for trial, an expert may need to conduct a site visit or confer with other scientists or technicians who have operated or used the device or material under scrutiny in the present case. Subject to an appropriate background investigation and nondisclosure agreement, outside experts can be retained during the pretrial stage to better prepare for trial. Although traditional forensics laboratories are typically administered and accredited by law enforcement agencies, a specialised military or national laboratory may be the repository for radiation-contaminated evidence. During their trial testimony, experts must be familiar with the procedures for transporting and storing evidence.
Apart from consulting, an expert may also be employed as a forensic examiner of the evidence in anticipation of testifying at trial. Nuclear forensic examiners may complement other forensic examiners (fingerprints, DNA, etc.) who focus on different aspects of the evidential material. As described previously, the forensics expert’s examination report generally includes details such as what evidence was tested (the scope of the work), the methods of analysis utilised and the conclusions formed as a result.
Depending on the factual scenario, a trial that concerns a radioactive substance may present many complex legal and advocacy challenges. For instance, during the various stages of a trial –opening and closing statements, examinations of witnesses and submission of exhibits – the prosecutor must remain mindful of the continued need to protect any sensitive information from public disclosure (e.g., intelligence sources and methods, identities of informants and technical capabilities of weapons). Among the various components of such a trial, the area that will most likely present the greatest challenge is the presentation of the RN expert. Accordingly, the rest of the chapter will focus mostly on the trial presentation of such an expert.
Experts purporting to have subject matter expertise related to RN materials generally must satisfy legal standards for their qualifications and for the reliability and bases of their proffered opinions before they are permitted to offer opinion testimony to a finder of fact. In some legal systems, the court and the parties to the litigation utilise an existing roster of qualified expert examiners. The roster comprises qualified experts who regularly provide courtroom testimony and have been nominated by either prosecuting or defence offices. In other situations, the prosecution and the defence separately propose the use of their respective experts for the specific demands of the case at hand. The legal threshold for qualification may vary across jurisdictions, but certain recurring factors arise regarding experts: their educational background and areas of research, any testing or analysis of the evidence performed by them and their previous acceptances by courts to provide similar opinions. Prosecutors should not assume that just because an expert has testified previously, the expert will be automatically accepted to opine about the specific issues in the current case.
When a prosecutor seeks to introduce expert testimony, the validity of the particular scientific theory or tests supporting those opinions may be challenged. In some systems, such as in the United States, a trial judge will act as a ‘gatekeeper’, deciding which expert opinions are sufficiently reliable for the ultimate finder of fact (e.g., a jury of citizens from the community) to consider as evidence. Accordingly, non-scientifically trained judges are frequently required to initially evaluate whether a proffered expert opinion rests on sound scientific methodology. The realm of the finder of fact often involves determining whether the facts or data
in a particular case are properly interpreted given the underlying scientific principles. Unlike more commonly known forensic fields (DNA, fingerprints and computer analysis), the field of nuclear forensics does not have a well-established history in court proceedings or decisional law. A pretrial hearing that examines the expert’s report may result in the modification or limitation of the scope of opinions the expert is allowed to provide or a determination of a need for additional expert assistance.
In adversarial systems, prosecutors, prior to trial, are typically required to summarise an expert’s opinions and the bases thereof when providing notice to the defence of the intended expert testimony. This notice from the prosecution is in addition to any final report written by the expert. Prosecutors should remind their experts to inform them immediately if their opinions or the bases thereof have changed since the notice, or the report was initially filed. Experts may reconsider the grounds for previous opinions or come to rely upon additional data or studies, and the defence should be apprised of these developments to avoid surprises at trial. The failure to sufficiently disclose the scope of an expert’s opinions and bases thereof during pretrial proceedings may result in restrictions on the expert’s testimony at trial. In both common law and civil law systems, the court may appoint an expert witness and set forth the expert’s duties. In such instances, the parties may seek to interview or depose the expert prior to trial.
From the outset of a trial, the prosecutor must be mindful that the subject matter of the case will include information unfamiliar to finders of fact who are most likely scientifically untrained. The expert portion of a trial presentation will require a prosecutor to
initially determine whether more than one expert is needed and what role each expert should fill. In a general sense, experts may assist the judge or jury in understanding evidence (e.g., what is caesium-137?) and/or to determine a disputed fact (e.g., was the caesium-137 from the dirty bomb stolen by the defendant?). Clarifying the role(s) that the expert will serve and confirming that those roles are legally permissible is a critical obligation for the prosecutor during trial preparation.
Unlike many other expert witnesses (such as firearms or fingerprints experts), RN experts will need to explain topics unfamiliar to the average person. To aid the finder of facts in understanding the evidence, prosecutors should anticipate the need for an expert to provide a basic introduction to the science of radiation. For example, concerning the radioactive substance at issue, an expert may be requested to explain the sources (both natural and non-natural), the different types, legitimate uses, radioactive decay and the meaning of the term ‘half-life’ as it pertains to the deterioration of radioactive isotopes. Additionally, the expert may explain how detection equipment functions to identify the presence of radiation. A person trained in nuclear physics or nuclear engineering may be suitable for such a role, assuming that person can explain the subject matter in terms a lay person will readily understand. The use of demonstrative diagrams or charts is often very helpful in this ‘educating section’ of the expert testimony.
Aside from imparting a rudimentary understanding of radiation (‘Radiation 101’), an expert may play a crucial role in explaining the effects of radiation exposure, e.g., lethal dosages, the impact of exposure variables (time, distance and shielding) and how a human body responds at a cellular level. If the nuclear scientist is unable to fulfil this role, a person trained in health physics,
nuclear medicine or toxicology may be suitable for this portion of the case presentation.
Experts can misconstrue their roles if they perceive themselves as advocates or partisans to one side in the litigation. They can also undermine the credibility of their opinions when they exaggerate or overstate the reliability of their findings. For instance, claiming that their conclusions satisfy ‘a reasonable degree of scientific certainty’; asserting that the operative testing procedure has ‘no error rate’; or insisting that an attribution is incontestable because ‘the bullet could only have come from one gun in the world’. As with all forensic witnesses, nuclear forensics experts must also be careful not to exaggerate their attribution testimony beyond what the underlying science supports or offer opinions beyond their area of specialisation.
During the investigative stage, the lead law enforcement agency may have been assisted in its efforts by other non-law enforcement agencies that possessed the requisite technical support. Personnel from these non-law enforcement agencies, whose official duties generally focus on non-criminal activities (e.g., public health monitoring and military preparedness), may have never participated previously in a criminal prosecution. From the outset of the case, prosecutors should explain to technical experts, who have had no prior courtroom experience, how a criminal case proceeds. These experts should be apprised that, apart from their final reports, their previous publications on related topics, as well as their underlying laboratory/bench notes and substantive emails, memoranda, etc., in this case, may be subject to disclosure to the defence and part of examination at trial.
To prepare for trial, the prosecutor should meet with the experts early and often to determine their level of familiarity with court proceedings and their ability to convey technical information to a lay audience. A thorough review of the evidence with the experts should be conducted well in advance of any court proceedings to ensure that the experts clearly understand their role and that their presentation is understandable to the audience. They should be as straightforward as possible, but without being condescending. Although the most effective expert trial presentations do not appear rehearsed or stilted, the prosecutor and expert witness should thoroughly review (as often as needed) the expected order of testimony, the areas covered, and perhaps provide examples of the types of questions that may be used. In this way, experts may achieve a comfort level with their role in the case and provide maximum assistance to the judge or jury. Of course, experts should always provide their independent views and not modify their opinions to further one party’s interests.
Whether the formal report itself is admitted as documentary evidence and becomes part of the public record may vary among jurisdictions. If aspects of the technical evidence can be shown to the finder of fact but not to the observers in the courtroom gallery, the expert must be clearly instructed as to how to handle related physical evidence such as photos and documents. During the presentation of the expert’s testimony, the prosecutor must continuously monitor the testimony and be prepared to limit a question or answer if the expert strays into an impermissible area.
The testimonial presentation of a forensics expert may include an attribution portion. That is, the expert may directly assist the finder of fact by providing an opinion linking radiation-contaminated pieces of evidence with a source device or material connected to
the defendant or particular locations. Given the hazardous nature of the actual physical pieces of evidence, prosecutors may need to rely on demonstrative exhibits (models, photographs, videos, diagrams, etc.) or illustrative aids (a similar object rendered harmless) to persuade the finder of fact that the evidence or device at issue is what the prosecuting authority claims it to be and, if applicable, how it functions. The bases for these opinions are subject to discovery and cross-examination, so the expert must be careful not to form an opinion on restricted information that cannot be publicly disclosed. If the prosecution is relying upon information provided by a foreign partner, prior agreement from that partner for use of that information at trial should be obtained as early as possible. Because the topic of attribution is often critical to establishing a defendant’s guilt, the likelihood of a ‘battle of the experts’ increases with the inclusion of this testimony. A defence expert will frequently dispute the validity of the methods and opinions of the key findings of this topic in the forensic report.
Attribution testimony may be critical to identifying those responsible for the attack or release of radioactive material. This is also an area in which experts may be vulnerable to cross-examination on the reliability or bases of their opinions. Expert witnesses related to RN materials must generally be prepared for various lines of potential cross-examination:
• Lack of prior experience or qualifications: because crimes involving RN material are infrequent, experts may face challenges due to a lack of prior experience analysing similar evidence. Similarly, the accreditation (or absence thereof) of the testing laboratory may be questioned.
Prosecutors should prepare witnesses to explain how their background experiences in related areas or training exercises provide a reliable basis for conducting the analysis in the present situation and how the testing facility adheres to widely accepted laboratory protocols.
• Opinions affected by evidence mishandling: in formulating their final opinions, experts should have considered what, if any, irregularities in the handling of the evidential materials or gaps in testing may impact the validity of their results. For example, improper or inconsistent procedures in the soil sampling of potentially radioactive material could allow a defence attorney to cast doubt on the ultimate expert conclusions. Defence counsel may suggest that previous unrelated episodes of evidence mishandling by laboratory personnel should diminish the reliability of the procedures utilised in the case at hand.
• Bias or motive: forensic experts in general are often criticised by defence lawyers as having biases towards, or incentives from (either in compensation or research funding) the requesting government agents or prosecutors that affect the reliability of the opinions they provide. A non-governmental expert should also be queried about any financial interest in the outcome of the litigation (e.g., ownership of stock securities in the company that made the radiological device at issue). Any information showing favouritism (e.g., the expert has testified in dozens of cases and has always provided favourable testimony only to the government) may become a topic of crossexamination.

• Prior inconsistent opinions: experts may be queried about any methods or opinions offered in the present case that arguably are inconsistent with their prior writings, research or testimony, as well as principles set forth in learned treatises of their field.
• Novel, unverified methodologies: related to undermining an expert’s qualifications, the defence may challenge expert testimony by questioning the reliability of any novel methodologies or scientific principles the expert employed to study the evidence and formulate the final opinions. In determining whether to accept such testimony, the judge or jury may consider whether the method or principle is generally accepted in the relevant scientific field, the rate of error or statistical confidence in the theory or method and whether the method or principle has been the subject of a peer-reviewed scientific journal.
At the post-conviction stage of a criminal proceeding, an RN case presents challenges distinct from more common prosecutions. Some of the risks associated with the improper disclosure of sensitive information (such as harm to confidential informants or providing a road map for would-be copycats) could continue and will require a disciplined media plan and maintenance of judicially-obtained protective orders. Moreover, if a defendant has obtained sensitive technical information about an RN release, restrictions on the defendant’s interaction with the media or the public may be advisable during the appeal and any subsequent period of incarceration. These restrictions may necessitate a judicial order to the penal authority where the defendant is incarcerated.
As with any criminal case, the sentence imposed following a guilty verdict in an RN case may reflect many considerations: the element of proportionality (i.e. a reflection of the seriousness of the offence), the need for general and specific deterrence, any mitigating evidence lessening the severity of the criminal conduct, the defendant’s prior criminal history (if any), the impact of the crime on the affected community or specific victims, and avoidance of disparities in sentences among those convicted of similar conduct. Apart from the evidence introduced at trial, additional information may be presented during a sentencing hearing and the need for additional expert testimony may arise. In an RN case, for example, evidence related to environmental clean-up costs or victim impact statements, which were not directly relevant during the trial on the merits, may be provided to the sentencing
authority. Whether individual victims are entitled to compensatory costs or restitution is another issue that can arise. Finally, whether the crime created a risk of widespread personal harm or contamination or was motivated by the support of a terrorist group will likely constitute aggravating factors and a greater sentence.
Whether an appeal is initiated by the prosecuting authority (in those systems that allow appeals of acquittals) or by the defendant, the scope of the appeal will depend on the specific issues subject to review. In some appellate courts, such as appeals to the US Supreme Court, the review is limited to questions of law. In a few jurisdictions, the original charges may be modified during an appeal. In contrast, in others, the review may be fully de novo regarding the facts and the law. Accordingly, a nuclear forensics expert could be required to provide testimony again at the appellate stage. From the outset of the case, the expert should be informed that their role and assistance may continue through the trial and into the appellate stage. Additional experts may be appointed during the appellate process and further investigation by the police may occur. The previous guidance regarding the most effective presentation of such evidence will largely still apply.
The trial evidence typically must be preserved for the duration of the appeal (including any final review by a national supreme court), and certain complications may arise when it includes RN material. First, the continued safe storage of contaminated evidence may be costly and be restricted to facilities geographically distant from the appellate court. Consequently, as with the trial court, the appellate tribunal will not easily be able to inspect some of the evidence that constitutes the corpus delicti (the body of evidence that constitutes the offence). Nonetheless, because a new defence team may be appointed for the appeal, a protocol
for maintaining the evidence and allowing its review must be developed. In contrast to other types of physical evidence, radiological samples may inherently change over time because their half-lives result in alterations to their chemical compositions. Accordingly, a new defence team that retains an expert to examine the evidence years after the original trial may encounter samples that have naturally changed and become less radioactive (and correspondingly less harmful). Finally, if RN material was illicitly obtained from a commercial or private laboratory, those entities may seek the return of the material at the earliest opportunity to mitigate an interruption of their normal operations and the related commercial losses.
Because the appellate process may span several years, the prosecuting authorities must create a flexible plan with the appellate court to preserve the trial evidence pursuant to the governing legal authorities to ensure fairness and justice of the proceedings for all the parties involved. Given the extended duration and complexity of these cases, the prosecution team must maintain an ‘institutional memory’ so that even if the original prosecutors are no longer in government service, their successors are informed of the critical decisions and actions taken during the original trial proceedings. Including an appellate attorney on the prosecution team during the trial stage is often advisable.
Case Title:
United States v. Crawford, 714 Fed. Appx. 27 (2nd Cir. 2017)
Date of Investigation:
August 2015 Trial
Level:
National/Federal
Country of Origin: United States
Region/State: New York
Case Category: RADIOLOGICAL/ X-RAY
Incident Summary:
• Defendant sought to obtain a portable industrial X-ray machine to use as a covert weapon against Muslims and certain political leaders he regarded as ideological enemies. Working with an accomplice, he modified the machine with a remote initiation device so that he and the accomplice would remain unharmed, while the machine, hidden in a truck or van, emitted lethal doses of radiation to nearby unsuspecting victims.
• The defendant had gained an understanding of the machine’s lethality from his career as an industrial mechanic for a large manufacturing company.
• The defendant researched the varying capabilities of different types of X-ray machines and their potential misuse and lethality. He sought funding for his scheme and provided parts lists and diagrams to facilitate the construction of the modified device.
• The defendant was convicted after trial of attempting to acquire a radiological dispersal device, conspiracy to use a WMD and distributing information regarding a WMD in furtherance of a crime of violence.
• A citizen’s tip alerted law enforcement to the defendant’s initial efforts to obtain funding for his plot triggered an investigation. Law enforcement immediately began working with prosecutors to create a plausible and legally sound undercover operation.
• An FBI special agent posed as a sympathetic seller of the commercial X-ray machine, aligning with the defendant’s ideological motivations.
• The X-ray machine, borrowed from another government facility, had been rendered safe (i.e., incapable of emitting radiation) before being transferred to the defendant.
• Pursuant to a court-authorised wiretap, law enforcement agents were able to record the defendant and his accomplice developing their scheme.
• In the culmination of the investigation, the defendant was permitted to assemble the device and confirm that his remote initiation system was operable.
• The defendant accepted delivery of the X-ray machine, tested it and assisted with its deployment.
• Two experts in nuclear physics and nuclear medicine testified at trial regarding the functioning of the X-ray machine and its potential adverse health effects on humans.
• Disrupt a plot to misuse a legitimate radiation-emitting device as a weapon for a terrorist act.
• Gather and admit to the jury corroborating evidence of the defendant’s scheme while avoiding any basis for a claim of entrapment (improper use of an agent provocateur).
• Educate the jury through expert testimony on the basics of radiation and how the device in question could be transformed into a weapon.
• Not applicable in this case, as the X-ray machine was rendered safe and remained under the supervision of special agents.
• Establish that the criminal statute, primarily focused on prohibiting ‘dirty bombs,’ also encompassed the use of an illicit X-ray device.
• Overcome a defence entrapment argument that the scheme was too unrealistic, and the defendants would not have participated but-for the role of the undercover agents.
• Create a realistic and safe undercover scenario in which the defendant could demonstrate his criminal plan. The defendant built the initiation component, adapted it to the X-ray machine and completed assembly of the improvised weapon without harming himself, the undercover law enforcement officers or the public.
• Educate the jury about the improvised weapon, which could not feasibly be constructed in the courtroom due to space and safety considerations.
• A person seeking to exploit his specialised knowledge of X-ray technology to harm others was apprehended before his terrorist scheme led to an innocent person’s death or injury.
• The defendant was convicted after trial and sentenced to 30 years in prison. His conviction and sentence were affirmed on appeal.
• The successful prosecution illustrates how legitimate commercial devices involving radiological components may be misused for criminal or terrorist ends.

CHAPTER 10


The European Union Agency for Law Enforcement Cooperation (Europol)
The European Union (EU)
International Association of Prosecutors (IAP)
International Atomic Energy Agency (IAEA)
International Maritime Organization (IMO)
Nuclear Forensics International Technical Working Group (ITWG)
European Commission Joint Research Centre (JRC)
Nuclear Threat Initiative (NTI)
United Nations Interregional Crime and Justice Research Institute (UNICRI)
United Nations Office on Drugs and Crime (UNODC), Terrorism Prevention Branch (TPB),Chemical, Biological, Radiological and Nuclear (CBRN) Terrorism Prevention Programme
The challenges posed to the inter-ministerial community of a state by the malicious use of RN materials are extensive and complex. The following regional and international organisations may be contacted for support in both the pre-planning and operational phases of prosecuting criminals for the unlawful use of nuclear and other radiological materials outside of regulatory control.
General Description/Mandate
The general mandate of Europol encompasses the following key areas: operational support, analysis and intelligence, strategic support and coordination, threat assessment and early warning, and international cooperation.
Capabilities in Supporting Countries with the Investigation, Prosecution and Adjudication of RN Crimes
Europol assists EU Member States and partners in gathering and analysing intelligence related to radiological and nuclear crimes, identifying patterns and providing strategic support to investigations. It also assists in the coordination of cross-border operations, facilitates the sharing of best practices and supports the development of specialised training programmes.
Contacts
Eisenhowerlaan 73, 2517 KK The Hague, The Netherlands.
Telephone: +31 70 302 5000
Website https://www.europol.europa.eu
General Description/Mandate
The EU Chemical, Biological, Radiological and Nuclear (CBRN) Risk Mitigation Centres of Excellence (CoE) is a global Initiative funded by the EU as part of its goal to promote peace, stability and conflict prevention. It is implemented jointly with UNICRI. The aim of the Initiative is to mitigate risks and strengthen an all-hazards security governance in 64 Partner Countries following a voluntary and demand-driven approach.
Capabilities in Supporting Countries with the Investigation, Prosecution and Adjudication of RN Crimes
A series of Prosecutor’s Guidebooks on CBRN Crimes offers prosecutors, law enforcement and judicial authorities guidance to support the successful investigation, prosecution and adjudication of incidents involving the deliberate acquisition, stockpiling, production, transfers, use or misuse of CBRN materials. Additionally, a dedicated capacity-building and training package has been developed and is currently being implemented to integrate these guidance manuals into the professional responsibilities of prosecution and judicial agencies.
Contacts
Telephone: 00 800 67 89 10 11
Website
https://cbrn-risk-mitigation.network.europa.eu/eu-cbrn-centres-excellence_en
General Description/Mandate
The IAP is the only worldwide network of prosecutors. The IAP is committed to setting and raising standards of professional conduct and ethics for prosecutors worldwide, as well as to promoting the rule of law, fairness, impartiality and respect for human rights. The IAP is also committed to improving international cooperation to combat transnational, organised and serious crime.
Capabilities in Supporting Countries with the Investigation, Prosecution and Adjudication of RN Crimes
Facilitating communication between prosecution authorities to share best practices and enable prosecutors to progress operational casework through direct contact with their appropriate counterparts.
Contacts
sg@iap-association.org
Website
https://www.iap-association.org/
General Description/Mandate
The IAEA is mandated to accelerate and expand the contribution of atomic energy in promoting peace, health and prosperity globally. Its staff strives to ensure that assistance provided, either directly, or under its supervision or control, is not used in such a way as to further any offensive military operations. The agency aims to encourage and assist research, development and practical application of atomic energy for peaceful uses. Additionally, it fosters the exchange of scientific and technical information related to the peaceful use of atomic energy.
The IAEA supports Member States in capacity building regarding radiological crime scene management and nuclear forensics at national, regional and international levels. This support includes providing guidance, conducting training courses, workshops and expert missions, offering advisory services and coordinating research projects in these areas. The agency also plays a role in organising international events such as conferences and technical meetings, serving as forums to exchange good practices, discuss scientific developments and foster international cooperation.
Vienna International Centre, PO Box 100, 1400 Vienna, Austria
Tel: (+43-1) 2600-0
Website https://www.iaea.org/
General Description/Mandate
Protocol of 2005 to the Convention for the Suppression of Unlawful Acts Against the Safety of Maritime Navigation (SUA)
Protocol of 2005 to the Protocol for the Suppression of Unlawful Acts against the Safety of Fixed Platforms Located on the Continental Shelf (which contains similar provisions as the 2005 SUA Protocol, relating to unlawful acts against fixed platforms located on the continental shelf).
The 2005 SUA Protocols enhance the provisions of the 1988 Convention for the Suppression of Unlawful Acts Against the Safety of Maritime Navigation, and the 1988 Protocol related to unlawful acts against fixed platforms located on the continental shelf. These protocols establish an international legal framework for criminalising certain terrorist acts and fostering cooperation
among States Parties in the prevention, investigation, and prosecution of suspected offenses outlined in the Protocols.
The 2005 SUA Protocols include a substantial broadening of the range of offences: including, for example, the use of a ship in a manner that causes death or serious injury or damage, the transport of terrorists in order to evade criminal prosecution, or the unauthorised maritime transport of weapons of mass destruction. It is the first international instrument to address certain types of terrorism at sea and the illicit transport on board of ships of weapons of mass destruction, including nuclear or other radioactive material, and relevant equipment, materials and technology.
The 2005 SUA Protocols are aligned with UNSC resolution 1540 (2004), which defines for the purpose of the resolution ‘related materials’ as materials, equipment and technology covered by relevant multilateral treaties and arrangements or included on national control lists, which could be used for the design, development, production or use of nuclear, chemical and biological weapons and their means of delivery. The 2005 SUA Protocols require States Parties to undertake measures that also align with the resolution, for example, the establishment and maintenance of robust border controls and the implementation of effective national controls over exports and trans-shipments.
The 2005 SUA Protocol also introduces provisions on procedures between States Parties for the boarding of vessels suspected of being involved in terrorist activities.
Contacts
International Maritime Organization (IMO) 4 Albert Embankment, London SE1 7SR, United Kingdom.
Tel: +44 (0) 20 7735 7611
Email: info@imo.org
Website www.imo.org
The objective of the ITWG is to advance the scientific discipline of nuclear forensics and to provide a common approach and effective technical solutions to competent national or international authorities that request assistance. Since its inception in 1995 the ITWG has been focused on nuclear forensic best practice through the development of techniques and methods for forensic analysis of nuclear, other radioactive, and radiologically contaminated materials.
Nuclear forensics is an essential component of national and international nuclear security response plans to events involving radioactive materials diverted outside of regulatory control. The ability to collect and preserve radiological and associated evidence as material is interdicted and conduct nuclear forensics analysis provides insights to the history and origin of nuclear material, the point of diversion, and the identity of the perpetrators. The ITWG disseminates recent progress in nuclear forensic analysis and interpretation with the broader community of technical and security professionals who can benefit from these advancements. As a technical working group, the priorities for the ITWG include identifying requirements for nuclear forensic applications, evaluating present nuclear forensic capabilities, and recommending cooperative measures that ensure all States can respond to acts involving illicit trafficking and unauthorised possession of nuclear or other radioactive materials. To help strengthen national nuclear forensics capabilities, ITWG conducts exercises, develops guidelines, and publishes a quarterly newsletter. ITWG has conducted seven collaborative materials exercises in which labs have an opportunity to apply forensic techniques to radiological materials in the context of a nuclear smuggling scenario. ITWG also has conducted five national nuclear forensics library exercises to better socialise and identify best practices for this emerging tool.
ITWG co-chairs
Website
http://www.nf-itwg.org/
The The Joint Research Centre (JRC) of the European Commission provides independent, evidence-based knowledge and science, supporting EU policies to positively impact society. As a department of the European Commission, the JRC plays a key role at multiple stages of the policy cycle. It works closely with research and policy organisations in the Member States, with the European agencies, and with scientific partners in Europe and internationally, including within the United Nations system. It also cooperates with EU institutions, notably the European Parliament. Originally established under the Euratom Treaty, the JRC’s focus has expanded significantly over time. While a proportion of its work continues to be in the nuclear field, the JRC now offers scientific expertise and competences from a very wide range of scientific disciplines in support of almost all EU policy areas. The JRC is funded by the EU’s framework programme for research and innovation – currently Horizon Europe – and the Euratom research and training programme. Further income is generated through additional work for European Commission services and, to a far lesser extent, contract work for third parties. Specific funding is also made available to the JRC under the nuclear waste management and decommissioning programme.
Additionally, The European Nuclear Security Training Centre (EUSECTRA) was specifically established to address concerns of theft of radioactive materials that could then be associated with crime and acts of terrorism. These concerns, from the wide-
spread use of radioactive materials for medical and industrial applications are acknowledged by the international community in numerous international commitments and resolutions.
Capabilities in Supporting Countries with the Investigation, Prosecution and Adjudication of RN Crimes
The collaboration with national authorities (such as law enforcement, regulatory and radiation protection bodies) and international organisations (such as the IAEA, Europol) is fundamental for developing a comprehensive response plan for incidents of illicit trafficking. Investigations of characteristic parameters, i.e. information inherent to the material, are done for forensic purposes and in support of nuclear safeguards. The JRC develops specific measurement methods and data interpretation techniques encompassing appropriate training activities.
Contacts
Rue du Champ de Mars 21, 1050 Brussels, Belgium.
Website https://joint-research-centre.ec.europa.eu/index_en
General Description/Mandate
The NTI is a nonprofit, nonpartisan global security organisation focused on reducing nuclear and biological threats imperiling humanity. NTI establishes practical solutions to strengthen nuclear security by convening leaders, developing actionable recommendations, and tracking progress on commitments.
Capabilities in Supporting Countries with the Investigation, Prosecution and Adjudication of RN Crimes
The NTI works to strengthen global nuclear security and verifiably prevent the proliferation of nuclear materials that could be used
to create nuclear weapons. The program collaborates closely with governments, international organisations, industry, and non-governmental organisations to fortify security for nuclear materials or eliminate materials where possible. The NTI Nuclear Security Index evaluates nuclear security conditions in 175 countries and Taiwan. NTI’s website provides information on treaties, organisations, and regimes relating to nuclear security, including the amended Convention on Physical Protection of Nuclear Materials and Facilities and the International Convention for the Suppression of Acts of Nuclear Terrorism.
Contacts
Scott Roecker, Vice President, Nuclear Materials Security
Roecker@nti.org
+1-202-296-4810
1776 Eye Street, NW. Suite 600, Washington, DC 20006.
Website https://www.nti.org/area/nuclear/
General Description/Mandate
UNICRI is mandated to assist inter-governmental, governmental and non-governmental organisations in developing and implementing improved policies in the fields of crime prevention and justice. It acts with its partners to facilitate international law enforcement cooperation and judicial assistance, upholds the respect of international instruments and standards, advances understanding of crime-related issues, and promotes just and efficient criminal justice systems.
UNICRI focuses on specialised niches and specific areas related to crime prevention, criminal justice, security governance, counter-terrorism and the risks and benefits of technological advances.
UNICRI addresses crime and justice issues within broader policies for socio-economic change and development, and the protection of human rights.
UNICRI supports Members States in mitigating risks associated with the unlawful uses of CBRN materials and technological advances (including CBRN proliferation financing risks, response to CBRN incidents, CBRN disinformation, CB terrorism, and preventing and deterring RN trafficking). Within the framework of the EU CBRN Centres of Excellence Initiative, UNICRI ensures coherent and effective national, regional and international cooperation. The Institute extensively contributes to enhancing the capacity building and knowledge of criminal justice personnel and law enforcement to address CBRN-related issues.
UNICRI has co-sponsored the following publications: IAEA NSS publication No. 47-T: Detection in a State’s Interior of Nuclear and Other Radioactive Material out of Regulatory Control; IAEA NSS No. 44-T: Detection at State Borders of Nuclear and Other Radioactive Material out of Regulatory Control. UNICRI also supports Member States in improving security at major events, protecting crowded spaces and vulnerable targets (including infrastructure and tourism venues), ensuring tourism security, improving community resilience to violent extremism and terrorism, and enhancing cyber security. To attain these objectives and address the evolving array of traditional and emerging threats, UNICRI adopts a multi-sectoral and holistic approach, incorporating applied and action-oriented research, exchange and dissemination of knowledge, advocacy, training, field activities, and the establishment of strong partnerships as integral components of its strategy.
Contacts
Viale Maestri del Lavoro, 10
10127 Turin, Italy
Tel.: (+39) 011 6537 111
Fax: (+39) 011 6313 368
Email: unicri.publicinfo@un.org
Website
http://www.unicri.org
https://unicri.it/threat-response-and-risk-mitigation-security-governance
United Nations Office on Drugs and Crime (UNODC), Terrorism Prevention Branch (TPB), Chemical, Biological, Radiological and Nuclear (CBRN) Terrorism
General Description/Mandate
UNODC’s mission is to contribute to global peace and security, human rights and development by making the world safer from drugs, crime, corruption and terrorism.
Within UNODC/TPB, the CBRN Terrorism Prevention Programme promotes the universalisation and effective implementation of seven international legal instruments on countering nuclear and radiological terrorism: (1980 Convention on the Physical Protection of Nuclear Material; 1997 International Convention for the Suppression of Terrorist Bombings; 2005 International Convention for the Suppression of Acts of Nuclear Terrorism (ICSANT); 2005 Amendment to the Convention on the Physical Protection of Nuclear Material; 2005 Protocol to the Convention for the Suppression of Unlawful Acts against the Safety of Maritime Navigation; 2005 Protocol to the Protocol for the Suppression of Unlawful Acts against the Safety of Fixed Platforms located on the Continental Shelf; and 2010 Convention on the Suppression of Unlawful Acts relating to International Civil Aviation) through the delivery of technical and legal assistance, in line with the mandate conferred to UNODC by the UN General Assembly.
UNODC staff assists Member States to incorporate these instruments’ provisions into their national legislation and build the capacity of their criminal justice systems to implement those provisions effectively, in accordance with the rule of law and with
due respect for human rights. Over the past two decades, UNODC has organised numerous training events to promote adherence to, and effective implementation of, the international legal framework including against radiological and nuclear terrorism.
In addition to promoting the universalisation and effective legislative implementation of key instruments, UNODC works to ensure criminal justice officials have the training needed to properly investigate, prosecute and adjudicate terrorism and other criminal offences involving nuclear or other radioactive material. The CBRN Terrorism Prevention Programme multilingual team comprises staff specialised in nuclear law, with ample experience in delivering assistance for the effective implementation of the international legal framework against nuclear terrorism.
During the period 2023-2026, with the support of EU funding, UNODC is conducting national seminars at judicial training schools. These seminars aim to train the newest generations of judges and prosecutors, providing them with insights into the complexities and challenges associated with cases involving nuclear or other radioactive material. As part of the project, UNODC is providing legislative assistance to give effect to the ICSANT provisions and enable application of the law by prosecutors. Furthermore, UNODC is developing toolkits covering different aspects of ICSANT relevant for prosecutors (e.g., jurisdiction, human rights, seizure and protection of material out of regulatory control and international cooperation).
In 2017, UNODC, through the Global Initiative to Combat Nuclear Terrorism and in partnership with Canada, co-authored the Vigilant Marmot Training Guide. This guide addresses challenges related to adopting or updating national legal frameworks for nuclear security, highlighted obligations under international legal instruments against nuclear terrorism. UNODC translated the training guide into other UN official languages and conducted sessions on it in approximately ten events.
UNODC staff and international experts, with the financial and in-kind support of the Government of Canada, have developed a mock trial scenario on ICSANT through several expert group meetings. This scenario will be used to conduct six regional mock-trials in various UN official languages during the period 2024-2026. A pilot event featuring a criminal investigation and mock trial training exercise on the International Convention for the Suppression of Acts of Nuclear Terrorism (ICSANT) was held in 2022.
In 2023, UNODC held a regional workshop on the effective implementation of ICSANT for South-Eastern European countries. The workshop included sessions focusing – inter alia - on radiological crime scene management, nuclear forensics, evidence preservation and admissibility, and inter-agency coordination. It also showcased the benefits of ICSANT in facilitating international cooperation in cases related to radiological or nuclear terrorism, including exchange of information, prosecution, and extradition.
UNODC has developed a module on The International Legal Framework against Chemical, Biological, Radiological and Nuclear Terrorism, which provides a thorough examination of the international legal instruments that the international community has developed to prevent and suppress acts of CBRN terrorism, including ICSANT.
UNODC has also produced two eLearning modules on the international legal framework against CBRN legal terrorism and ICSANT which are useful for criminal justice officials, as in addition to covering the conventions they also discuss several key areas including jurisdiction, mutual legal assistance, extradition and criminalisation requirements.
Other UNODC publications and tools which may be of interest to prosecutors include: International Cooperation in Criminal Matters: Counter-terrorism, Manual on Mutual Legal Assistance (MLA) and Extradition, Practical Guide for Requesting Electronic Evidence across Borders and MLA Request Writer Tool.
Additionally, UNODC has co-sponsored the following IAEA publications:
• NSS No. 15: Nuclear Security Recommendations on Nuclear and Other Radioactive Material out of Regulatory Control
• NSS No. 44-T: Detection at State Borders of Nuclear and Other Radioactive Material out of Regulatory Control
Contacts
Vienna International Centre Wagramer Strasse 5. A 1400 Vienna, Austria
Tel: + (43) (1) 26060
Email: UNODC-ICSANT@un.org
Website https://www.unodc.org/icsant/

Photographies
© Adobe Stock
(images on pages
18, 21, 74, 75, 133, 160, 186, 187, 236, 237, 253, 284, 285, 306, 307, 323, 330, 332)
© Unsplash
(Image on page 102
Photo by David von Diemar on Unsplash)
Design
Marianna Fassio | UNICRI
Layout
Jasmine Massoumi
©2024 UNICRI
